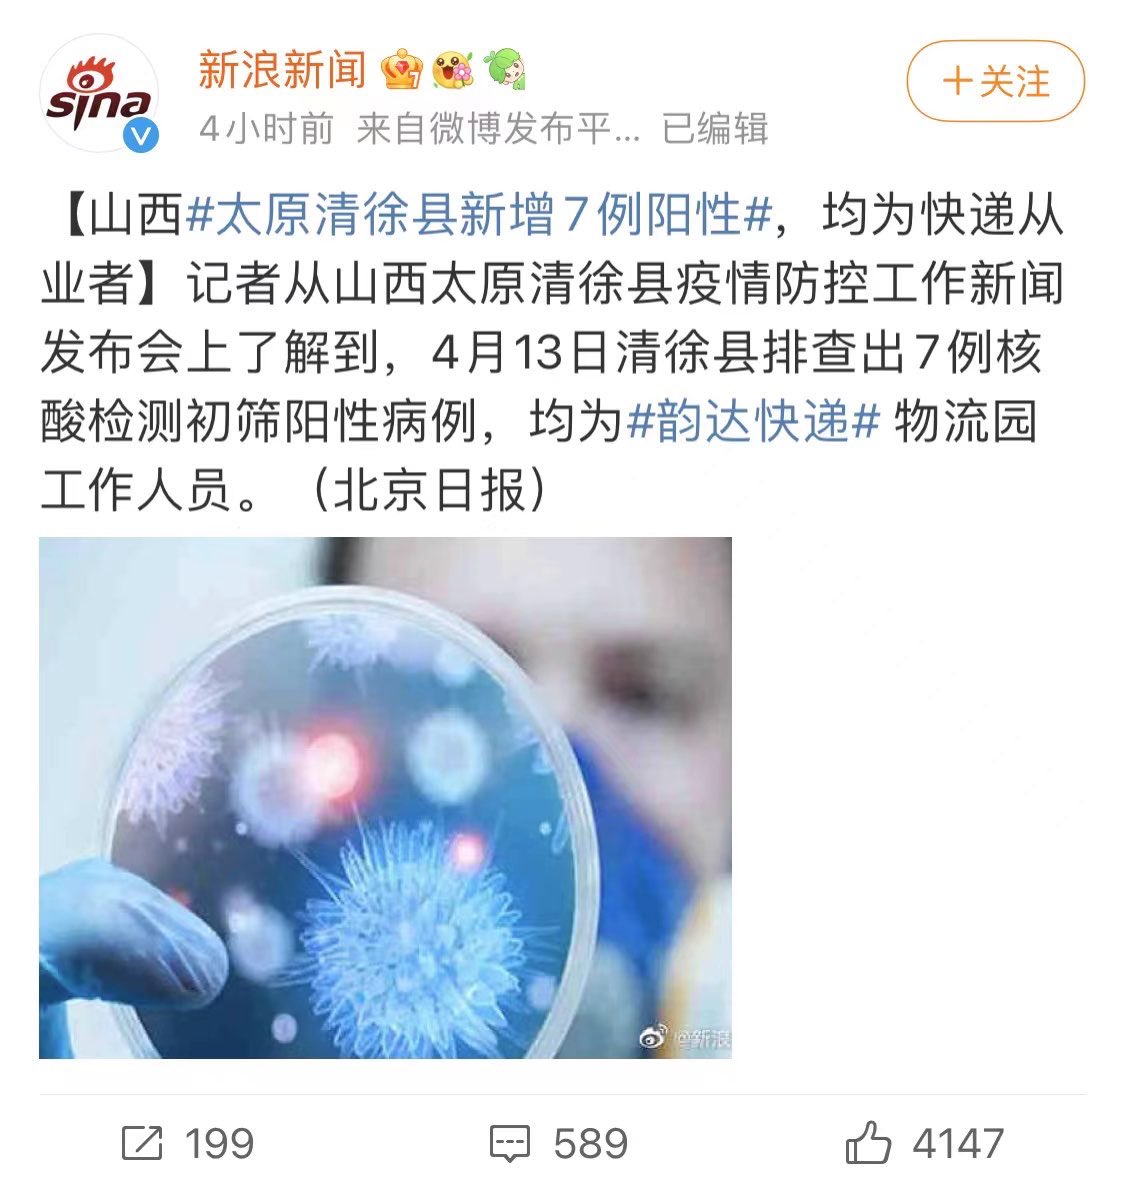

#上海封城 上海分兩區封控搶菜潮再現 形同封城民情沸騰 | 兩岸 | 中央社 CNA
上海分兩區封控搶菜潮再現 形同封城民情沸騰 | 兩岸 | 中央社 CNA Inty热点新闻 (@__Inty__) on X据中央社报道, #上海 多家超市星期天晚间出现抢购人潮,很多人对重回 #封城 模式感到失望,有部分居民聚集抗议要求解封。
Inty热点新闻 (@__Inty__) on X据中央社报道, #上海 多家超市星期天晚间出现抢购人潮,很多人对重回 #封城 模式感到失望,有部分居民聚集抗议要求解封。
报道称,上海99%的阳性病例都是 #无症状感染者 。从20到26日,阳性病例数从700余例到2600余例,已经有超过1万名感染者。 上海出台分区封城 超市出现抢购人潮#中國武漢肺炎病毒 #隔離集中營 #中國日常
上海出台分区封城 超市出现抢购人潮#中國武漢肺炎病毒 #隔離集中營 #中國日常
 上海分兩區封控搶菜潮再現 形同封城民情沸騰 | 兩岸 | 中央社 CNA
上海分兩區封控搶菜潮再現 形同封城民情沸騰 | 兩岸 | 中央社 CNA Inty热点新闻 (@__Inty__) on X据中央社报道, #上海 多家超市星期天晚间出现抢购人潮,很多人对重回 #封城 模式感到失望,有部分居民聚集抗议要求解封。
Inty热点新闻 (@__Inty__) on X据中央社报道, #上海 多家超市星期天晚间出现抢购人潮,很多人对重回 #封城 模式感到失望,有部分居民聚集抗议要求解封。报道称,上海99%的阳性病例都是 #无症状感染者 。从20到26日,阳性病例数从700余例到2600余例,已经有超过1万名感染者。
 上海出台分区封城 超市出现抢购人潮#中國武漢肺炎病毒 #隔離集中營 #中國日常
上海出台分区封城 超市出现抢购人潮#中國武漢肺炎病毒 #隔離集中營 #中國日常 
 Inty on Twitter中国素质最好的城市,上海,防疫隔离“集中营”现场
Inty on Twitter中国素质最好的城市,上海,防疫隔离“集中营”现场(有廁所影片,大便沒沖,慎點)
 超大型新人 on Twitter正常發揮:以往去了那麼多國際機場,真的就只有中國的機場廁所是臭的⋯⋯從洗手台就濃濃惡臭
超大型新人 on Twitter正常發揮:以往去了那麼多國際機場,真的就只有中國的機場廁所是臭的⋯⋯從洗手台就濃濃惡臭 Inty on Twitter习近平厕所思想执导过,所以。。。
Inty on Twitter习近平厕所思想执导过,所以。。。 Inty on Twitter上海防疫‘集中营’正式投入使用。 上海要开始反人类防疫了。
Inty on Twitter上海防疫‘集中营’正式投入使用。 上海要开始反人类防疫了。(小粉紅們一定好開心啊,天線寶寶扭)
 Inty on Twitter习近平有个偷窥私人隐私的癖好:他经常去私人的家里,先看别人的厕所,然后掀别人的锅。。。
Inty on Twitter习近平有个偷窥私人隐私的癖好:他经常去私人的家里,先看别人的厕所,然后掀别人的锅。。。 Inty on Twitter习近平 厕所革命,厕所思想。
Inty on Twitter习近平 厕所革命,厕所思想。 不是我说的,是习近平本人和中国喉舌 新华社说的
 Inty on Twitter上海防疫集中营,你不得病也得让你密集接触感染。😂
Inty on Twitter上海防疫集中营,你不得病也得让你密集接触感染。😂
 eric ccc on Twitter實際上,這種隔離場所排風互交系統很好而且這裏隔離的基本上是無症狀感染者而已。你們這群人除了嘲笑造謠之外真沒什麼好玩的。
eric ccc on Twitter實際上,這種隔離場所排風互交系統很好而且這裏隔離的基本上是無症狀感染者而已。你們這群人除了嘲笑造謠之外真沒什麼好玩的。 Inty on Twitter你们这些五毛粉红蛆不知道,在违反你的自由意志下,非法把你关到中南海隔离,跟着习包子吃满汉全席,也是集中营。
Inty on Twitter你们这些五毛粉红蛆不知道,在违反你的自由意志下,非法把你关到中南海隔离,跟着习包子吃满汉全席,也是集中营。 大陆集中隔离全部是非法关押,剥夺人身自由
 Inty on Twitter大陆反讽【中国反人类防疫】😂
Inty on Twitter大陆反讽【中国反人类防疫】😂
 Inty on Twitter
Inty on Twitter 自由亚洲电台 on Twitter【上海小粉红大闹外国人聚集的餐馆】
自由亚洲电台 on Twitter【上海小粉红大闹外国人聚集的餐馆】3月26日晚,有小粉红冲进上海永康路一家餐馆内捣乱,他声称不满在上海的外国人可以自由饮酒作乐群聚,但普通上海市民却要忍受封区之苦。
#上海
#封城
#洋人
#仇外
#小粉红
去跟中共講啊XD
 Inty on Twitter回忆一个10来年前的故事:
Inty on Twitter回忆一个10来年前的故事:当年我上大学的时候,去外面实习打工,中国人的公司歧视我,不要我;但是一家很小的美国公司不看民族成分,要了我,我帮这家公司卖命地做销售,经常去永康路厚着脸皮找各个酒吧餐厅的经理推销美国产的苹果酒。😂 这条街太熟悉了,后面我去这条街都免费喝酒。
 GoBlue on Twitter等等,那为啥老外不用封?特权?
GoBlue on Twitter等等,那为啥老外不用封?特权? HongKongPeople on Twitter愛國就要守法,別問那麼多.
HongKongPeople on Twitter愛國就要守法,別問那麼多.(XDDDDDDDDD)
 Inty on Twitter上海是中国大外宣的门面城市,还有上海法租界周遭地区有大量的外交使领馆。这里本来就是有中国人和狗不得入内的习俗。 此刻是中国欺骗世界的一个窗口城市,所以老外一般有特权,尤其是是白人老外 。
Inty on Twitter上海是中国大外宣的门面城市,还有上海法租界周遭地区有大量的外交使领馆。这里本来就是有中国人和狗不得入内的习俗。 此刻是中国欺骗世界的一个窗口城市,所以老外一般有特权,尤其是是白人老外 。 Inty on Twitter我在上海呆了十年。由于上面说到的歧视问题,我大部分时间就是跟在上海的老外一起工作生活的,我前前后后交往过数以千计的在上海的外国人。 更奇葩的一次是居然有一次突然进入到美国领馆的海军陆战队安保人员的宿舍一起party。 他们非工作时间可以邀请外人进入他们的宿舍。
Inty on Twitter我在上海呆了十年。由于上面说到的歧视问题,我大部分时间就是跟在上海的老外一起工作生活的,我前前后后交往过数以千计的在上海的外国人。 更奇葩的一次是居然有一次突然进入到美国领馆的海军陆战队安保人员的宿舍一起party。 他们非工作时间可以邀请外人进入他们的宿舍。
 Inty on Twitter在老外群体里,最看不起中国人的是俄罗斯和东欧前苏联国家的老外。 Kitay Bilet 天天骂。 接下来看不起中国人是在中国的非洲人和中东人。
Inty on Twitter在老外群体里,最看不起中国人的是俄罗斯和东欧前苏联国家的老外。 Kitay Bilet 天天骂。 接下来看不起中国人是在中国的非洲人和中东人。 Inty on Twitter上是我在上海的时候跟数千老外交往后的心得体会,不是科学统计。
Inty on Twitter上是我在上海的时候跟数千老外交往后的心得体会,不是科学统计。 Inty on Twitter当年我实习的一个在上海卖酒的美国小公司,就这么多员工,老板是美国人。 我把同事们的脸挡住了,就留了个小时候的我。
Inty on Twitter当年我实习的一个在上海卖酒的美国小公司,就这么多员工,老板是美国人。 我把同事们的脸挡住了,就留了个小时候的我。
【上海突襲式封城❗ 民眾恐荒搶物資】此前才宣布「不會也不必」封城的上海市政府「精準防疫」破功,27日晚間突然宣布28日起分兩批封控。有2,400多萬人口的超大型城市上海,疫情一發不可收拾,已外溢至中國21個省、71個市。
 上海「切塊式封城」 中共防疫模式陷危機 - 大紀元
上海「切塊式封城」 中共防疫模式陷危機 - 大紀元
小粉紅們一定很開心對吧
 上海「切塊式封城」 中共防疫模式陷危機 - 大紀元
上海「切塊式封城」 中共防疫模式陷危機 - 大紀元 小粉紅們一定很開心對吧
 Inty on Twitter中国反人类防疫,与垃圾一起躺平。
Inty on Twitter中国反人类防疫,与垃圾一起躺平。
 Inty on Twitter3月27日晚间 #上海 市府宣布,3月28日起上海以黄浦江为界分东西两区进行封控,实施新一轮 #核酸筛查 。先行被 #封控 的浦东市民只有几小时应变 ,大批市民连夜超市抢购蔬菜等物品 ,浦西市民也四处出击购买食品。 (来自 RFA_Chinese)
Inty on Twitter3月27日晚间 #上海 市府宣布,3月28日起上海以黄浦江为界分东西两区进行封控,实施新一轮 #核酸筛查 。先行被 #封控 的浦东市民只有几小时应变 ,大批市民连夜超市抢购蔬菜等物品 ,浦西市民也四处出击购买食品。 (来自 RFA_Chinese)
 Inty on Twitter中国反人类防疫初期,在新疆的实验
Inty on Twitter中国反人类防疫初期,在新疆的实验 Inty on Twitter为了所谓的维稳和防疫,中国共产党在新疆一刀切地强制上千万人不能出家门!
Inty on Twitter为了所谓的维稳和防疫,中国共产党在新疆一刀切地强制上千万人不能出家门!这位维吾尔人家里有三个人饿着,没有粮食吃了!他绝望地求着前面的维稳人员说”家里没有任何吃的了!我该怎么办,你要我自杀吗?家里三个人饿着,快饿死了,饿死了!“
 Inty on Twitter3月22日,上海两名张姓和俞姓的男子在网上发言称上海即将封城,被当地警方以造谣为名立案侦查。不到一星期,上海即宣布了疫情防控措施,虽名义上没有称之为封城,但实际方式和封城无异。 (来自 SpeechFreedomCN)
Inty on Twitter3月22日,上海两名张姓和俞姓的男子在网上发言称上海即将封城,被当地警方以造谣为名立案侦查。不到一星期,上海即宣布了疫情防控措施,虽名义上没有称之为封城,但实际方式和封城无异。 (来自 SpeechFreedomCN)
 Inty on Twitter据上海发布3月29日通报,上海新增本土感染者4477人。封控区无人机巡视督导检查,喊话浦东居民“赶紧回家”。亲历者现场视频展示“ 方舱”医院内的情形。在上海的波兰留学生MAREK NAROZNIAK分享了 #上海封城 期间的经历:“就像被关在笼子里”。
Inty on Twitter据上海发布3月29日通报,上海新增本土感染者4477人。封控区无人机巡视督导检查,喊话浦东居民“赶紧回家”。亲历者现场视频展示“ 方舱”医院内的情形。在上海的波兰留学生MAREK NAROZNIAK分享了 #上海封城 期间的经历:“就像被关在笼子里”。 Inty on Twitter俄国纳粹拿着这样的工具侵略乌克兰;
Inty on Twitter俄国纳粹拿着这样的工具侵略乌克兰;中国纳粹拿着这样的工具监禁中国人😅
 Inty on Twitter中国大陆刚刚报告了8655例新的武汉病毒病例。
Inty on Twitter中国大陆刚刚报告了8655例新的武汉病毒病例。 这个是大陆最大的单日涨幅。
虽然数字少报了很多,很假,但是已经吓唬不了世界了
 塔塔露 on Twitter当初喊着自由民主又不能当饭吃的中国人,今天就真吃不上饭了
塔塔露 on Twitter当初喊着自由民主又不能当饭吃的中国人,今天就真吃不上饭了
 Inty on Twitter【上海年迈老人为自由破墙而逃】
Inty on Twitter【上海年迈老人为自由破墙而逃】上海梅陇九村已封控了超过十天,周三(29日),小区里一位行动不便的老人,没有理会劝告,独自一人推破铁墙,为的是呼吸一下自由的空气。奇怪的是,没有人上前阻止他。
#上海封城
#自由空气 (来自 RFA_Chinese)
 Inty on Twitter中国纳粹反人类防疫现在开始使用机器狗来监禁中国人
Inty on Twitter中国纳粹反人类防疫现在开始使用机器狗来监禁中国人 Inty on Twitter受不了中国反人类防疫,上海人开始暴动了!
Inty on Twitter受不了中国反人类防疫,上海人开始暴动了!上海浦东某小区被非法封禁,人民没东西吃。
 中国悲剧档案【老号】 on Twitter
中国悲剧档案【老号】 on Twitter Inty on Twitter上海人瞬间被镇压
Inty on Twitter上海人瞬间被镇压
 Inty on Twitter中国人的家变成监狱,还叫住户好好享受。😂
Inty on Twitter中国人的家变成监狱,还叫住户好好享受。😂
 Inty on Twitter你说中国穷,五毛粉红说中国是强国;
Inty on Twitter你说中国穷,五毛粉红说中国是强国;你说中国防疫反人类,五毛粉红说我们的医疗系统不行,会瘫痪,所以要搞集中营防疫;
但是中国不停地给朝鲜,塔利班,伊朗等恐怖政权撒钱,五毛依然说我们赢了。
中国人每时每刻都是赢麻的状态。
 Inty on Twitter中国上海,惨绝人寰的反人类防疫,几百个婴儿被强制与父母分离,都进行隔离。
Inty on Twitter中国上海,惨绝人寰的反人类防疫,几百个婴儿被强制与父母分离,都进行隔离。小孩子们的大小便不能被按时清理,很多婴儿不会翻身,屁股都烂了。
以上这种情况也是过去几年中国在新疆集中营关押上百万维吾尔人造成骨肉分离的情节。
 Inty on Twitter【上海市民忍不住了】
Inty on Twitter【上海市民忍不住了】【冲破围栏高叫"我要吃平价菜"】
上海浦东一小区居民,继周二晚抗议不能买到平价菜,到周三(30日)晚,居民不理警告,冲出小区大闸,走到街道上示威。 目前未知道是否有人被捕。
(网民提供视频)
#上海清零
#上街示威 (来自 RFA_Chinese)
 Inty on Twitter在中国反人类防疫政策下,只要不报武汉病毒造成的死亡,其他怎么死都无所谓。
Inty on Twitter在中国反人类防疫政策下,只要不报武汉病毒造成的死亡,其他怎么死都无所谓。
 Inty on Twitter【中国掩盖上海疫情真相】
Inty on Twitter【中国掩盖上海疫情真相】华尔街日报报道: "最近几天,上海一家大型老年护理医院有许多老人死亡,该医院正在与武汉病毒爆发作斗争......这表明新一轮的感染潮对中国金融之都的冲击比当局公开披露的还要严重。"
 Unreported Covid Infections, Deaths Plague a Shangha...
Unreported Covid Infections, Deaths Plague a Shangha...  zhang202108 on Twitter河北开始杀动物了,不仅杀动物,阳性患者家里所有东西也会被拉走烧掉。新冠是死不了人,但是政策什么时候让你活过啊。
zhang202108 on Twitter河北开始杀动物了,不仅杀动物,阳性患者家里所有东西也会被拉走烧掉。新冠是死不了人,但是政策什么时候让你活过啊。
 来去之间💙💛 on Twitter上海浦东区,直升灰机空中监视,发现小区里有人出楼就给居委会打电话(没有轰炸)
来去之间💙💛 on Twitter上海浦东区,直升灰机空中监视,发现小区里有人出楼就给居委会打电话(没有轰炸)
 Inty on Twitter随着疫情的反弹,全国各地的网警也开始忙了起来。 (来自 SpeechFreedomCN)
Inty on Twitter随着疫情的反弹,全国各地的网警也开始忙了起来。 (来自 SpeechFreedomCN)
網址內底下留言很精彩
 Chris 𓃠 on Twitter沒想到吧,瘋人院都開始內捲起來了
Chris 𓃠 on Twitter沒想到吧,瘋人院都開始內捲起來了
 Chris 𓃠 on Twitter沒想到吧,瘋人院都開始內捲起來了
Chris 𓃠 on Twitter沒想到吧,瘋人院都開始內捲起來了
 Inty on Twitter老汉说:“美国打你们就老实了。”
Inty on Twitter老汉说:“美国打你们就老实了。”
 武漢蝙蝠俠 on Twitter中國上海防疫:把嬰幼兒抓去集中隔離,10個護士照看200個嬰幼兒,根本管不過來,任其自生自滅。
武漢蝙蝠俠 on Twitter中國上海防疫:把嬰幼兒抓去集中隔離,10個護士照看200個嬰幼兒,根本管不過來,任其自生自滅。厲害了中國!!
 Inty on Twitter中国反人类防疫案例,婴儿被强制与父母分离,进行隔离。
Inty on Twitter中国反人类防疫案例,婴儿被强制与父母分离,进行隔离。
 Inty on Twitter上海市东海老年护理医院的一名替补护工称,他被安排给一名男性患者的遗体穿衣服,这名患者感染新冠后在周一夜间死亡。
Inty on Twitter上海市东海老年护理医院的一名替补护工称,他被安排给一名男性患者的遗体穿衣服,这名患者感染新冠后在周一夜间死亡。另一名护工回想起夜里看到六辆灵车停在医院门口的情景时称,自己吓得要死,当时还说,看,看,那些是给死人用的。
 新冠疫情下一家上海老年护理医院未公布的感染与死亡 (来自 ChineseWSJ)
新冠疫情下一家上海老年护理医院未公布的感染与死亡 (来自 ChineseWSJ)
 Inty on Twitter中国说昨天有9875个新的武汉病毒病例,是有记录以来最大的单日增长。
Inty on Twitter中国说昨天有9875个新的武汉病毒病例,是有记录以来最大的单日增长。
 Inty on Twitter中国,世界最墙国,墙国最强市上海,人们像畜生一样被对待,蜂拥地抢着大白菜。饿疯了
Inty on Twitter中国,世界最墙国,墙国最强市上海,人们像畜生一样被对待,蜂拥地抢着大白菜。饿疯了 Inty on Twitter视频里说是上海宝山顾村。
Inty on Twitter视频里说是上海宝山顾村。 Inty on Twitter上海人的孩子们也被反人类的强制隔离,惨绝人寰
Inty on Twitter上海人的孩子们也被反人类的强制隔离,惨绝人寰 Inty on Twitter虽然我对中国没有一点的感情,中国也剥夺了我太多的东西。
Inty on Twitter虽然我对中国没有一点的感情,中国也剥夺了我太多的东西。但是看到这些中国的小孩子们跟我的孩子们差不多大,我看着看着哭了。。。
 Inty on Twitter如果你不想在中国当畜生,不想让你的孩子像下面一样被拉进集中营,赶快想办法离开,不能离开的话,千万不要生孩子。
Inty on Twitter如果你不想在中国当畜生,不想让你的孩子像下面一样被拉进集中营,赶快想办法离开,不能离开的话,千万不要生孩子。
 Inty on Twitter有些人好像不了解上海。上海在中国算是最富有的城市,但是除了很多高层,该城市也有很多贫民区
Inty on Twitter有些人好像不了解上海。上海在中国算是最富有的城市,但是除了很多高层,该城市也有很多贫民区
 Inty on Twitter上海反人类防疫疾控中心通话录音,据说墙内已经和谐,掩盖真相
Inty on Twitter上海反人类防疫疾控中心通话录音,据说墙内已经和谐,掩盖真相
 Inty on Twitter李克强说:“两年前我刚刚说6亿多中国人人均月收入不到1000人民币。为什么五毛粉红不相信我的。还有我搞城镇化,主要目的是把大量老百姓的家乡和房子都拆掉,都扔进鸡笼一样的网格小区楼房,方便随时免费搞成监狱和集中营“
Inty on Twitter李克强说:“两年前我刚刚说6亿多中国人人均月收入不到1000人民币。为什么五毛粉红不相信我的。还有我搞城镇化,主要目的是把大量老百姓的家乡和房子都拆掉,都扔进鸡笼一样的网格小区楼房,方便随时免费搞成监狱和集中营“ Inty on Twitter山东临沂
Inty on Twitter山东临沂
 Inty on Twitter在英国检测到新的武汉病毒变体“XE”,专家说“现在还不能说”它的传染性如何。
Inty on Twitter在英国检测到新的武汉病毒变体“XE”,专家说“现在还不能说”它的传染性如何。中国反人类防疫准备好了,XE要来了……
 Inty on Twitter我就是看完了中国将近30个省,得出结论,此国非常反人类,不适合人类居住。
Inty on Twitter我就是看完了中国将近30个省,得出结论,此国非常反人类,不适合人类居住。我赶紧跑了。
 变态辣椒RebelPepper on Twitter全國各省一起努力,把唯一一個地方政府收入為正的上海弄死
变态辣椒RebelPepper on Twitter全國各省一起努力,把唯一一個地方政府收入為正的上海弄死
 Inty on Twitter中国官方报告了13146例新的武汉病毒病例,这是迄今为止有史以来最大的单日增幅
Inty on Twitter中国官方报告了13146例新的武汉病毒病例,这是迄今为止有史以来最大的单日增幅
 Inty on Twitter上海防疫集中营,缺水缺吃的,有重病的人不能得到救治,等死中。
Inty on Twitter上海防疫集中营,缺水缺吃的,有重病的人不能得到救治,等死中。
 Inty on Twitter独立时评人郑旭光说,上海突然封城显示“上海帮”受到政治碾压。他说,中国防疫致命问题是政治挂帅,至今不批上海复星代理的辉瑞疫苗,造成人祸,实际上是犯罪。 #时事大家谈 完整版:
Inty on Twitter独立时评人郑旭光说,上海突然封城显示“上海帮”受到政治碾压。他说,中国防疫致命问题是政治挂帅,至今不批上海复星代理的辉瑞疫苗,造成人祸,实际上是犯罪。 #时事大家谈 完整版: 4/2【时事大家谈】上海封城 经济引擎熄火的代价多少? (来自 VOAChinese)
4/2【时事大家谈】上海封城 经济引擎熄火的代价多少? (来自 VOAChinese)
 桑迪 on Twitter我在嘉定,3月12日起开始封小区,中间陆续解封过几天。至今社区未送过一次蔬菜或物资,今天上午挨家挨户发黄芪。我不理解在医疗资源已经短缺的情况下,给居民发黄芪这种毒性强的中药是什么脑回路。
桑迪 on Twitter我在嘉定,3月12日起开始封小区,中间陆续解封过几天。至今社区未送过一次蔬菜或物资,今天上午挨家挨户发黄芪。我不理解在医疗资源已经短缺的情况下,给居民发黄芪这种毒性强的中药是什么脑回路。 Inty on Twitter上海浦东世博园被改为关中国人的集中营。
Inty on Twitter上海浦东世博园被改为关中国人的集中营。里面数万人没吃的。
 Inty on Twitter老大哥把你自己的家变成免费监狱的同时,还用你的微信来监控你一举一动。
Inty on Twitter老大哥把你自己的家变成免费监狱的同时,还用你的微信来监控你一举一动。
 Inty on Twitter上海的老外翻墙说:他们被关了16天了,抢不到吃的。
Inty on Twitter上海的老外翻墙说:他们被关了16天了,抢不到吃的。看来自从习近平绑架加拿大人搞人质外交以后,取消了上海老外的特殊待遇哈。
👇
 Jared T Nelson on Twitter
Jared T Nelson on Twitter  Inty on Twitter很多中国人辩解说关押上百万维吾尔人进集中营怎么可能?
Inty on Twitter很多中国人辩解说关押上百万维吾尔人进集中营怎么可能?现在这些人都得到了现世报,你看看2200万上海人一瞬间都可以进集中营,而且你自己的家和小区也变成了关押你的监狱和集中营。
 Inty on Twitter中国人说以后会怎么样?
Inty on Twitter中国人说以后会怎么样?下面视频就是中国人要“享受”的下一步。
 李成义lichengyi on Twitter2020年3月16日
李成义lichengyi on Twitter2020年3月16日1959年到1961年,甘肃临夏人吃人,哪县哪公社哪大队谁吃人了,都记录的清清楚楚。怎么人吃人?大饥荒饿啊,吃死人,吃活人,多么惨无人道的时代。谁能把甘肃天水五八年到六一年人吃人的史料挖出来,就是天水的史家!只有把那个时代的野蛮和残忍公示于世,才能阻击一些无脑青年的左转路!
 Inty on Twitter上海人接受解放军的亲切问候
Inty on Twitter上海人接受解放军的亲切问候
 Inty on Twitter上海人热情款待外地人。物資不發給外地人
Inty on Twitter上海人热情款待外地人。物資不發給外地人
 Inty on Twitter法国驻上海领馆:请勿将侨民母子分开隔离
Inty on Twitter法国驻上海领馆:请勿将侨民母子分开隔离  法国驻上海领馆:请勿将侨民母子分开隔离
法国驻上海领馆:请勿将侨民母子分开隔离  Inty on Twitter中国官方最新报告了13146例新的武汉病毒病例,仅比昨天的历史最高值低几例。
Inty on Twitter中国官方最新报告了13146例新的武汉病毒病例,仅比昨天的历史最高值低几例。
 Inty on Twitter曾经霸气的上海人
Inty on Twitter曾经霸气的上海人 南粵國人 on Twitter😂剛剛我在上海群裡 看了他們上海群的動態 前期時有一個人為上海人發聲 上海人還挺感謝他的 就在這幾天上海人陸續收到菜包了 然後他們開始罵為他們發聲的那個人 賤奴本性難改
南粵國人 on Twitter😂剛剛我在上海群裡 看了他們上海群的動態 前期時有一個人為上海人發聲 上海人還挺感謝他的 就在這幾天上海人陸續收到菜包了 然後他們開始罵為他們發聲的那個人 賤奴本性難改 Jack on Twitterinty哥 在上海呆过,和我们讲讲上海的特点哈哈
Jack on Twitterinty哥 在上海呆过,和我们讲讲上海的特点哈哈
 Inty on Twitter阿拉桑海宁,侬脑子瓦特拉,测你娘个逼,册那。
Inty on Twitter阿拉桑海宁,侬脑子瓦特拉,测你娘个逼,册那。我凭借着优异的学习成绩考到了上海的新疆班上高中,一下从哈萨克斯坦边上的农村来到了上海,然后又考上了大学。 呆了10年多,为了跟当地人交往,我学了一点上海话,但是现在差不多忘光了。
因为的确上海人普遍瞧不起外地人,所以你得至少学会他们怎么骂人的。
如果你用上海话骂回去,他们立刻闭嘴。😂
 Inty on Twitter【上海一線抗疫醫生自述:封城死去的患者比病毒致死更多,已是醫生共識】上海市從今日開始講對全市近2500萬人口進行全面核酸檢測。近日,上海浦東一位一線抗疫醫生接受了端傳媒採訪,講述了上海疫情如何失控至此,以及「動態清零」措施實施至今的代價…
Inty on Twitter【上海一線抗疫醫生自述:封城死去的患者比病毒致死更多,已是醫生共識】上海市從今日開始講對全市近2500萬人口進行全面核酸檢測。近日,上海浦東一位一線抗疫醫生接受了端傳媒採訪,講述了上海疫情如何失控至此,以及「動態清零」措施實施至今的代價… 上海一線抗疫醫生:因封控去世的患者可能比病毒致死的更多,已是醫生共識|端傳媒 Initium Media
上海一線抗疫醫生:因封控去世的患者可能比病毒致死的更多,已是醫生共識|端傳媒 Initium Media#中國武漢肺炎病毒防疫
 Peter Pan on Twitter😄你是CCP 民族政策的既得利益者,按道理需要“感恩戴德”,愛黨愛國愛當朝聖上。我這種九等漢人,當年的地富反壞右後代,壓根就沒有這種機會。
Peter Pan on Twitter😄你是CCP 民族政策的既得利益者,按道理需要“感恩戴德”,愛黨愛國愛當朝聖上。我這種九等漢人,當年的地富反壞右後代,壓根就沒有這種機會。 Inty on Twitter其实新疆班就是中共的第一批集中营教育中心。 把我们这样来自农村的学习优异的孩子集中起来洗脑。但是没用的,因为剥夺自由以后,再教育,反而会培养出来我这样的“反华分子,颠覆国家政权罪犯“😂。
Inty on Twitter其实新疆班就是中共的第一批集中营教育中心。 把我们这样来自农村的学习优异的孩子集中起来洗脑。但是没用的,因为剥夺自由以后,再教育,反而会培养出来我这样的“反华分子,颠覆国家政权罪犯“😂。 所以中共后面直接开始关押上百万维吾尔人了。我也预料到这个会发生,所以跑的早。
 Inty on Twitter【外省武警进驻上海 学者:上海一出事就非小事】
Inty on Twitter【外省武警进驻上海 学者:上海一出事就非小事】上海浦西一学者张进对本台说,目前,他居住的社区门口有武站哨,防止居民翻墙或随意外出:
“一个小区门口派驻一个持枪特警,怕上海出事,现在就要管起来,(上海)出事就不是小事。”
 上海疫情失控外地武警进城 防控手段已把专家“逼疯”恭喜啊,現在我們也可以說支持黑警了
上海疫情失控外地武警进城 防控手段已把专家“逼疯”恭喜啊,現在我們也可以說支持黑警了
 Inty on Twitter鲁东大学硕士研究生孙健,因在校园内举着写有“鲁东解封”和“坚决反对如此高频的全员核酸检测”的纸牌在校园内行走约20分钟,被公安处以警告训诫并被其学校开除学籍。 (来自 SpeechFreedomCN)
Inty on Twitter鲁东大学硕士研究生孙健,因在校园内举着写有“鲁东解封”和“坚决反对如此高频的全员核酸检测”的纸牌在校园内行走约20分钟,被公安处以警告训诫并被其学校开除学籍。 (来自 SpeechFreedomCN)
 Inty on Twitter中国人像狗一样生活
Inty on Twitter中国人像狗一样生活
 Inty on Twitter听我说声谢谢你,因为有你,中国变得更墙大
Inty on Twitter听我说声谢谢你,因为有你,中国变得更墙大
 Inty on Twitter
Inty on Twitter 中国鲁东大学研究生因举牌抗议封闭校园竟遭开除处分
中国鲁东大学研究生因举牌抗议封闭校园竟遭开除处分 Inty on Twitter中国官方报告了16412个新的武汉病毒病例,虽然少报了很多,但还是有记录以来最大的单日增长。
Inty on Twitter中国官方报告了16412个新的武汉病毒病例,虽然少报了很多,但还是有记录以来最大的单日增长。
 Inty on Twitter上海方舱集中营,没有应急措施,没有医护人员,没有口罩,蚂蚁窝一样
Inty on Twitter上海方舱集中营,没有应急措施,没有医护人员,没有口罩,蚂蚁窝一样 Inty on Twitter中国防疫写照---好戏在后头
Inty on Twitter中国防疫写照---好戏在后头 Inty on Twitter用红歌消灭病毒
Inty on Twitter用红歌消灭病毒 Inty on Twitter大陆不少网民这几天形容上海的情况,尤如近年的新疆,又或是1949年沦陷的上海。
Inty on Twitter大陆不少网民这几天形容上海的情况,尤如近年的新疆,又或是1949年沦陷的上海。#上海
#新疆
#1949
 新台灣國防軍事網 on Twitter
新台灣國防軍事網 on Twitter 影片流出!強押上海居民隔離 疑中國軍人動粗「不配合就揍」 - 國際 - 自由時報電子報快報:剛好給大家看看中國共軍怎樣打韭菜 ...
影片流出!強押上海居民隔離 疑中國軍人動粗「不配合就揍」 - 國際 - 自由時報電子報快報:剛好給大家看看中國共軍怎樣打韭菜 ...中國武漢肺炎重災區之一的上海民怨四起,網上陸續傳出影片,身穿防護衣的中國人員粗暴將民眾推上隔離專車,引發熱議。網友指稱片中穿著防護服的其實是中國解放軍的軍人
可以看到數名身穿白色防護服的中國人員架著民眾上隔離專車,彷彿是在對待犯人一般;如遇有抵抗者,中國人員則連推帶扯的將其強行送上車。片中就有一名女子不滿遭粗暴對待,一名中國人員見狀竟直接補上兩拳,影片中還能聽到其他人替女子抱不平質問「怎麼還打人了你們」?
 Inty on Twitter从4月4日早上开始,#何岸泉 heanquan停止了除补充水分之外的一切进食活动。绝食活动将会持续三天三夜。“作为一个 #上海人 ,对2500万居住、工作、出生在上海的上海市民来说,我唯一能够做的就是以这种方式,表达对他们的声援、对他们处境的担忧。”
Inty on Twitter从4月4日早上开始,#何岸泉 heanquan停止了除补充水分之外的一切进食活动。绝食活动将会持续三天三夜。“作为一个 #上海人 ,对2500万居住、工作、出生在上海的上海市民来说,我唯一能够做的就是以这种方式,表达对他们的声援、对他们处境的担忧。” 旅美异见人士纽约中领馆外绝食抗议上海封城滿無聊的
旅美异见人士纽约中领馆外绝食抗议上海封城滿無聊的
 Inty on Twitter#揭谎频道 研究证实新冠病毒由美国莫德纳公司制造?该阴谋论已屡被揭穿,但在严格审查下的中国微博上,相关话题标签仍在流传,相关辟谣文章则遭删除。此前,在中国官媒助推下,该话题一度冲上热搜榜榜首。这是什么研究?这波阴谋论从何而来?
Inty on Twitter#揭谎频道 研究证实新冠病毒由美国莫德纳公司制造?该阴谋论已屡被揭穿,但在严格审查下的中国微博上,相关话题标签仍在流传,相关辟谣文章则遭删除。此前,在中国官媒助推下,该话题一度冲上热搜榜榜首。这是什么研究?这波阴谋论从何而来? 揭谎频道:新冠病毒是莫德纳制造?中国官方又一次大力扶植阴谋论
揭谎频道:新冠病毒是莫德纳制造?中国官方又一次大力扶植阴谋论  Inty on Twitter中国把人民的家搞成监狱,然后派出无人机机器人来巡逻,还叫人们 “控制灵魂对自由的渴望”。。。
Inty on Twitter中国把人民的家搞成监狱,然后派出无人机机器人来巡逻,还叫人们 “控制灵魂对自由的渴望”。。。如果一个人没有了对自由的渴望,就会失去改变自己的勇气和思想,就会成为任人宰割的僵尸奴隶。
 Inty on Twitter这样的防疫措施,是防疫还是军管?
Inty on Twitter这样的防疫措施,是防疫还是军管?中国功夫,治疗武汉病毒。
中国功夫清零政策
 Inty on Twitter中國防疫日常
Inty on Twitter中國防疫日常 Inty on Twitter中國各地"#封城"手段雷厲風行,但政府執行能力有限,無法解決各種社會需求,引發民眾不滿,執法者卻用 #暴力 手段對付。 (線民提供視頻) (來自 RFA_Chinese)
Inty on Twitter中國各地"#封城"手段雷厲風行,但政府執行能力有限,無法解決各種社會需求,引發民眾不滿,執法者卻用 #暴力 手段對付。 (線民提供視頻) (來自 RFA_Chinese) Inty on Twitter謊言和暴力,中國優秀歷史文化傳統
Inty on Twitter謊言和暴力,中國優秀歷史文化傳統
 中国悲剧档案【老号】 on Twitter上海反人类防疫不给外地人发物资,于是有了【上海版侠盗猎车手】
中国悲剧档案【老号】 on Twitter上海反人类防疫不给外地人发物资,于是有了【上海版侠盗猎车手】 Inty on Twitter上海浦东发生骚乱!不给外地人发物资,外地人抢物资了!
Inty on Twitter上海浦东发生骚乱!不给外地人发物资,外地人抢物资了! Inty on Twitter中国反人类防疫,上海人被隔离集中在猪圈
Inty on Twitter中国反人类防疫,上海人被隔离集中在猪圈 Inty on Twitter桑海宁被隔离的豪华房舱集中营
Inty on Twitter桑海宁被隔离的豪华房舱集中营
 Inty on Twitter上海全民健身
Inty on Twitter上海全民健身
 Inty on Twitter网上疯传一名老先生走下楼,对阻挡在外的人员咆哮说:“整天闷在监狱里啊!要讲科学的嘛!要讲道理的嘛,这样搞有什么名堂,是谁在搞?比文化大革命还文化大革命,运动群众嘛?什么目的嘛?没有矛盾制造矛盾!没有障碍制造障碍!”
Inty on Twitter网上疯传一名老先生走下楼,对阻挡在外的人员咆哮说:“整天闷在监狱里啊!要讲科学的嘛!要讲道理的嘛,这样搞有什么名堂,是谁在搞?比文化大革命还文化大革命,运动群众嘛?什么目的嘛?没有矛盾制造矛盾!没有障碍制造障碍!”#清零 #暴力防疫
 坚持清零 中国多地现"文革式"暴力防疫 (来自 RFA_Chinese)
坚持清零 中国多地现"文革式"暴力防疫 (来自 RFA_Chinese)
 Inty on Twitter红歌灭武汉病毒🦠
Inty on Twitter红歌灭武汉病毒🦠 Inty on Twitter#季孝龙:#上海封城 这是第一次,历史上上海开埠以来第一次。就连日军当年侵华、占领上海的时候,也会给在上海生活的人发放良民证,不会让城市停下里,日本人都不会让城市停下来。您记住,日本人都不会让这个城市停下来。
Inty on Twitter#季孝龙:#上海封城 这是第一次,历史上上海开埠以来第一次。就连日军当年侵华、占领上海的时候,也会给在上海生活的人发放良民证,不会让城市停下里,日本人都不会让城市停下来。您记住,日本人都不会让这个城市停下来。#运动式防疫
 专访季孝龙:为上海请命 停止运动式防疫
专访季孝龙:为上海请命 停止运动式防疫  Inty on Twitter中国防疫,为什么人们没东西吃?
Inty on Twitter中国防疫,为什么人们没东西吃?因为都被摄像机吃了
 Inty on Twitter中国刚刚报告了22995例新的武汉病毒病例,虽然很假,但再次打破单日增幅纪录
Inty on Twitter中国刚刚报告了22995例新的武汉病毒病例,虽然很假,但再次打破单日增幅纪录 Inty on Twitter上海普陀区一个正常的男子,都被封城政策逼死这样了,就连共产党都敢骂。
Inty on Twitter上海普陀区一个正常的男子,都被封城政策逼死这样了,就连共产党都敢骂。(上海网民提供视频) (来自 RFA_Chinese)
 Inty on Twitter【真正的大翻译,上海老外亲自上阵】
Inty on Twitter【真正的大翻译,上海老外亲自上阵】"我回顾了我们的测试历史以确认,这是连续第12次阴性测试。
连续12次阴性测试,我已经完全接种了疫苗,在过去的19天里一直处于严格的禁闭状态,但仍然--我不允许离开,如果我尝试,他们(中国警察)会逮捕和拘留我。"
 Jared T Nelson on Twitter
Jared T Nelson on Twitter  Inty on Twitter大连男子渠某,因在推特发表了“涉党、政治体系、侮辱国家领导人等各类不当言论推文”17条,于2020年9月被当地检方以寻衅滋事为罪名提起公诉,后续刑罚不明。 (来自 SpeechFreedomCN)
Inty on Twitter大连男子渠某,因在推特发表了“涉党、政治体系、侮辱国家领导人等各类不当言论推文”17条,于2020年9月被当地检方以寻衅滋事为罪名提起公诉,后续刑罚不明。 (来自 SpeechFreedomCN) Inty on Twitter防疫需要隔離,但核酸不需要。😂
Inty on Twitter防疫需要隔離,但核酸不需要。😂
 Inty on Twitter大陆50后的人,对成都青羊区政府挂出这样的横额,应该不会感到陌生。
Inty on Twitter大陆50后的人,对成都青羊区政府挂出这样的横额,应该不会感到陌生。网民提供图片
#文化大革命 #阶级斗争 #阶级敌人 #倒车
 Inty on Twitter【中国再创纪录】中国报告了24101个新的武汉病毒病例,是有记录以来最大的单日增长。上海占了新病例的88%,虽然少报很多,但依然创造纪录
Inty on Twitter【中国再创纪录】中国报告了24101个新的武汉病毒病例,是有记录以来最大的单日增长。上海占了新病例的88%,虽然少报很多,但依然创造纪录
 Inty on Twitter吉林长春公安部门4月7日发布通告,宣布查处了一批“涉疫违法犯罪案件”。其中,有四起案件与民众经营超市、售卖蔬菜水果有关。
Inty on Twitter吉林长春公安部门4月7日发布通告,宣布查处了一批“涉疫违法犯罪案件”。其中,有四起案件与民众经营超市、售卖蔬菜水果有关。#长春封城
 封城下的长春:多名超市和餐饮业者遭警方处罚 (来自 RFA_Chinese)
封城下的长春:多名超市和餐饮业者遭警方处罚 (来自 RFA_Chinese)
 Inty on Twitter【吉林公安拘捕前先公审】
Inty on Twitter【吉林公安拘捕前先公审】吉林公安拘捕一名在社交媒体批评防疫政策的居民,在上门拘捕前,公安用扬声器宣读被捕者的 身分和“罪状”,犹如公审一样。
(网民提供视频)
#公审
#文革
#政治运动
#造谣 (来自 RFA_Chinese)
 Inty on Twitter“政府确实发了一批物资,但是即使发得再多小区,跟封控时间比,食物远远是不够的。”住在上海的夏小姐对本台形容上海的现状称,外卖没了,淘宝、快递都停了,团购也非常难买到,每天“河马”网购会放出一些额度,但是非常难抢到。#上海封城
Inty on Twitter“政府确实发了一批物资,但是即使发得再多小区,跟封控时间比,食物远远是不够的。”住在上海的夏小姐对本台形容上海的现状称,外卖没了,淘宝、快递都停了,团购也非常难买到,每天“河马”网购会放出一些额度,但是非常难抢到。#上海封城  上海传断粮危机:不论穷富都求救 有人想冲出小区吃牢饭
上海传断粮危机:不论穷富都求救 有人想冲出小区吃牢饭 上海巨富居然求购面包牛奶,卡车司机短缺加剧封城困境
上海巨富居然求购面包牛奶,卡车司机短缺加剧封城困境 中国当局强化对民众监控能力,人工智能软件或助纣为虐
中国当局强化对民众监控能力,人工智能软件或助纣为虐  Inty on Twitter《强大的中国》与《幸福中国人》
Inty on Twitter《强大的中国》与《幸福中国人》 Inty on Twitter《中国社会主义好》《让人们幸福当家作主》
Inty on Twitter《中国社会主义好》《让人们幸福当家作主》 中国开冬奥庆功会 习近平称中国疫情防御制式也应获金牌
中国开冬奥庆功会 习近平称中国疫情防御制式也应获金牌 Inty on Twitter中国冬奥会成绩,归功于“英明领袖”习近平
Inty on Twitter中国冬奥会成绩,归功于“英明领袖”习近平
 Inty on Twitter美国重新发布对中国的旅行警告,级别为3级,"请勿前往香港、吉林省和上海",其它地区请三思。
Inty on Twitter美国重新发布对中国的旅行警告,级别为3级,"请勿前往香港、吉林省和上海",其它地区请三思。并授权美国驻上海领事馆人员自愿离开,因为2500万人口的城市出现了严酷残忍的封锁。
据路透社报道,中国至少有23个城市的1.93亿人口处于全面或部分封锁状态。包括监禁普通人、隔离儿童、宠物、警察监控等
 Inty on Twitter江苏省镇江市男子叶某和广东深圳男子黄某,因在GTV和微信上发布“有害、不实且损害国家形象的信息”,先由镇江公安以资助危害国家安全犯罪活动罪刑事拘留,后由镇江检方改为寻衅滋事罪提起公诉,后续刑罚未知。 (来自 SpeechFreedomCN)
Inty on Twitter江苏省镇江市男子叶某和广东深圳男子黄某,因在GTV和微信上发布“有害、不实且损害国家形象的信息”,先由镇江公安以资助危害国家安全犯罪活动罪刑事拘留,后由镇江检方改为寻衅滋事罪提起公诉,后续刑罚未知。 (来自 SpeechFreedomCN)
魂歸故土滿好的啊
 @jimmy1688 - [轉]溫馨洨故事 基本上,目前的上海市,已經把「養老院」和「臨時集中收屍場」劃...
@jimmy1688 - [轉]溫馨洨故事 基本上,目前的上海市,已經把「養老院」和「臨時集中收屍場」劃... @jimmy1688 - 可以的話最好還是不要染病武漢肺炎,還是有可能會有後作用,這我當然知道要不然戴口...
@jimmy1688 - 可以的話最好還是不要染病武漢肺炎,還是有可能會有後作用,這我當然知道要不然戴口... @thorhsu - 朋友微信群組傳的,長春也在封控了
@thorhsu - 朋友微信群組傳的,長春也在封控了 @wbsearch404 - 【微博觀察/上海疫情/防疫亂象/物資倒賣】 上海寶山發公告表示:[關閉評論...
@wbsearch404 - 【微博觀察/上海疫情/防疫亂象/物資倒賣】 上海寶山發公告表示:[關閉評論... @wbsearch404 - 【微博觀察/上海疫情/醫護人員/防疫亂象/方艙醫院】 【上海疫情下的医务人...
@wbsearch404 - 【微博觀察/上海疫情/醫護人員/防疫亂象/方艙醫院】 【上海疫情下的医务人... @wbsearch404 - 【微博觀察/上海疫情/醫病關係/防疫亂象/防疫致死】 又一個因為上海防疫隔...
@wbsearch404 - 【微博觀察/上海疫情/醫病關係/防疫亂象/防疫致死】 又一個因為上海防疫隔... @wbsearch404 - 【微博觀察/上海疫情/醫病關係/防疫亂象/社會救助/老人】 【江西老人到上...
@wbsearch404 - 【微博觀察/上海疫情/醫病關係/防疫亂象/社會救助/老人】 【江西老人到上... @wbsearch404 - 【微博觀察/上海疫情/防疫亂象/物資缺乏】 另一個區的抗議
@wbsearch404 - 【微博觀察/上海疫情/防疫亂象/物資缺乏】 另一個區的抗議
 Inty on Twitter我想问一句:张某和俞某的案件进一步审理了这么久,审完了吗?
Inty on Twitter我想问一句:张某和俞某的案件进一步审理了这么久,审完了吗?没事,我已经帮你们把辟谣的说辞想好了:明明要封这么久,他俩却只说封七天,这不是造谣是什么? (来自 SpeechFreedomCN)
 新台灣國防軍事網 on Twitter
新台灣國防軍事網 on Twitter 上海人缺糧挨餓不忍了!民眾集體抗議喊「發物資」現場傳有槍聲 - 國際 - 自由時報電子報平常中國一大堆五毛與小粉紅喜歡翻牆罵人
上海人缺糧挨餓不忍了!民眾集體抗議喊「發物資」現場傳有槍聲 - 國際 - 自由時報電子報平常中國一大堆五毛與小粉紅喜歡翻牆罵人現在看到上海缺糧挨餓不知道有何感想?習近平把中國人看的比韭菜還不值。中國網友相當不解質疑物資到底去哪了?更有中國網友反串狠諷中國政府:「這背後肯定有外國勢力」、「說得太對了,以前境外勢力滲入還得給錢,現在給點飯吃就行了,成本這麼低能不滲入嗎?」也有小粉紅嗆爆料網友「你再造謠,擾亂軍心,以叛國罪漢奸論處」反被其他人怒斥「趕緊來上海感受一下可以嗎?不給你飯吃的滋味來試試!」
中國武漢肺炎疫情爆炸,上海防疫手段罔顧人權,物資分配頻頻出包,平民忍無可忍開始出現集體抗議行動。多支影片顯示上海松江一處社區民眾群聚門口高喊「發物資」引發中國網友關注。
 Inty on Twitter“手术很成功,但病人死了”
Inty on Twitter“手术很成功,但病人死了”#上海封控 下的 #次生灾难
 医疗挤兑与"额外死亡":上海封控下的次生灾难 (来自 RFA_Chinese)
医疗挤兑与"额外死亡":上海封控下的次生灾难 (来自 RFA_Chinese) Inty on Twitter任瑞红分析说,#上海疫情 暴发很可能正是一场政治博弈的结果:“我们可以看出,本轮疫情在江浙沪地区出现了急转直下的大暴发,事实上与上海经济利益集团对中央‘#清零’政策长期的不满和暗地里的对抗有关。”
Inty on Twitter任瑞红分析说,#上海疫情 暴发很可能正是一场政治博弈的结果:“我们可以看出,本轮疫情在江浙沪地区出现了急转直下的大暴发,事实上与上海经济利益集团对中央‘#清零’政策长期的不满和暗地里的对抗有关。”  上海坚持"清零"民怨四起 当局有难言之隐? (来自 RFA_Chinese)
上海坚持"清零"民怨四起 当局有难言之隐? (来自 RFA_Chinese)
 Inty on Twitter上海封控 美国授权驻上海领事馆外交官可自愿离开
Inty on Twitter上海封控 美国授权驻上海领事馆外交官可自愿离开  上海封控 美国授权驻上海领事馆外交官可自愿离开
上海封控 美国授权驻上海领事馆外交官可自愿离开  针对中国“任意”执行严厉防疫管控措施,美国务院批准上海总领馆非紧急雇员和家属自愿撤离
针对中国“任意”执行严厉防疫管控措施,美国务院批准上海总领馆非紧急雇员和家属自愿撤离 中国曾利用美国的电视和TikTok明星进行奥运宣传
中国曾利用美国的电视和TikTok明星进行奥运宣传 Inty on Twitter中国反人类防疫,老人被关进笼子里
Inty on Twitter中国反人类防疫,老人被关进笼子里 奥秘克隆杀伤率低于流感 中国媒体人质疑盲目清零政策
奥秘克隆杀伤率低于流感 中国媒体人质疑盲目清零政策 Inty on Twitter广州人不相信共产党的宣传,开始抢物资了
Inty on Twitter广州人不相信共产党的宣传,开始抢物资了 Inty on Twitter上海反人类防疫,上了推特热搜。
Inty on Twitter上海反人类防疫,上了推特热搜。正宗大翻译😄
(热搜链接 https://twitter.com/...
 Inty on Twitter
Inty on Twitter 北京新发地料将接手大午集团 观察人士:中共“抢钱、侵占私企财产”
北京新发地料将接手大午集团 观察人士:中共“抢钱、侵占私企财产” Inty on Twitter上海人不让出门,晚上饿肚子,嗷嗷大叫;
Inty on Twitter上海人不让出门,晚上饿肚子,嗷嗷大叫;民主不能当饭吃,但没了民主,就没饭吃。
 头条趋势 on Twitter
头条趋势 on Twitter 中国如何在追求 "COVID Zero "的过程中残酷对待其人民 - 头条趋势
中国如何在追求 "COVID Zero "的过程中残酷对待其人民 - 头条趋势 Inty on Twitter中国新报告了26355个新的武汉病毒病例,是有记录以来最大的单日增长,虽然少报很多,非常假,但是依然创造了历史
Inty on Twitter中国新报告了26355个新的武汉病毒病例,是有记录以来最大的单日增长,虽然少报很多,非常假,但是依然创造了历史这几天,出现了一些比较高级的为中国反人类防疫辩护的言论。
再次强调: 不让一个人出自己的家,然后哪怕给他满汉全席,山珍海味,那也是剥夺人身自由,违反人权。
还是有人不懂得什么是自由,还在为中国反人类防疫辩解,还有说要保持中立客观😅
这样的人见一个拉黑一个。
 Inty on Twitter疫情期间也不忘地沟油
Inty on Twitter疫情期间也不忘地沟油 Inty on Twitter荷兰国际集团ING银行最新评论指出,如果 #上海封城 措施只在四月持续,上海的GDP可能损失6%,但也会给全国GDP带来2%的损失。该行也将中国第二季度GDP的预测从5%降到了4%。
Inty on Twitter荷兰国际集团ING银行最新评论指出,如果 #上海封城 措施只在四月持续,上海的GDP可能损失6%,但也会给全国GDP带来2%的损失。该行也将中国第二季度GDP的预测从5%降到了4%。 上海继续封城 可能让全国GDP损失2% (来自 RFA_Chinese)
上海继续封城 可能让全国GDP损失2% (来自 RFA_Chinese) Inty on Twitter网络热门视频,中国反人类防疫真实写照
Inty on Twitter网络热门视频,中国反人类防疫真实写照
 Inty on Twitter随着中国政治、经济全面倒退,国际环境空前恶化,举国清零政策搞得民不聊生,防火长城外恶搞、讽刺、侮辱 #习近平 的作品层出不穷。几位"#辱包"人士告诉美国之音,这些黑色幽默的背后是中国人的愤怒、无奈与抗争。
Inty on Twitter随着中国政治、经济全面倒退,国际环境空前恶化,举国清零政策搞得民不聊生,防火长城外恶搞、讽刺、侮辱 #习近平 的作品层出不穷。几位"#辱包"人士告诉美国之音,这些黑色幽默的背后是中国人的愤怒、无奈与抗争。  “辱包”,中国人黑色幽默背后的愤怒、无奈与抗争 (来自 VOAChinese)
“辱包”,中国人黑色幽默背后的愤怒、无奈与抗争 (来自 VOAChinese)
 Inty on Twitter非常听话的等着喂食 。
Inty on Twitter非常听话的等着喂食 。像什么? 请大家留言
 Inty on Twitter吉林省吉林市公安在某小区内公开喊话警告威胁一名发布不当言论的居民,要求其删除不当言论并接电话。吉林市处于疫情封控状态,可能因此警察没有直接上门查水表。 (来自 SpeechFreedomCN)
Inty on Twitter吉林省吉林市公安在某小区内公开喊话警告威胁一名发布不当言论的居民,要求其删除不当言论并接电话。吉林市处于疫情封控状态,可能因此警察没有直接上门查水表。 (来自 SpeechFreedomCN) Inty on Twitter被关“防疫集中营”的东北女孩
Inty on Twitter被关“防疫集中营”的东北女孩
 Inty on Twitter中国的上海等地人民没东西吃,但是与此同时中国送古巴5000多吨大米和其他物资。
Inty on Twitter中国的上海等地人民没东西吃,但是与此同时中国送古巴5000多吨大米和其他物资。中共眼里,古巴人都比上海人高贵了😂
 木星 on Twitter你个傻逼,上海不是没东西,是配送有问题,你他妈的在国外待的脑子坏掉了
木星 on Twitter你个傻逼,上海不是没东西,是配送有问题,你他妈的在国外待的脑子坏掉了 Inty on Twitter看这个五毛急了😂
Inty on Twitter看这个五毛急了😂中共都可以按时把5000多吨大米配送到古巴,为什么在上海出问题。
中共永远伟大,光明,正确,你这五毛居然敢指责中共。😄
 Inty on Twitter#上海 全域封城,解封无期。前美国沃尔特•里德陆军研究所病毒研究员林晓旭说,#习近平 借防疫考验上海,逼迫上海抛弃科学思路,走向政治运动式防疫,让老百姓成为牺牲品。 #时事大家谈 完整版:
Inty on Twitter#上海 全域封城,解封无期。前美国沃尔特•里德陆军研究所病毒研究员林晓旭说,#习近平 借防疫考验上海,逼迫上海抛弃科学思路,走向政治运动式防疫,让老百姓成为牺牲品。 #时事大家谈 完整版: 4/9【时事大家谈】上海疫情失控 中央介入政治寓意大于防疫?苏州惊现奥密克戎新变体威胁多大? (来自 VOAChinese)
4/9【时事大家谈】上海疫情失控 中央介入政治寓意大于防疫?苏州惊现奥密克戎新变体威胁多大? (来自 VOAChinese) Inty on Twitter中国副总理孙春兰视察 #上海 时强调,“要坚持动态清零总方针”,上海不能例外。前上海外科医生何岸泉说,中央介入给上海黄牌警告,不允许在防疫上搞“一国两制”。#时事大家谈 完整版:
Inty on Twitter中国副总理孙春兰视察 #上海 时强调,“要坚持动态清零总方针”,上海不能例外。前上海外科医生何岸泉说,中央介入给上海黄牌警告,不允许在防疫上搞“一国两制”。#时事大家谈 完整版: 4/9【时事大家谈】上海疫情失控 中央介入政治寓意大于防疫?苏州惊现奥密克戎新变体威胁多大? (来自 VOAChinese)
4/9【时事大家谈】上海疫情失控 中央介入政治寓意大于防疫?苏州惊现奥密克戎新变体威胁多大? (来自 VOAChinese)
 Inty on Twitter用抓动物的工具来抓中国人
Inty on Twitter用抓动物的工具来抓中国人China's Government Catching Chinese people with the same tools used to catch animals
#Shanghai #China #Lockdown
 Najmidin Reman on TwitterIt’s used in Xinjiang. He’s inspecting the tools when he’s there.
Najmidin Reman on TwitterIt’s used in Xinjiang. He’s inspecting the tools when he’s there. Inty on Twitter中国防疫人员被群殴
Inty on Twitter中国防疫人员被群殴Chinese Communist epidemic prevention officers got beaten by hungry Chinese
#Shanghai #China #Lockdown
 Inty on Twitter中国的封锁:焊接单元门。
Inty on Twitter中国的封锁:焊接单元门。China's lockdown: welding the whole apartment's gate.
#chinalockdown #China #Shanghai
 Inty on Twitter上海徐汇区,算是最发达的区之一,开始要家家贴封条。
Inty on Twitter上海徐汇区,算是最发达的区之一,开始要家家贴封条。(2022/04/10)
Shanghai's Xuhui District, considered one of the most developed districts, began to post seals to each household. Very anti-human and violating all of China's own laws and the world's basic human rights standards
 Inty on TwitterUyghurs faces got sealed by China Government, China Humiliate them and then warn other villagers to not go out. Because they were locked down at home and starving. They went outside for food.
Inty on TwitterUyghurs faces got sealed by China Government, China Humiliate them and then warn other villagers to not go out. Because they were locked down at home and starving. They went outside for food.2年前,维吾尔人疫情期间挨饿出门找吃的,被政府抓住,贴条示众
 Inty on TwitterChina's anti-human Covid prevention policy , locking and blocking off neighborhoods. Fire trucks can't get in when the neighborhood is on fire.
Inty on TwitterChina's anti-human Covid prevention policy , locking and blocking off neighborhoods. Fire trucks can't get in when the neighborhood is on fire.中国反人类防疫,封锁小区。小区着火后,消防车进不来。
#China #Shanghai #Lockdown
 Inty on Twitter
Inty on Twitter 持阴性报告夫妇被强行带至方舱 警员:说你阳性你就是
持阴性报告夫妇被强行带至方舱 警员:说你阳性你就是 Inty on TwitterChina has just reported 27,509 new cases of Wuhan virus. It's a lot less reported and very fake, but it still breaks the single day growth record
Inty on TwitterChina has just reported 27,509 new cases of Wuhan virus. It's a lot less reported and very fake, but it still breaks the single day growth record中国刚刚报告27509个新的武汉病毒病例。虽然少报很多,很假,但仍然打破了单日增长纪录
 Inty on Twitter中国2人患重病后检测出H5N6禽流感阳性
Inty on Twitter中国2人患重病后检测出H5N6禽流感阳性China reports 2 new human cases of H5N6 bird flu
 China reports 2 new human cases of H5N6 bird flu
China reports 2 new human cases of H5N6 bird flu
不覺得中國人的死很可憐了
 Inty on TwitterChina's anti-human epidemic control is causing more and more Chinese to commit suicide
Inty on TwitterChina's anti-human epidemic control is causing more and more Chinese to commit suicide
中国的反人类疫情控制,让越来越多的中国人自杀
 Inty on TwitterDue to the pandemic lockdown in China, this Chinese man couldn't pay his mortgage and committed suicide
Inty on TwitterDue to the pandemic lockdown in China, this Chinese man couldn't pay his mortgage and committed suicide
由于疫情封锁,这个中国人无法支付他的房贷而自杀了
 Inty on TwitterChina's anti-human epidemic control is causing more and more Chinese to commit suicide
Inty on TwitterChina's anti-human epidemic control is causing more and more Chinese to commit suicide中国的反人类疫情控制,让越来越多的中国人自杀
 Inty on TwitterDue to the pandemic lockdown in China, this Chinese man couldn't pay his mortgage and committed suicide
Inty on TwitterDue to the pandemic lockdown in China, this Chinese man couldn't pay his mortgage and committed suicide由于疫情封锁,这个中国人无法支付他的房贷而自杀了
 Inty on TwitterElderly Chinese woman living alone, her home got sealed by the Chinese Communist Government's so-called pandemic lockdown, hanged herself.
Inty on TwitterElderly Chinese woman living alone, her home got sealed by the Chinese Communist Government's so-called pandemic lockdown, hanged herself.独居的中国老太太因中共政府的所谓疫情封锁而上吊自杀。
 Inty on Twitter(Warning! The video is extremely cruel !)
Inty on Twitter(Warning! The video is extremely cruel !)In Communist China, they are doing this every day.
They think killing pets will stop the spread of Wuhan virus.
(警告!该视频极其残忍!)
在中国,每天都在这样做。他们认为杀死宠物可以阻止武汉病毒的传播
 Inty on Twitter在中国,他们每天都在这样做。
Inty on Twitter在中国,他们每天都在这样做。他们认为杀死宠物可以阻止武汉病毒的传播。
In Communist China, they are doing this every day.
They think killing pets will stop the spread of Wuhan virus.
 Inty on TwitterIn Shanghai lockdown , The owner of the house was forcedly taken to isolation in the middle of the night and the epidemic prevention officer broke into the house and trying to kill three dogs . These dogs are screaming so sadly.
Inty on TwitterIn Shanghai lockdown , The owner of the house was forcedly taken to isolation in the middle of the night and the epidemic prevention officer broke into the house and trying to kill three dogs . These dogs are screaming so sadly.#Shanghai #Lockdown
 Inty on Twitter中国的上海等地人民没东西吃,但是与此同时中国送古巴5000多吨大米和其他物资。
Inty on Twitter中国的上海等地人民没东西吃,但是与此同时中国送古巴5000多吨大米和其他物资。中共眼里,古巴人都比上海人高贵了😂
 木星 on Twitter你个傻逼,上海不是没东西,是配送有问题,你他妈的在国外待的脑子坏掉了
木星 on Twitter你个傻逼,上海不是没东西,是配送有问题,你他妈的在国外待的脑子坏掉了 Inty on Twitter看这个五毛急了😂
Inty on Twitter看这个五毛急了😂中共都可以按时把5000多吨大米配送到古巴,为什么在上海出问题。
中共永远伟大,光明,正确,你这五毛居然敢指责中共。😄
 大搶糧!全球逾5成糧食儲備流入中國 - 自由財經
大搶糧!全球逾5成糧食儲備流入中國 - 自由財經  Inty on Twitter2022/04/10, a fire broke out in Baoshan District, Shanghai, and the Epidemic prevention goods were burned! The Communist leaders who sold the goods can sleep in peace now!
Inty on Twitter2022/04/10, a fire broke out in Baoshan District, Shanghai, and the Epidemic prevention goods were burned! The Communist leaders who sold the goods can sleep in peace now! 上海宝山区发生火灾,抗疫物资被烧毁。倒卖物资的领导可以安心睡觉了。
#Shanghai
 Inty on TwitterThe Chinese forced in isolation camps sing the praises of the Communists with waving red communist China flags
Inty on TwitterThe Chinese forced in isolation camps sing the praises of the Communists with waving red communist China flags被强制关在隔离集中营里的中国人挥舞着红色的共产中国旗帜为共产党人唱赞歌
#Shanghai #lockdown
 Inty on TwitterThis is a scene from Guangzhou, China, where people are testing the Wuhan virus. Is this fighting the pandemic or spreading it?
Inty on TwitterThis is a scene from Guangzhou, China, where people are testing the Wuhan virus. Is this fighting the pandemic or spreading it?这是中国广州的一个场景,人们正在测试武汉病毒。这是在防疫还是在传播它?
#China #Guangzhou
 Inty on TwitterIn the name of the Wuhan virus, the Chinese Communists put #Shanghai under a brutal lockdown. Looting and Riots happening in Shanghai
Inty on TwitterIn the name of the Wuhan virus, the Chinese Communists put #Shanghai under a brutal lockdown. Looting and Riots happening in Shanghai借武汉病毒的名义,中共让上海陷入残酷的封锁状态。抢劫和骚乱在上海发生
04/12
 Inty on Twitter突发新闻: 由于中国武汉病毒案例激增和中国的残酷封城措施的影响,美国命令所有在上海的非必要政府工作人员离开。
Inty on Twitter突发新闻: 由于中国武汉病毒案例激增和中国的残酷封城措施的影响,美国命令所有在上海的非必要政府工作人员离开。
Breaking : The U.S. has ordered all non-essential government workers in Shanghai to leave due to a spike in Wuhan Virus Cases and China's brutal lockdown policy
 Inty on Twitter突发新闻: 由于中国武汉病毒案例激增和中国的残酷封城措施的影响,美国命令所有在上海的非必要政府工作人员离开。
Inty on Twitter突发新闻: 由于中国武汉病毒案例激增和中国的残酷封城措施的影响,美国命令所有在上海的非必要政府工作人员离开。Breaking : The U.S. has ordered all non-essential government workers in Shanghai to leave due to a spike in Wuhan Virus Cases and China's brutal lockdown policy
 Inty on TwitterA #Shanghai mother's desperate plea
Inty on TwitterA #Shanghai mother's desperate pleaa mother in Shanghai went door-to-door in the locked unit and ask for help. She just wanted to find fever medicine for her child. She was not allowed to go outside.
上海一母亲在小区内逐户拍门求助,只是想给孩子吃退烧药。
 Inty on TwitterChina's anti-human pandemic prevention policy is driving this African living in China crazy
Inty on TwitterChina's anti-human pandemic prevention policy is driving this African living in China crazy中国的反人类防疫政策,快把这位居住在中国的非洲人逼疯了
 新台灣國防軍事網 on Twitter
新台灣國防軍事網 on Twitter 才大讚上海封控措施 中國證券高層病發求救無門死家中 - 國際 - 自由時報電子報中國太平洋證券總裁助理韋桂國日前大讚中國上海進駐解放軍堅持封控?諷刺的是沒想到數天後韋桂國腦溢血,卻因封控求救未果喪命。更諷刺的是韋桂國還曾說「帶灣灣回家時,全民戰爭動員也不過如此」 ... 呵呵
才大讚上海封控措施 中國證券高層病發求救無門死家中 - 國際 - 自由時報電子報中國太平洋證券總裁助理韋桂國日前大讚中國上海進駐解放軍堅持封控?諷刺的是沒想到數天後韋桂國腦溢血,卻因封控求救未果喪命。更諷刺的是韋桂國還曾說「帶灣灣回家時,全民戰爭動員也不過如此」 ... 呵呵消息一出引發中國網友熱議,不少人譏諷「自己成了最低成本」、「為自己追求的東西付出生命,值了」、「我就佩服這種言行一致,用實際行動支持的」。
 Inty on Twitter仍然有少数人敢于反抗中国的反人类防疫政策。
Inty on Twitter仍然有少数人敢于反抗中国的反人类防疫政策。 Inty on Twitter上海市浦東高行鎮片區區長帶著紅袖標和一幫城管,暴打其它為政府幹活的人。 分贓不均? #ChinaDaily #locddown
Inty on Twitter上海市浦東高行鎮片區區長帶著紅袖標和一幫城管,暴打其它為政府幹活的人。 分贓不均? #ChinaDaily #locddown Inty on Twitter中國新報告了27920 個新的武漢病毒病例, 是有記錄以來最大的單日增長,雖然少報很多,但是依然創造了歷史
Inty on Twitter中國新報告了27920 個新的武漢病毒病例, 是有記錄以來最大的單日增長,雖然少報很多,但是依然創造了歷史
 Inty on Twitter疫情期間的中國功夫 Chinese Kung-Fu during the pandemic
Inty on Twitter疫情期間的中國功夫 Chinese Kung-Fu during the pandemic
 粉红色蜘蛛清除计划🔰🇹🇼🇯🇵🇳🇿🇺🇦 on Twitter央视大翻译 #大翻譯運動
粉红色蜘蛛清除计划🔰🇹🇼🇯🇵🇳🇿🇺🇦 on Twitter央视大翻译 #大翻譯運動 Inty on Twitter
Inty on Twitter Inty on Twitter中国和俄罗斯第一季度的贸易增长了28%,达到382亿美元当量。
Inty on Twitter中国和俄罗斯第一季度的贸易增长了28%,达到382亿美元当量。
 Inty on Twitter中国的官方数据表明: 让人们的家里变成监狱,让人们挨饿并杀死他们的宠物可以阻止武汉病毒的传播。😅
Inty on Twitter中国的官方数据表明: 让人们的家里变成监狱,让人们挨饿并杀死他们的宠物可以阻止武汉病毒的传播。😅Official data from China shows that turning people's homes into prisons, starving people and killing their pets can stop the spread of the Wuhan virus. 😅
 Inty on Twitter上海警察带着警犬非法闯入民宅,将居民抓到隔离集中营中
Inty on Twitter上海警察带着警犬非法闯入民宅,将居民抓到隔离集中营中#Shanghai #chinalockdown
 Inty on Twitter被强制关在家里的中国老妇女唱到:共产党好,共产党是人民的领导,全心全意为人民服务
Inty on Twitter被强制关在家里的中国老妇女唱到:共产党好,共产党是人民的领导,全心全意为人民服务 Inty on Twitter上海人已经有人饿死在家里, 但与此同时中共正在给 #阿富汗 #塔利班 第五批粮食援助。下面是现场
Inty on Twitter上海人已经有人饿死在家里, 但与此同时中共正在给 #阿富汗 #塔利班 第五批粮食援助。下面是现场
 Sabrina Schulze on Twitter上海不缺吃的,主要是没人送
Sabrina Schulze on Twitter上海不缺吃的,主要是没人送 Inty on Twitter中国可以给远在天边的古巴和阿富汗送吃的,上海就一个城市,却没人送 。 你还有什么其它的理由吗😄
Inty on Twitter中国可以给远在天边的古巴和阿富汗送吃的,上海就一个城市,却没人送 。 你还有什么其它的理由吗😄 Inty on Twitter中国五毛言论:上海不缺吃的,只是没人送。下面的视频一样吗?😄
Inty on Twitter中国五毛言论:上海不缺吃的,只是没人送。下面的视频一样吗?😄
04/14
 Inty on Twitter【中国又创造历史】
Inty on Twitter【中国又创造历史】
中国刚刚新报告了 29317 个新的武汉病毒病例,是有记录以来最大的单日增长,虽然少报很多,但是依然创造了历史
 Inty on Twitter江苏与上海交界处,360度无死角瞭望塔严密看守,防止上海人偷渡
Inty on Twitter江苏与上海交界处,360度无死角瞭望塔严密看守,防止上海人偷渡
#Shanghai #chinalockdown
 Inty on Twitter【中国又创造历史】
Inty on Twitter【中国又创造历史】中国刚刚新报告了 29317 个新的武汉病毒病例,是有记录以来最大的单日增长,虽然少报很多,但是依然创造了历史
 Inty on Twitter江苏与上海交界处,360度无死角瞭望塔严密看守,防止上海人偷渡
Inty on Twitter江苏与上海交界处,360度无死角瞭望塔严密看守,防止上海人偷渡#Shanghai #chinalockdown
屍袋體驗營嗎?還以為是甚麼馬拉松現場,人有夠多
 Inty on Twitter广东佛山的中国人正在跑步去covid检测。如果检测结果呈阳性,他们将被会被送入隔离集中营。
Inty on Twitter广东佛山的中国人正在跑步去covid检测。如果检测结果呈阳性,他们将被会被送入隔离集中营。
 Inty on Twitter广东佛山的中国人,Covid测试现场,疯狂拥挤, 疯狂集聚传染
Inty on Twitter广东佛山的中国人,Covid测试现场,疯狂拥挤, 疯狂集聚传染
 Inty on Twitter上海隔离集中营,屋顶在漏水,昨晚大家都睡在塑料袋里
Inty on Twitter上海隔离集中营,屋顶在漏水,昨晚大家都睡在塑料袋里
 Inty on Twitter广东佛山的中国人正在跑步去covid检测。如果检测结果呈阳性,他们将被会被送入隔离集中营。
Inty on Twitter广东佛山的中国人正在跑步去covid检测。如果检测结果呈阳性,他们将被会被送入隔离集中营。 Inty on Twitter广东佛山的中国人,Covid测试现场,疯狂拥挤, 疯狂集聚传染
Inty on Twitter广东佛山的中国人,Covid测试现场,疯狂拥挤, 疯狂集聚传染 Inty on Twitter上海隔离集中营,屋顶在漏水,昨晚大家都睡在塑料袋里
Inty on Twitter上海隔离集中营,屋顶在漏水,昨晚大家都睡在塑料袋里
04/14
 新台灣國防軍事網 on Twitter
新台灣國防軍事網 on Twitter 韭菜不忍了! 上海居民突破封鎖上街抗議 與警方爆發衝突! - 國際 - 自由時報電子報媒體報導中國武漢肺炎疫情惡化,上海宣布封城。中國堅持「動態清零」粗暴防疫、物資匱乏等問題導致民怨四起,而今中國上海民眾不忍了,多個社區居民自行「解封」上街抗議,網路瘋傳武警與民眾衝突影片
韭菜不忍了! 上海居民突破封鎖上街抗議 與警方爆發衝突! - 國際 - 自由時報電子報媒體報導中國武漢肺炎疫情惡化,上海宣布封城。中國堅持「動態清零」粗暴防疫、物資匱乏等問題導致民怨四起,而今中國上海民眾不忍了,多個社區居民自行「解封」上街抗議,網路瘋傳武警與民眾衝突影片
多則消息指出,中國上海浦東新區數個社區居民今天下午一點左右突破封鎖齊聚浦東新區張江鎮香楠路抗議。網傳影片可以看到現場驚人人龍,在街上播放中國國歌、喊口號,還有消息稱甚至有人趁機大喊「打倒習近平,打倒共產黨」 ... XDD
 Inty on Twitter习近平表示,中国必须要坚持清零防疫政策
Inty on Twitter习近平表示,中国必须要坚持清零防疫政策
 新台灣國防軍事網 on Twitter
新台灣國防軍事網 on Twitter 韭菜不忍了! 上海居民突破封鎖上街抗議 與警方爆發衝突! - 國際 - 自由時報電子報媒體報導中國武漢肺炎疫情惡化,上海宣布封城。中國堅持「動態清零」粗暴防疫、物資匱乏等問題導致民怨四起,而今中國上海民眾不忍了,多個社區居民自行「解封」上街抗議,網路瘋傳武警與民眾衝突影片
韭菜不忍了! 上海居民突破封鎖上街抗議 與警方爆發衝突! - 國際 - 自由時報電子報媒體報導中國武漢肺炎疫情惡化,上海宣布封城。中國堅持「動態清零」粗暴防疫、物資匱乏等問題導致民怨四起,而今中國上海民眾不忍了,多個社區居民自行「解封」上街抗議,網路瘋傳武警與民眾衝突影片多則消息指出,中國上海浦東新區數個社區居民今天下午一點左右突破封鎖齊聚浦東新區張江鎮香楠路抗議。網傳影片可以看到現場驚人人龍,在街上播放中國國歌、喊口號,還有消息稱甚至有人趁機大喊「打倒習近平,打倒共產黨」 ... XDD
 Inty on Twitter习近平表示,中国必须要坚持清零防疫政策
Inty on Twitter习近平表示,中国必须要坚持清零防疫政策
 Facebook
Facebook Inty on TwitterShanghai police roughed up citizens who objected to the expropriation of their homes to Covid concentration camps zone.
Inty on TwitterShanghai police roughed up citizens who objected to the expropriation of their homes to Covid concentration camps zone.上海警察粗暴镇压反对征用民居建隔离集中营的市民。
 Inty on Twitter逮捕每一个人
Inty on Twitter逮捕每一个人 #Shanghai #chinalockdown #COVID19
 米毛酷 on Twitter我想问的是那些曾经支持香港警察的上海人,你们现在是否多少懂了一点点香港人抗争的究竟是什么?
米毛酷 on Twitter我想问的是那些曾经支持香港警察的上海人,你们现在是否多少懂了一点点香港人抗争的究竟是什么? 陈秋实 Chen Qiushi on Twitter2019年~我们上海将会取代香港的位置,成为全新的国际金融中心
陈秋实 Chen Qiushi on Twitter2019年~我们上海将会取代香港的位置,成为全新的国际金融中心2022年~上海
 Inty on Twitter解放军正在忙着打上海人
Inty on Twitter解放军正在忙着打上海人 Inty on Twitter安全”的中国又砍小孩子了。。。
Inty on Twitter安全”的中国又砍小孩子了。。。【甘肃男子持刀伤7人 伤者包括5名幼童】
 Inty on Twitter中国的另外一个城市,具有500万人口的山西省省会太原市,也施行反人类的封城了
Inty on Twitter中国的另外一个城市,具有500万人口的山西省省会太原市,也施行反人类的封城了 Inty on Twitter爆炸性新闻: 对政治立场不正确、违反法律法规、违背公序良俗的失德失范人员不再被允许在中国做直播
Inty on Twitter爆炸性新闻: 对政治立场不正确、违反法律法规、违背公序良俗的失德失范人员不再被允许在中国做直播这就是思想罪,没有人能够理解和解释。 以后中国人也许喊麦之前要开始向习近平表示最高的忠诚
 歐洲動態 on TwitterBBC 報導,根據他們的採訪和取得的文件,不少居住護老院的長者感染 #COVID19 後離世,其中一間醫院便有至少27宗這類個案,不可能如上海官方所說,這一波疫情零死亡。
歐洲動態 on TwitterBBC 報導,根據他們的採訪和取得的文件,不少居住護老院的長者感染 #COVID19 後離世,其中一間醫院便有至少27宗這類個案,不可能如上海官方所說,這一波疫情零死亡。但報導也指出,中國對界定是否「武肺死者」的門檻,較其他地方高。
 Covid China: Elderly deaths contradict Shanghai figu...
Covid China: Elderly deaths contradict Shanghai figu...  Inty on Twitter习近平色眯眯的盯着中国女兵。
Inty on Twitter习近平色眯眯的盯着中国女兵。后宫佳丽三千,习包子难怪要想当中国人的终生皇帝。
 Inty on Twitter《习近平与他的情人们》,这本书可以谷歌搜索看看,讲述习包子的淫荡史。
Inty on Twitter《习近平与他的情人们》,这本书可以谷歌搜索看看,讲述习包子的淫荡史。 Inty on Twitter中国的大海也开始传染武汉病毒!?
Inty on Twitter中国的大海也开始传染武汉病毒!?大白在哪里? 快上! 把海水抽干!要不然海风吹过来,你们就会无法完成习近平的清零政策!
 Inty on Twitter疫情之下,辽宁司机开始吃野草了
Inty on Twitter疫情之下,辽宁司机开始吃野草了 《为彻底粉碎美帝国主义的细菌战计划而斗争》(1953年2月24日,中国【人民日报】) - 头条趋势
《为彻底粉碎美帝国主义的细菌战计划而斗争》(1953年2月24日,中国【人民日报】) - 头条趋势 Inty on Twitter上海人要求独立!剪掉并且焚烧中国血旗!
Inty on Twitter上海人要求独立!剪掉并且焚烧中国血旗! Inty on Twitter中国日常:不仅翻墙,还得钻洞
Inty on Twitter中国日常:不仅翻墙,还得钻洞
打人超狠耶
 Inty on Twitter中国金箍棒防疫
Inty on Twitter中国金箍棒防疫
 Inty on Twitter中国金箍棒防疫
Inty on Twitter中国金箍棒防疫
發條漁貓♣wayfer
分享
變態辣椒:
網友爆猛料,副總理配合造假,我覺得這個值得境外勢力媒體公開報導,別你們天天自欺欺人説下面糊弄高層,這明顯是高層知道在作假 变态辣椒RebelPepper on Twitter
变态辣椒RebelPepper on Twitter
上海封城后,外籍教授布鲁斯(化名)与妻子和两个年幼的孩子被困在公寓。他说,封城前买的食物和政府发放的食品实在不足以养活其四口之家。他迫切希望回到自己的国家,但住的楼关了,小区也关了。布鲁斯说,即使愿意买昂贵的机票,从家里到机场的这段路几乎是“不可能的路程”。 “我想回国,但出不了小区”上海封城后的外籍人士众生相
“我想回国,但出不了小区”上海封城后的外籍人士众生相  美国之音中文网 on Twitter
美国之音中文网 on Twitter
網友爆猛料,副總理配合造假,我覺得這個值得境外勢力媒體公開報導,別你們天天自欺欺人説下面糊弄高層,這明顯是高層知道在作假
 变态辣椒RebelPepper on Twitter
变态辣椒RebelPepper on Twitter上海封城后,外籍教授布鲁斯(化名)与妻子和两个年幼的孩子被困在公寓。他说,封城前买的食物和政府发放的食品实在不足以养活其四口之家。他迫切希望回到自己的国家,但住的楼关了,小区也关了。布鲁斯说,即使愿意买昂贵的机票,从家里到机场的这段路几乎是“不可能的路程”。
 “我想回国,但出不了小区”上海封城后的外籍人士众生相
“我想回国,但出不了小区”上海封城后的外籍人士众生相  美国之音中文网 on Twitter
美国之音中文网 on Twitter
發條漁貓♣wayfer
分享
 Tony419c on Twitter上海網路搶菜的情形激烈到有人利用筋膜槍的震動以求自己達到常人無法做到的手指連點
Tony419c on Twitter上海網路搶菜的情形激烈到有人利用筋膜槍的震動以求自己達到常人無法做到的手指連點
發條漁貓♣wayfer
分享
發條漁貓♣wayfer
分享
山西太原发现7例阳性都是快递公司的员工,就把全省邮政、快递业务全停了。以后是不是哪个行业发现阳性病例就停哪个行业?社科院预判今年中国经济增速6.8%,看来封再多大城市、行业都影响不了中国经济,有统计局呢,领导想要多高增速就有多高。  方舟子 on Twitter
方舟子 on Twitter
方舟子 on Twitter
方舟子 on Twitter
發條漁貓♣wayfer
分享
这不是玩笑,方舱医院的病人真的在修建方舱...  Jacobson🌎🌸贴贴BOT on Twitter
Jacobson🌎🌸贴贴BOT on Twitter
 Jacobson🌎🌸贴贴BOT on Twitter
Jacobson🌎🌸贴贴BOT on Twitter
XDDDDDDDD
 Inty on Twitter强国?墙国!抢国!
Inty on Twitter强国?墙国!抢国! Inty on Twitter同济大学!上厕所要预约,上完厕所不让洗手!为了防疫,疫情期间不让洗手!
Inty on Twitter同济大学!上厕所要预约,上完厕所不让洗手!为了防疫,疫情期间不让洗手! Inty on Twitter#本周热读 据知情人士透露,习近平在向政治局常委发表的未公开讲话中明确表示,中国不能放弃严格的动态清零政策,即使这意味着经济增长放缓。
Inty on Twitter#本周热读 据知情人士透露,习近平在向政治局常委发表的未公开讲话中明确表示,中国不能放弃严格的动态清零政策,即使这意味着经济增长放缓。专家说,抗击以前的所有变种病毒就像扑灭森林大火,是可以做到的;但奥密克戎就像风,你怎么能止住风呢?
 上海奥密克戎疫情让习近平陷入两难
上海奥密克戎疫情让习近平陷入两难 Inty on Twitter最新消息:由于全球谴责中国武汉病毒数据造假,今天迫于压力,中国报告上海有三人因为病毒死亡。
Inty on Twitter最新消息:由于全球谴责中国武汉病毒数据造假,今天迫于压力,中国报告上海有三人因为病毒死亡。
 Inty on Twitter调查显示,截至周一,中国有45个城市实施了全面或部分封控,这些城市的人口占中国总人口的四分之一以上,其经济产值占中国GDP的40%左右。
Inty on Twitter调查显示,截至周一,中国有45个城市实施了全面或部分封控,这些城市的人口占中国总人口的四分之一以上,其经济产值占中国GDP的40%左右。“他们对抗疫情、决心要把新冠清零的意志十分强大,”传染病专家说。“但我认为要清除奥密克戎是个白日梦。”
 抗疫封控从上海扩展至国内其他城市
抗疫封控从上海扩展至国内其他城市  Inty on Twitter上海政府要求生产合作社加大生产绿菜
Inty on Twitter上海政府要求生产合作社加大生产绿菜
 路透社:上海官方下令4/20實現疫情社會面清零 | 兩岸 | 中央社 CNA上海全死光就可以
路透社:上海官方下令4/20實現疫情社會面清零 | 兩岸 | 中央社 CNA上海全死光就可以 新台灣《政論交流》 on Twitter
新台灣《政論交流》 on Twitter 中國副總理被爆料 視察上海疫情竟躲大樓頂擺拍作秀 - 國際 - 自由時報電子報近日中國國務院副總理孫春蘭也透過官媒宣稱到上海老舊社區了解疫情,結果卻被發現,根本是躲在一棟大樓樓頂聽簡報擺拍。
中國副總理被爆料 視察上海疫情竟躲大樓頂擺拍作秀 - 國際 - 自由時報電子報近日中國國務院副總理孫春蘭也透過官媒宣稱到上海老舊社區了解疫情,結果卻被發現,根本是躲在一棟大樓樓頂聽簡報擺拍。 陸製Omicron二代滅活疫苗將在港臨床研究 | 兩岸 | 中央社 CNA
陸製Omicron二代滅活疫苗將在港臨床研究 | 兩岸 | 中央社 CNA  Inty on Twitter一位上海创业者称,自己已经开始考虑移民新加坡。他表示,越来越多的精英阶层将开始重新评估他们与上海和中国的关系。
Inty on Twitter一位上海创业者称,自己已经开始考虑移民新加坡。他表示,越来越多的精英阶层将开始重新评估他们与上海和中国的关系。即使那些没想过离开的人也表示,一些经济和心理创伤恐怕会挥之不去,对中国政府的不满情绪也会无法排解。
 上海民众对封锁措施愈加愤怒
上海民众对封锁措施愈加愤怒 中国学者:中国人口今年或出现负增长
中国学者:中国人口今年或出现负增长  Inty on Twitter虽然我们已减少了我们驻上海总领事馆的人员规模,我们仍然保持业务开放,并留有一群强有力的员工。美国驻华使团有超过80人加班加点地工作,为封城下的美国公民提供帮助。我们全天候都在。如需帮助,拨打电话+(86)(10) 8531-4000。
Inty on Twitter虽然我们已减少了我们驻上海总领事馆的人员规模,我们仍然保持业务开放,并留有一群强有力的员工。美国驻华使团有超过80人加班加点地工作,为封城下的美国公民提供帮助。我们全天候都在。如需帮助,拨打电话+(86)(10) 8531-4000。  Ambassador Nicholas Burns on Twitter
Ambassador Nicholas Burns on Twitter Inty on Twitter为迎接二十大习近平连任,中共誓将“清零”防疫进行到底
Inty on Twitter为迎接二十大习近平连任,中共誓将“清零”防疫进行到底  为迎接二十大习近平连任,中共誓将“清零”防疫进行到底
为迎接二十大习近平连任,中共誓将“清零”防疫进行到底 Inty on Twitter
Inty on Twitter 中国国家卫健委主任:反对“病毒共存”等错误思想,迎接二十大胜利召开
中国国家卫健委主任:反对“病毒共存”等错误思想,迎接二十大胜利召开  Inty on Twitter由于新冠检测结果呈阳性,住在上海的乌克兰人Jane Polubotko经历了近三周的强制隔离,她说这段经历让自己感觉像是一个“新冠罪犯”。
Inty on Twitter由于新冠检测结果呈阳性,住在上海的乌克兰人Jane Polubotko经历了近三周的强制隔离,她说这段经历让自己感觉像是一个“新冠罪犯”。 上海方舱医院亲历者:不能洗澡,24小时灯火通明
上海方舱医院亲历者:不能洗澡,24小时灯火通明 4/19 一個台灣人的上海方艙隔離日記
4/19 一個台灣人的上海方艙隔離日記 Inty on Twitter上海复旦大学毕业的李敏告诉自由亚洲电台:“不仅仅是上海,中国最好的国际学校教师都走了,他们还发了一封信。说他们是一所有百多年历史的外国学校,封城短期之内无望解封,大量老师辞职。在上海保证不了他们正常的吃喝。”#上海封城
Inty on Twitter上海复旦大学毕业的李敏告诉自由亚洲电台:“不仅仅是上海,中国最好的国际学校教师都走了,他们还发了一封信。说他们是一所有百多年历史的外国学校,封城短期之内无望解封,大量老师辞职。在上海保证不了他们正常的吃喝。”#上海封城  上海封城 国际学校关闭 日、韩总领馆致函上海市政府及复旦大学
上海封城 国际学校关闭 日、韩总领馆致函上海市政府及复旦大学 Inty on Twitter上海韩国留学生会会长金成俊(音)表示:“每天每天都像战争一样,没想到封锁会持续这么长时间,生活必需品准备严重不足。”金成俊还表示,很多留学生精神压力很大,最让人崩溃的是不知道什么时候解除封锁。#上海封控
Inty on Twitter上海韩国留学生会会长金成俊(音)表示:“每天每天都像战争一样,没想到封锁会持续这么长时间,生活必需品准备严重不足。”金成俊还表示,很多留学生精神压力很大,最让人崩溃的是不知道什么时候解除封锁。#上海封控  上海封控,在沪韩国留学生恐慌挨饿受困
上海封控,在沪韩国留学生恐慌挨饿受困  Phil 佟 on Twitter三年大飢荒時,醫生開具的死亡證明不但不能寫餓死,連長期營養不良字樣都不許出現。
Phil 佟 on Twitter三年大飢荒時,醫生開具的死亡證明不但不能寫餓死,連長期營養不良字樣都不許出現。 Inty on Twitter迫于外界质疑数据的压力,今天上海又报告7例新的武汉病毒死亡病例,是有记录以来最大的单日增长
Inty on Twitter迫于外界质疑数据的压力,今天上海又报告7例新的武汉病毒死亡病例,是有记录以来最大的单日增长 Inty on Twitter
Inty on Twitter 微博封杀中国国歌歌词 西方观察人士直呼“太虚幻了”
微博封杀中国国歌歌词 西方观察人士直呼“太虚幻了” 上海民怨「起來!不願做奴隸的人們」 中國傳封殺國歌歌詞 - 國際 - 自由時報電子報
上海民怨「起來!不願做奴隸的人們」 中國傳封殺國歌歌詞 - 國際 - 自由時報電子報 林瑞陽張庭涉傳銷遭中國調查 陸媒:上海市77億元房產查封 | 兩岸 | 中央社 CNA
林瑞陽張庭涉傳銷遭中國調查 陸媒:上海市77億元房產查封 | 兩岸 | 中央社 CNA
只能微笑,有夠迴力鏢的 Inty on Twitter4月18日晚,上海街头出现了这样的标语。
Inty on Twitter4月18日晚,上海街头出现了这样的标语。




 Inty on Twitter上次钻狗洞的中国人被抓,今天翻墙的被抓
Inty on Twitter上次钻狗洞的中国人被抓,今天翻墙的被抓
 Inty on Twitter这个五毛粉红说他“自愿”把自己的家变成监狱。😂 Twitter
Inty on Twitter这个五毛粉红说他“自愿”把自己的家变成监狱。😂 Twitter
 Inty on Twitter4月18日晚,上海街头出现了这样的标语。
Inty on Twitter4月18日晚,上海街头出现了这样的标语。 Inty on Twitter上次钻狗洞的中国人被抓,今天翻墙的被抓
Inty on Twitter上次钻狗洞的中国人被抓,今天翻墙的被抓 Inty on Twitter这个五毛粉红说他“自愿”把自己的家变成监狱。😂 Twitter
Inty on Twitter这个五毛粉红说他“自愿”把自己的家变成监狱。😂 Twitter  Inty on Twitter坐标:上海宝山区,居民买不到吃的,饿的居民都集体开始敲盆抗议,警察到场抓人
Inty on Twitter坐标:上海宝山区,居民买不到吃的,饿的居民都集体开始敲盆抗议,警察到场抓人 Inty on Twitter中国老粉红烧香祈祷希望把病毒撵到美国,当地把这宣传为正能量
Inty on Twitter中国老粉红烧香祈祷希望把病毒撵到美国,当地把这宣传为正能量 晨光 on Twitter還有這個是要攆到美國日本的,還是中國經濟最最發達的江浙省份地區的人!
晨光 on Twitter還有這個是要攆到美國日本的,還是中國經濟最最發達的江浙省份地區的人!
 Inty on Twitter广东省湛江市男子梁某,因在推特发布了两万余条推文,其中包括“辱华、丑化及侮辱国家领导人、诋毁社会主义制度、分裂国家等虚假负面信息”,于2020年9月以寻衅滋事罪刑拘,同年12月被提起公诉,检方建议量刑三年,实际判决未知。 (来自SpeechFreedomCN)
Inty on Twitter广东省湛江市男子梁某,因在推特发布了两万余条推文,其中包括“辱华、丑化及侮辱国家领导人、诋毁社会主义制度、分裂国家等虚假负面信息”,于2020年9月以寻衅滋事罪刑拘,同年12月被提起公诉,检方建议量刑三年,实际判决未知。 (来自SpeechFreedomCN)用的酷派手机和电脑。裸奔。。
 James Hsieh on Twitter上海下令0420要清零,只剩兩天,可能嗎?
James Hsieh on Twitter上海下令0420要清零,只剩兩天,可能嗎?上次西安也是限某個時間要清零,結果時間到的真的清零了
他的詳細作法是,在期限到的那天,全西安市再度篩檢
然後確診或疑似確診的,全都趕出城外的超級大方艙
就真的清零了
中國真的是太厲害了
 James Hsieh on Twitter
James Hsieh on Twitter Inty on Twitter评论|#刘青:#大翻译运动 令中共狂躁难安 TGTM_Official
Inty on Twitter评论|#刘青:#大翻译运动 令中共狂躁难安 TGTM_Official
 评论|刘青:大翻译运动令中共狂躁难安
评论|刘青:大翻译运动令中共狂躁难安  Inty on Twitter中国:根据美国疾控中心提示,在2022年5月11日之前离开上海前往美国的美国公民、美国国民、合法永久居民及其配偶和子女无需在登机前提供COVID-19检测证明或康复文件。更多信息:Health Alert Shanghai: Temporary Waiver of pre-fligh...
Inty on Twitter中国:根据美国疾控中心提示,在2022年5月11日之前离开上海前往美国的美国公民、美国国民、合法永久居民及其配偶和子女无需在登机前提供COVID-19检测证明或康复文件。更多信息:Health Alert Shanghai: Temporary Waiver of pre-fligh...  Travel - State Dept on Twitter
Travel - State Dept on Twitter 上海預計20日社會面清零 新增7人染疫亡 | 兩岸 | 中央社 CNA
上海預計20日社會面清零 新增7人染疫亡 | 兩岸 | 中央社 CNA 上海社會面清零不等於解封 長春煙台有前例 | 兩岸 | 中央社 CNA
上海社會面清零不等於解封 長春煙台有前例 | 兩岸 | 中央社 CNA 廣州密切接觸者逾1.7萬人 官方徵集安置房做隔離點 | 兩岸 | 中央社 CNA
廣州密切接觸者逾1.7萬人 官方徵集安置房做隔離點 | 兩岸 | 中央社 CNA 上海力拚社會面清零 中國新增病例數仍破2萬例 | 兩岸 | 中央社 CNA
上海力拚社會面清零 中國新增病例數仍破2萬例 | 兩岸 | 中央社 CNA 经济学家警告称中国经济面临严重的危险信号
经济学家警告称中国经济面临严重的危险信号  James Hsieh on Twitter上海封城一個月了
James Hsieh on Twitter上海封城一個月了這代表你過去一個月到處爽吃,到處爽玩的自由生活,上海人通通都沒有
而且接下來廣東蘇州吉林等各大城市也都即將沒有
有人說民主不能當飯吃
但極權更慘
你連出門吃個飯都不行
 李家超成特首惟一候选人 学者称标志香港成威权统治 迈列宁式集中制
李家超成特首惟一候选人 学者称标志香港成威权统治 迈列宁式集中制 恐惧、无助、期待、忍耐 上海封城折射人性善恶
恐惧、无助、期待、忍耐 上海封城折射人性善恶  Inty on Twitter
【孙春兰走到地面即遇上诉苦民众】
Inty on Twitter
【孙春兰走到地面即遇上诉苦民众】4月18日,中国副总理孙春兰从前一天的天台走到地面,到了黄浦区老西门视察,正好碰到了一位老人发病,喊着要到医院就医。
#孙春兰 #天台视察 #上海 #民怨 (来自RFA_Chinese)
 赛先生的小迷弟🇺🇦 on Twitter刚跟上海一位体制内的朋友聊天。他的岗位特殊,属于上海市委食品安全体系,并且参与了上海物资保障供应的工作。但是魔幻的事情发生了,他作为小区的团购团长之一,被人威胁了。因为他是确确实实的体制内人士,能拿到相对正常的供应价格,还参与了上海多个小区政府物资的供应发放,结果被小区居委会排挤
赛先生的小迷弟🇺🇦 on Twitter刚跟上海一位体制内的朋友聊天。他的岗位特殊,属于上海市委食品安全体系,并且参与了上海物资保障供应的工作。但是魔幻的事情发生了,他作为小区的团购团长之一,被人威胁了。因为他是确确实实的体制内人士,能拿到相对正常的供应价格,还参与了上海多个小区政府物资的供应发放,结果被小区居委会排挤他亮出自己身份才免于被责难,之后仍被举报没有给小区居委会报备。关键是最后小区居委会报备几层之后最后是报备到到像他这样的人那。他是实际进行监督管理的中层干部啊,上海的魔幻也超出了他的想象。
 上海拚社會面清零 隔離區外新增確診仍逾900例 | 兩岸 | 中央社 CNA
上海拚社會面清零 隔離區外新增確診仍逾900例 | 兩岸 | 中央社 CNA Inty on Twitter来自上海卢湾区、现居美国中西部的新闻学研究者黄先生非常愤怒:“关于 #吴尊友 这篇文章,我觉得这个人简直就是人性已经没有了,良心完全是没有的。他作为疾控中心的首席专家,他居然会说出这些根本不符合常识的话。” #动态清零
Inty on Twitter来自上海卢湾区、现居美国中西部的新闻学研究者黄先生非常愤怒:“关于 #吴尊友 这篇文章,我觉得这个人简直就是人性已经没有了,良心完全是没有的。他作为疾控中心的首席专家,他居然会说出这些根本不符合常识的话。” #动态清零  中国疾控专家吴尊友发文赞动态清零 引发激烈争议
中国疾控专家吴尊友发文赞动态清零 引发激烈争议 Inty on Twitter上海方舱集中营,逼人跳楼
Inty on Twitter上海方舱集中营,逼人跳楼
 Inty on Twitter【上海出现饥荒,菜农疏菜却卖不出去】
Inty on Twitter【上海出现饥荒,菜农疏菜却卖不出去】连日来处于封城状态的上海,无数民众处于饥荒状态,但在上海市青浦区,农户门的农作物都卖不出去,而且快要腐烂了。
有网民批评,一场疫情,证明了市场机制退场后、尽显举国体制的彻底失败。
#上海封城 #大饥荒 #人祸 (来自RFA_Chinese)
 Inty on Twitter【上海地方官成发洩对象】
Inty on Twitter【上海地方官成发洩对象】上海人温饱问题得不到解决,民怨无处宣洩。居民每当碰到前来巡视的地方干部,都要破口大骂,地方干部现在就成了上海人的发洩对象。 (上海网民提供视频)
#上海封城 #干部 #民怨 (来自RFA_Chinese)
 新闻调查 on Twitter这个视频火了,很多人在转
新闻调查 on Twitter这个视频火了,很多人在转 新闻调查 on Twitter财经冷眼:连花清瘟引公愤,背后博弈级别!孙春兰视察造假穿帮,新闻联播造假翻车! 中国无解的循环!(20220418第775期)
新闻调查 on Twitter财经冷眼:连花清瘟引公愤,背后博弈级别!孙春兰视察造假穿帮,新闻联播造假翻车! 中国无解的循环!(20220418第775期)  财经冷眼:连花清瘟引公愤,背后博弈级别!孙春兰视察造假穿帮,新闻联播造假翻车! 中国无解的循环!(202...
财经冷眼:连花清瘟引公愤,背后博弈级别!孙春兰视察造假穿帮,新闻联播造假翻车! 中国无解的循环!(202... 新闻调查 on Twitter“同一个app,不同的等级”,墙国已做到。
新闻调查 on Twitter“同一个app,不同的等级”,墙国已做到。上海政府指定的保供渠道,做在大家熟悉的app内部。前端完全无异。大家都是用户,一般人看到的是样样售完、暂缺。
但如果你的手机号在他们名单上,你就能刷出鸡鸭鱼肉蛋奶样样有,承诺次日达当天都可到
这是电子渠道特供!也是很多上海特权人说的“物资供应充足”
 Inty on Twitter上海黑警们,在封城状态下的空马路,发生严重车祸,生死未卜
Inty on Twitter上海黑警们,在封城状态下的空马路,发生严重车祸,生死未卜 Inty on Twitter中国太墙了,没有无家可归者
Inty on Twitter中国太墙了,没有无家可归者 Inty on Twitter谁说中国没有“自由”,美国人可以自由的睡大街;中国人也可以,中国人还可以自由地吃草。
Inty on Twitter谁说中国没有“自由”,美国人可以自由的睡大街;中国人也可以,中国人还可以自由地吃草。 Inty on Twitter网友留言:“央视新闻:美国沪利福尼亚州浦山矶市人们无家可归”
Inty on Twitter网友留言:“央视新闻:美国沪利福尼亚州浦山矶市人们无家可归”
 Inty on Twitter贵阳女子赵某,因在推特发布了大量“诽谤中国国家领导人的照片、视频及言论”,于2018年5月被以寻衅滋事罪刑拘,两年后提起公诉。检方建议量刑一年,实际判决未知。 (来自SpeechFreedomCN)
Inty on Twitter贵阳女子赵某,因在推特发布了大量“诽谤中国国家领导人的照片、视频及言论”,于2018年5月被以寻衅滋事罪刑拘,两年后提起公诉。检方建议量刑一年,实际判决未知。 (来自SpeechFreedomCN)
 Inty on Twitter友情提示
Inty on Twitter友情提示 Inty on Twitter中国每天都在各个海外平台上大规模的进行舆论超限战,用谎言和渗透。
Inty on Twitter中国每天都在各个海外平台上大规模的进行舆论超限战,用谎言和渗透。乌泱乌泱的中国五毛粉蛆,机器五毛们试图掩盖中国对维吾尔,哈萨克等突厥民族的反人类罪行。
 Inty on Twitter“阴性的人要转移出去,因为他们小区阳性的人太多。现在反过来,今天把检测阴性的人拉到杭州去,他们那个小区阴性很少,只有两辆公交车拉他们。”
Inty on Twitter“阴性的人要转移出去,因为他们小区阳性的人太多。现在反过来,今天把检测阴性的人拉到杭州去,他们那个小区阴性很少,只有两辆公交车拉他们。”#清零 #上海封控
 "清零"迫在眉睫,上海出现"留阳转阴"
"清零"迫在眉睫,上海出现"留阳转阴" Inty on Twitter上海民調:嚴厲封城讓上海的外國人心生去意 http://
Inty on Twitter上海民調:嚴厲封城讓上海的外國人心生去意 http://  上海民调:严厉封城让上海的外国人心生去意
上海民调:严厉封城让上海的外国人心生去意  大耳朵猫妹 on Twitter我看到了这位的求助,没想到转眼就被人挖出粉红历史了,要素很齐全
大耳朵猫妹 on Twitter我看到了这位的求助,没想到转眼就被人挖出粉红历史了,要素很齐全教员-民主自由假的-赶紧封城-救救我母亲
 Inty on Twitter上海居民的绝望,刚说要解封又要封路了。
Inty on Twitter上海居民的绝望,刚说要解封又要封路了。 上海多个行政区突然封路 居民:刚说解封又要封
上海多个行政区突然封路 居民:刚说解封又要封 Inty on Twitter不說封城了,改說靜態管理😂
Inty on Twitter不說封城了,改說靜態管理😂
【😢「每家都有痛苦故事」 上海人團結反官方宣傳💪】「上海數以百萬計的人——無論老少、貧富、自由派和保守派——似乎被日益高漲的憤怒團結在一起。」CNN的北京分社社長蔣欣(Steven Jiang)這樣寫道。🔥🔥
📰完整文章 「每家都有痛苦故事」上海人反封城空前團結 - 大紀元喔,好可憐喔
「每家都有痛苦故事」上海人反封城空前團結 - 大紀元喔,好可憐喔
📰完整文章
 「每家都有痛苦故事」上海人反封城空前團結 - 大紀元喔,好可憐喔
「每家都有痛苦故事」上海人反封城空前團結 - 大紀元喔,好可憐喔
 Inty on Twitter#CWSJ周四重温 去年,習近平似乎所向無敵。 而現在,他帶領中國遠離資本主義和西方的行動使中國經濟陷入不確定性,並暴露出他對政權的執掌出現了細微裂痕。 據黨內人士透露,一些中共「元老」最近表示,反對習近平打破既定的領導層接班制的意願。
Inty on Twitter#CWSJ周四重温 去年,習近平似乎所向無敵。 而現在,他帶領中國遠離資本主義和西方的行動使中國經濟陷入不確定性,並暴露出他對政權的執掌出現了細微裂痕。 據黨內人士透露,一些中共「元老」最近表示,反對習近平打破既定的領導層接班制的意願。 https://
 The Wall Street Journal - Breaking News, Business, F...
The Wall Street Journal - Breaking News, Business, F...  Inty on Twitter上海人在自己的家(监狱)哀嚎中,快饿死了,想要吃的!
Inty on Twitter上海人在自己的家(监狱)哀嚎中,快饿死了,想要吃的!上海是中国最发达的城市
 Inty on Twitter你們能在抗疾疫情中在中國生活,你們就偷著樂吧
Inty on Twitter你們能在抗疾疫情中在中國生活,你們就偷著樂吧 Inty on Twitter一个抱摔,后脑壳落地;
Inty on Twitter一个抱摔,后脑壳落地;又一个中国人被中国人杀死了。
 Inty on Twitter中国的所谓第一艘航空母舰 #辽宁舰 与这艘被击沉的“#莫斯科号”是同一家造船厂建造的。
Inty on Twitter中国的所谓第一艘航空母舰 #辽宁舰 与这艘被击沉的“#莫斯科号”是同一家造船厂建造的。#纸老虎
 俄海军莫斯科号被击沉 中国辽宁舰也是"纸老虎"?
俄海军莫斯科号被击沉 中国辽宁舰也是"纸老虎"? Inty on Twitter 在新西兰被列为禁药,而在加拿大市面上虽可买到,但加拿大卫生部只将其列为“保健品”,并强调连花清瘟不具备 #新冠 疗效。
Inty on Twitter 在新西兰被列为禁药,而在加拿大市面上虽可买到,但加拿大卫生部只将其列为“保健品”,并强调连花清瘟不具备 #新冠 疗效。 连花清瘟受追捧? 加拿大卫生部:不具新冠疗效
连花清瘟受追捧? 加拿大卫生部:不具新冠疗效 Inty on Twitter
Inty on Twitter 上海民调:半数外国人准备离开 还有四成待定
上海民调:半数外国人准备离开 还有四成待定  变态辣椒RebelPepper on Twitter河南洛陽人趙占勝4月12日自帶上千斤食材物資趕到上海,在街頭支起大鍋為滯留上海的貨車司機免費做飯,只做了五天,期間不斷被驅趕,從浦東航津路被趕走,從金山被趕走,理由是他不環保,最後衹能回到河南。視頻見回帖。
变态辣椒RebelPepper on Twitter河南洛陽人趙占勝4月12日自帶上千斤食材物資趕到上海,在街頭支起大鍋為滯留上海的貨車司機免費做飯,只做了五天,期間不斷被驅趕,從浦東航津路被趕走,從金山被趕走,理由是他不環保,最後衹能回到河南。視頻見回帖。 Inty on Twitter【地方政府防疫措施混乱】
Inty on Twitter【地方政府防疫措施混乱】【货车司机怎么活下去?】
一名货车司机路经河南高速出口,原本打算休息一会,但交警强令他下车隔离十四日,食宿和停车费还要自费。司机欲哭无泪。
#封城
#河南 (来自RFA_Chinese)
 上海频传官方摆拍 "丰衣足食"致民怨迭起
上海频传官方摆拍 "丰衣足食"致民怨迭起 Inty on Twitter习近平制裁中国人
Inty on Twitter习近平制裁中国人
 Inty on Twitter剥夺人身自由,关进监狱,还在唱赞歌。
Inty on Twitter剥夺人身自由,关进监狱,还在唱赞歌。 Inty on Twitter饿一个月,然后发点东西,就开始喊共产党万岁
Inty on Twitter饿一个月,然后发点东西,就开始喊共产党万岁
 Inty on Twitter中国为集中新冠患者所谓“方舱医院”或“集中隔离点”的环境,可谓没有最差,只有更差。一名被隔离的上海妇女发视频投诉,她被送往一方舱医院隔离,里面男女不分,床位之间仅40公分。她说里面更像难民营。
Inty on Twitter中国为集中新冠患者所谓“方舱医院”或“集中隔离点”的环境,可谓没有最差,只有更差。一名被隔离的上海妇女发视频投诉,她被送往一方舱医院隔离,里面男女不分,床位之间仅40公分。她说里面更像难民营。 上海隔离点环境恶劣无隐私 货车司机吃喝如厕驾驶室遇尴尬
上海隔离点环境恶劣无隐私 货车司机吃喝如厕驾驶室遇尴尬  Inty on Twitter最新消息:习近平习包子以100%的支持率,全票当选中共20大代表
Inty on Twitter最新消息:习近平习包子以100%的支持率,全票当选中共20大代表 Inty on Twitter重磅消息:中国义务教育10年来的大改革,2022年开始,所有课程全面加入习近平思想
Inty on Twitter重磅消息:中国义务教育10年来的大改革,2022年开始,所有课程全面加入习近平思想 Inty on Twitter一个普通人做了一个《四月之声》的视频,被无数人不断地接力转载,在朋友圈引发了现象级传播,但也被全网查删。(视频素材来自微信公众号:永远的草莓园)
Inty on Twitter一个普通人做了一个《四月之声》的视频,被无数人不断地接力转载,在朋友圈引发了现象级传播,但也被全网查删。(视频素材来自微信公众号:永远的草莓园) 追随领袖 谁是新一轮疯狂吹捧的操盘手#上海疫情 #四月之声 #上海封城 #中概股
追随领袖 谁是新一轮疯狂吹捧的操盘手#上海疫情 #四月之声 #上海封城 #中概股 苏贞昌:尽管新冠病例增加 台湾不会像上海那样封城為什麼不能把唱雖台灣的都送過去呢
苏贞昌:尽管新冠病例增加 台湾不会像上海那样封城為什麼不能把唱雖台灣的都送過去呢
 Inty on Twitter在中的美国公民请注意:如遇紧急情况,请拨打+(86)(10) 8531-4000,联系所在地区大使馆或总领事馆。还可以在Contact us 网站或者发送邮件到美国驻华大使馆和各领事馆邮箱获取更多信息。
Inty on Twitter在中的美国公民请注意:如遇紧急情况,请拨打+(86)(10) 8531-4000,联系所在地区大使馆或总领事馆。还可以在Contact us 网站或者发送邮件到美国驻华大使馆和各领事馆邮箱获取更多信息。 Inty on Twitter中共首次就党代会征求网络民意 #我为党的二十大建言献策。我们也来搭个顺风车,无须实名,畅所欲言。
Inty on Twitter中共首次就党代会征求网络民意 #我为党的二十大建言献策。我们也来搭个顺风车,无须实名,畅所欲言。https://zpr.io/...
 Inty on Twitter今天,中共上海报告12人因为武汉病毒🦠死亡
Inty on Twitter今天,中共上海报告12人因为武汉病毒🦠死亡 Inty on Twitter响彻上海四月天的 #四月之声 以封城后寂静的上海都市黑白航拍画面为背景,配以低缓、压抑的音乐,其中有多个上海市民缺医少吃、求助无门的音频,上海市政府官员的发言,以及市民与居委会干部、志愿者对话的实录等等。
Inty on Twitter响彻上海四月天的 #四月之声 以封城后寂静的上海都市黑白航拍画面为背景,配以低缓、压抑的音乐,其中有多个上海市民缺医少吃、求助无门的音频,上海市政府官员的发言,以及市民与居委会干部、志愿者对话的实录等等。 现象级传播:响彻上海四月天的《四月之声》
现象级传播:响彻上海四月天的《四月之声》 自由亚洲电台 on Twitter
自由亚洲电台 on Twitter  Inty on Twitter【中概股自美退市风险扩大】
Inty on Twitter【中概股自美退市风险扩大】【再有17家列入「预定摘牌名单」】
 中概股自美退市风险扩大 再有17家列入预定摘牌名单美中金融战再度升温!美国证交会(SEC)周四(21日)公布,新增17间中概股列入「预定摘牌名单」,为3月以来第5批。 (来自RFA_Chinese)
中概股自美退市风险扩大 再有17家列入预定摘牌名单美中金融战再度升温!美国证交会(SEC)周四(21日)公布,新增17间中概股列入「预定摘牌名单」,为3月以来第5批。 (来自RFA_Chinese)过去1年,美国中概股综合指数已经大跌80%左右
 Inty on Twitter重磅消息:中国义务教育10年来的大改革,2022年开始,所有课程全面加入习近平思想
Inty on Twitter重磅消息:中国义务教育10年来的大改革,2022年开始,所有课程全面加入习近平思想 Inty on Twitter连英语,生物等义务教育课程大纲也全面修订,加入习近平思想
Inty on Twitter连英语,生物等义务教育课程大纲也全面修订,加入习近平思想 Inty on Twitter习包子小学没毕业,连中文都不行,但还要求中国人用他的思想学习英语😂
Inty on Twitter习包子小学没毕业,连中文都不行,但还要求中国人用他的思想学习英语😂 Inty on Twitter习近平不仅要害你这一代,也要害你的下一代
Inty on Twitter习近平不仅要害你这一代,也要害你的下一代
 Inty on Twitter中国反人类防疫,中国人被当作畜生一样,消毒。。。
Inty on Twitter中国反人类防疫,中国人被当作畜生一样,消毒。。。 Inty on Twitter三周前,《华尔街日报》报道了上海一家老年护理医院在新冠疫情下未公布的感染与死亡事件。随后,记者通过采访家属和医务人员,再次发掘了这些死亡事件的新细节,揭示出上海的不堪重负。很多家属认为,护理中断是导致他们亲人死亡的第一大原因。
Inty on Twitter三周前,《华尔街日报》报道了上海一家老年护理医院在新冠疫情下未公布的感染与死亡事件。随后,记者通过采访家属和医务人员,再次发掘了这些死亡事件的新细节,揭示出上海的不堪重负。很多家属认为,护理中断是导致他们亲人死亡的第一大原因。 上海老年护理医院新冠死亡病例的新细节揭示该市的不堪重负
上海老年护理医院新冠死亡病例的新细节揭示该市的不堪重负  中共加速金融領域反腐 年內至少14名高層落馬 | 兩岸 | 中央社 CNA
中共加速金融領域反腐 年內至少14名高層落馬 | 兩岸 | 中央社 CNA 《四月之声》被封网民愤怒 张教授被打网民乐翻
《四月之声》被封网民愤怒 张教授被打网民乐翻 美欧联合警告中国:支持俄罗斯需承担后果
美欧联合警告中国:支持俄罗斯需承担后果 Inty on Twitter#本周热读 一位研究中国问题的高级观察人士周一晚间称,中国经济出现了“真正的危险迹象”,甚至可能在本季度陷入停滞。
Inty on Twitter#本周热读 一位研究中国问题的高级观察人士周一晚间称,中国经济出现了“真正的危险迹象”,甚至可能在本季度陷入停滞。 经济学家警告称中国经济面临严重的危险信号
经济学家警告称中国经济面临严重的危险信号  Inty on Twitter上海浦东被非法关押封锁人员,准备拿着中共的血旗,反中共
Inty on Twitter上海浦东被非法关押封锁人员,准备拿着中共的血旗,反中共 Inty on Twitter还以为俄军的导弹击中了上海,原来是封锁关押上海人的小区楼着火了,不知道有多少人死伤
Inty on Twitter还以为俄军的导弹击中了上海,原来是封锁关押上海人的小区楼着火了,不知道有多少人死伤 Inty on Twitter稍早之前,上海浦东新区崂山五村的居民楼是被这样被封锁的。
Inty on Twitter稍早之前,上海浦东新区崂山五村的居民楼是被这样被封锁的。 Inty on Twitter上海徐汇区,中国最发达的区之一,准备用铁丝网和铁板封楼
Inty on Twitter上海徐汇区,中国最发达的区之一,准备用铁丝网和铁板封楼 Inty on Twitter习近平下死命令,上海一定要清零,于是今天开始上海人变成铁链女,铁窗男
Inty on Twitter习近平下死命令,上海一定要清零,于是今天开始上海人变成铁链女,铁窗男 Inty on Twitter
上海,肉身翻墙,肉身钻洞
Inty on Twitter
上海,肉身翻墙,肉身钻洞
發條漁貓♣wayfer
分享
 王局志安 on Twitter昨晚朋友圈还有个华春莹的视频,今天基本也被删了。不明白,为啥华春莹说的话也成敏感词了?华春莹好像说:14亿人都可以自由发表自己的看法。这话难道是假的?
王局志安 on Twitter昨晚朋友圈还有个华春莹的视频,今天基本也被删了。不明白,为啥华春莹说的话也成敏感词了?华春莹好像说:14亿人都可以自由发表自己的看法。这话难道是假的?推特用戶雪民:
1. 共产党说要为人民服务
= 人民丧失了为自己服务的权利,因为只有共产党才能服务人民
2. 人民当家作主
= 人民自己做主,应当自己为自己服务,不能依靠别人。
所有,这两点合在一起,便成了:
人民应当自己服务自己,但又不能自己服务自己。所有,没有人会为人民服务。
發條漁貓♣wayfer
分享
 中国雾霾伤害远超病毒,专家呼吁提高空气质量标准
中国雾霾伤害远超病毒,专家呼吁提高空气质量标准 Inty on Twitter上海居民受到铁丝封锁的迫害和人格尊严受到奇耻大辱,于是拆除街上的铁丝网
Inty on Twitter上海居民受到铁丝封锁的迫害和人格尊严受到奇耻大辱,于是拆除街上的铁丝网 Inty on Twitter安装铁丝网的速度快于拆的速度
Inty on Twitter安装铁丝网的速度快于拆的速度 Inty on Twitter另外一批上海人在笼子里跳广场舞
Inty on Twitter另外一批上海人在笼子里跳广场舞上海加油www
 Inty on Twitter#青海 27岁女在 #隔离酒店 堕楼身亡 曾致电哥哥:怕他们说我得病
Inty on Twitter#青海 27岁女在 #隔离酒店 堕楼身亡 曾致电哥哥:怕他们说我得病  青海27岁女在隔离酒店堕楼身亡 曾致电哥哥:怕他们说我得病
青海27岁女在隔离酒店堕楼身亡 曾致电哥哥:怕他们说我得病 上海人权律师因发表致上海市委书记和市长公开信遭警方扣押
上海人权律师因发表致上海市委书记和市长公开信遭警方扣押 上海港货物堆积 德国制造商着急
上海港货物堆积 德国制造商着急 封得越凶转得越猛的“四月之声”
封得越凶转得越猛的“四月之声” 谁害怕四月之声
谁害怕四月之声 Inty on Twitter这首歌,非常应景现在中国的反人类防疫
Inty on Twitter这首歌,非常应景现在中国的反人类防疫
 Inty on Twitter上海学生疯了?还是自救的战术?
Inty on Twitter上海学生疯了?还是自救的战术? Inty on Twitter中国反人类防疫,妈妈下楼去抢菜,没顾上孩子,孩子从6楼掉下来了
Inty on Twitter中国反人类防疫,妈妈下楼去抢菜,没顾上孩子,孩子从6楼掉下来了 德国《经济周刊》:上海封城措施凶蛮残忍
德国《经济周刊》:上海封城措施凶蛮残忍 Inty on Twitter墙国上海人,肉身翻墙跟橋
Inty on Twitter墙国上海人,肉身翻墙跟橋
 Inty on Twitter中共上海报告说昨日武汉病毒造成39人死亡。 统计数字上创造历史
Inty on Twitter中共上海报告说昨日武汉病毒造成39人死亡。 统计数字上创造历史 Inty on Twitter过去5天,人民币兑美金贬值超2%以上,幅度近年来罕见。
Inty on Twitter过去5天,人民币兑美金贬值超2%以上,幅度近年来罕见。 Inty on Twitter【“中国人最没有恐惧的7个星期” - 吴仁华口述“六四”史】
Inty on Twitter【“中国人最没有恐惧的7个星期” - 吴仁华口述“六四”史】1989年4月23日 北京高自联成立 https://rfa.org/...
04/25
 Inty on Twitter
Inty on Twitter 上海当局出新招 搭建两米围栏封楼封小区封街道 引发市民愈加不满
上海当局出新招 搭建两米围栏封楼封小区封街道 引发市民愈加不满 网民敦促中宣部制定“个人崇拜的底线”
网民敦促中宣部制定“个人崇拜的底线” Inty on Twitter昨天中共辟谣说相信政府,北京货源充足。
Inty on Twitter昨天中共辟谣说相信政府,北京货源充足。
但是,今天中国央视超级大五毛—刘欣居然翻墙发推,发布自己在北京囤货的画面。
连大五毛都不相信中共的话,反党反政府哈。 Inty on Twitter
昨天中共辟谣说相信政府,北京货源充足。
Inty on Twitter
昨天中共辟谣说相信政府,北京货源充足。
但是,今天中国央视超级大五毛—刘欣居然翻墙发推,发布自己在北京囤货的画面。
连大五毛都不相信中共的话,反党反政府哈。
这种人就是中国最坏最邪恶的一批人。 @kentan - 新聞調查: 北京央視粉紅女主播囤糧! 不相信黨中央物資豐富?
@kentan - 新聞調查: 北京央視粉紅女主播囤糧! 不相信黨中央物資豐富?
 Inty on Twitter
Inty on Twitter 上海当局出新招 搭建两米围栏封楼封小区封街道 引发市民愈加不满
上海当局出新招 搭建两米围栏封楼封小区封街道 引发市民愈加不满 网民敦促中宣部制定“个人崇拜的底线”
网民敦促中宣部制定“个人崇拜的底线” Inty on Twitter昨天中共辟谣说相信政府,北京货源充足。
Inty on Twitter昨天中共辟谣说相信政府,北京货源充足。但是,今天中国央视超级大五毛—刘欣居然翻墙发推,发布自己在北京囤货的画面。
连大五毛都不相信中共的话,反党反政府哈。
 Inty on Twitter
昨天中共辟谣说相信政府,北京货源充足。
Inty on Twitter
昨天中共辟谣说相信政府,北京货源充足。但是,今天中国央视超级大五毛—刘欣居然翻墙发推,发布自己在北京囤货的画面。
连大五毛都不相信中共的话,反党反政府哈。
这种人就是中国最坏最邪恶的一批人。
 上海55日 | 北京55日之偷着乐版 | 这是我的四月之声 | 说真话的徐某人
上海55日 | 北京55日之偷着乐版 | 这是我的四月之声 | 说真话的徐某人 Inty on Twitter杭州人手拿“良民证”,居然还炫耀。
Inty on Twitter杭州人手拿“良民证”,居然还炫耀。 Inty on Twitter镜头准备好,领导来探监了
Inty on Twitter镜头准备好,领导来探监了 Inty on Twitter桑海宁和外地人目前同等待遇了,享受铁链,铁窗,铁钉!
Inty on Twitter桑海宁和外地人目前同等待遇了,享受铁链,铁窗,铁钉!上面这种是对最基本人权和尊严的严重迫害和践踏。
更是一种非法监禁
 Inty on Twitter网友们!下面这个粉红急需一条铁链!😄
Inty on Twitter网友们!下面这个粉红急需一条铁链!😄 Patrick_Wang on Twitter新冠本来就是传染病,做过核酸表示你没有传染源,所以发一张纸,表示你是健康的。
Patrick_Wang on Twitter新冠本来就是传染病,做过核酸表示你没有传染源,所以发一张纸,表示你是健康的。怎么就“良民证”“奴隶证”呢?
难道自由的意思就是传染源可以不受控制,肆意传播吗?
希望讲道理的朋友可以跟我解释解释。
 Inty on Twitter也许还需要一个铁窗和铁钉
Inty on Twitter也许还需要一个铁窗和铁钉 Inty on Twitter中国最发达的城市----上海之后,“皇城”北京的人也开始被当作畜生一样非法强制测试,而且非常具有侮辱性地往他们身上撒消毒水
Inty on Twitter中国最发达的城市----上海之后,“皇城”北京的人也开始被当作畜生一样非法强制测试,而且非常具有侮辱性地往他们身上撒消毒水
 Inty on Twitter北京朝阳区周庄开始陆续封了
Inty on Twitter北京朝阳区周庄开始陆续封了 Inty on Twitter更新:是北京朝阳区周庄嘉园
Inty on Twitter更新:是北京朝阳区周庄嘉园 Inty on Twitter北京人开始享受铁链,铁门;
Inty on Twitter北京人开始享受铁链,铁门; 铁窗和铁钉在来的路上。
 Inty on Twitter最新消息: 中国党媒刚刚发帖叫“北京市民不用恐慌性囤货”,但是央视大五毛 刘欣 LiuXininBeijing 老早就开始囤货了,海翻墙发推炫耀。
Inty on Twitter最新消息: 中国党媒刚刚发帖叫“北京市民不用恐慌性囤货”,但是央视大五毛 刘欣 LiuXininBeijing 老早就开始囤货了,海翻墙发推炫耀。
 Inty on Twitter北京的党媒宣传机器启动。
Inty on Twitter北京的党媒宣传机器启动。温暖主题 “不用囤,菜管够”
但是党媒的五毛们早已经屯好。😅
 Inty on Twitter上海股市周一开盘已经暴跌约4% ,过去5个月大盘已经暴跌20%
Inty on Twitter上海股市周一开盘已经暴跌约4% ,过去5个月大盘已经暴跌20%第一季度,中国上海股市大盘狂跌,但是党媒说经济发展很好😂
GDP难道是朝鲜帮着中国带动的?😂
 Inty on Twitter
上海股市第一季度,三个月已经大跌15%
Inty on Twitter
上海股市第一季度,三个月已经大跌15%如果市场经济如党媒报道这么好的话,股市应该同期大涨,而不是跌
 Inty on Twitter【封城方式超出正常人想像能力】
Inty on Twitter【封城方式超出正常人想像能力】上海市政府封城措施继续加码,继在小区出入口建起铁网围封外,在浦东一些中高档住宅区,工作人员上到住宅单位大门安装围网,连扔垃圾也不行。
#上海封城
#网中人
#动物庄园 (来自RFA_Chinese)
 北京疫情局势突显严峻 朝阳区一周内将三次核酸检测
北京疫情局势突显严峻 朝阳区一周内将三次核酸检测  Inty on Twitter在上海经历封控之际,一些出生在这座城市、如今生活在纽约和伦敦等地的活动人士迫切地希望宣传他们的一个观点:上海应该独立。
Inty on Twitter在上海经历封控之际,一些出生在这座城市、如今生活在纽约和伦敦等地的活动人士迫切地希望宣传他们的一个观点:上海应该独立。 The Wall Street Journal - Breaking News, Business, F...
The Wall Street Journal - Breaking News, Business, F...  Inty on Twitter上海铁窗里发的推吗?
Inty on Twitter上海铁窗里发的推吗? newbee wen on Twitter台独分子 遗臭万年 祸及子女 悔不当初!祖国必收台湾省 中国统一势在必行
newbee wen on Twitter台独分子 遗臭万年 祸及子女 悔不当初!祖国必收台湾省 中国统一势在必行 Inty on Twitter你先出小区门口,再打口炮好吗?
Inty on Twitter你先出小区门口,再打口炮好吗? Inty on Twitter嘉定区殡仪馆最近回应一起遗体处置纠纷时披露,4月1日起,所有工作人员不得离开殡仪馆,每天火化尸体到半夜12点,死亡人数与去年同期翻倍。相关文章已被屏蔽。
Inty on Twitter嘉定区殡仪馆最近回应一起遗体处置纠纷时披露,4月1日起,所有工作人员不得离开殡仪馆,每天火化尸体到半夜12点,死亡人数与去年同期翻倍。相关文章已被屏蔽。#上海封城
 上海殡仪馆加班加点工作 浦东黄浦居民被铁栏围困
上海殡仪馆加班加点工作 浦东黄浦居民被铁栏围困 中国全球不当影响力调查 东南亚遭渗透最深
中国全球不当影响力调查 东南亚遭渗透最深  Inty on Twitter【上海街头遍布无家可归外省人】
Inty on Twitter【上海街头遍布无家可归外省人】上海封城以来,无数外省民工流落上海街头,在机场、车站外,都看到有大批人席地而睡,当中也有不少人在等候航班离开上海。
(网民提供视频) (来自RFA_Chinese)
 Inty on Twitter找亮点 😂
Inty on Twitter找亮点 😂 #核酸 #抗原 #方艙醫院 #稅收 #房租 合計 277億元
 Inty on Twitter【封城重创上海经济】
Inty on Twitter【封城重创上海经济】
【全中国唯一财政盈余地方应声倒地】
详细报道 : 封城重创上海经济 全中国唯一财政盈余地方应声倒地上海封城一个月,虽然离解封日遥遥无期,但已有网民计算过去一个月对上海市政府财政的影响。 (来自RFA_Chinese)
封城重创上海经济 全中国唯一财政盈余地方应声倒地上海封城一个月,虽然离解封日遥遥无期,但已有网民计算过去一个月对上海市政府财政的影响。 (来自RFA_Chinese)

 Inty on Twitter【封城重创上海经济】
Inty on Twitter【封城重创上海经济】【全中国唯一财政盈余地方应声倒地】
详细报道 :
 封城重创上海经济 全中国唯一财政盈余地方应声倒地上海封城一个月,虽然离解封日遥遥无期,但已有网民计算过去一个月对上海市政府财政的影响。 (来自RFA_Chinese)
封城重创上海经济 全中国唯一财政盈余地方应声倒地上海封城一个月,虽然离解封日遥遥无期,但已有网民计算过去一个月对上海市政府财政的影响。 (来自RFA_Chinese) Inty on Twitter特别新闻:
Inty on Twitter特别新闻:据知情人士透露,习近平命令中国官员,在严格执行清零政策的情况下,一定要确保该国今年的经济增长超过美国
 中國上演外資大逃難 CNN分析點出3大原因 | 兩岸 | 中央社 CNA
中國上演外資大逃難 CNN分析點出3大原因 | 兩岸 | 中央社 CNA 华日:习近平要求中国今年GDP增速超美国
华日:习近平要求中国今年GDP增速超美国  Inty on Twitter上海集中营不够用了? 开始直接把人塞进集装箱里
Inty on Twitter上海集中营不够用了? 开始直接把人塞进集装箱里
 Inty on Twitter【拆解荣耀手机:美国零部件大增】拆解从华为剥离的荣耀推出的“X30”手机,发现4成零部件来自美国,中国零部件降至10%。上个机型由华为旗下海思半导体制造的主控、通信、电源控制半导体等,在“X30”上几乎全部改为美国高通产品……
Inty on Twitter【拆解荣耀手机:美国零部件大增】拆解从华为剥离的荣耀推出的“X30”手机,发现4成零部件来自美国,中国零部件降至10%。上个机型由华为旗下海思半导体制造的主控、通信、电源控制半导体等,在“X30”上几乎全部改为美国高通产品……https://cn.nikkei.com/.....
 Inty on Twitter荣耀手机宰的就是中国五毛粉红😂😄
Inty on Twitter荣耀手机宰的就是中国五毛粉红😂😄
 Inty on Twitter那就是,你已经证实了我说的是对的,把你们当畜生一样关到集装箱里,现在还在非法剥夺人身自由,关押你们中。 😂
Inty on Twitter那就是,你已经证实了我说的是对的,把你们当畜生一样关到集装箱里,现在还在非法剥夺人身自由,关押你们中。 😂 漢江 on Twitter不要带节奏,我目前就在方舱。十几天前大爆发的时候确实有,现在随着出院人数增加集装箱和帐篷方舱都转移到室内了。
漢江 on Twitter不要带节奏,我目前就在方舱。十几天前大爆发的时候确实有,现在随着出院人数增加集装箱和帐篷方舱都转移到室内了。
 Inty on Twitter中国记录了首例人类感染H3N8型禽流感病毒的案例,但该国卫生当局表示人与人之间的传播风险很低。
Inty on Twitter中国记录了首例人类感染H3N8型禽流感病毒的案例,但该国卫生当局表示人与人之间的传播风险很低。 Inty on Twitter“都拎着大包小包,这是要逃亡。所有的人开汽车都打算逃离,但是外围的警车早就封上了,走不了啦。还有小学生背着书包要逃跑。有翻墙出去都被警车抓回来了。在大门口,有人拉着行李箱往外走的。”
Inty on Twitter“都拎着大包小包,这是要逃亡。所有的人开汽车都打算逃离,但是外围的警车早就封上了,走不了啦。还有小学生背着书包要逃跑。有翻墙出去都被警车抓回来了。在大门口,有人拉着行李箱往外走的。”#北京疫情
 忧全城封控 北京有居民连夜“外逃” 政府要市民"非必要不离京"
忧全城封控 北京有居民连夜“外逃” 政府要市民"非必要不离京"  Inty on Twitter疫情期間,不斷有人推崇 #中國、#新加坡 等 #獨裁國家 的治理模式,認為獨裁體制才能有效防疫。
Inty on Twitter疫情期間,不斷有人推崇 #中國、#新加坡 等 #獨裁國家 的治理模式,認為獨裁體制才能有效防疫。但美國賓州富蘭克林與馬歇爾學院政府系助理教授顏維婷指出,若以每百萬人的 #染疫死亡 人數 來看,新加坡的死亡人數較臺灣多,防疫成果沒有臺灣好。
 每百萬人染疫死亡數臺灣比新加坡低 政治學者顏維婷:「獨裁國家防疫成果較好」並不成立/沃草
每百萬人染疫死亡數臺灣比新加坡低 政治學者顏維婷:「獨裁國家防疫成果較好」並不成立/沃草  Inty on Twitter上海的老外,肉身翻铁墙,立刻被抓
Inty on Twitter上海的老外,肉身翻铁墙,立刻被抓 Inty on Twitter上海法领馆:视频中要自杀的人确为法国人
Inty on Twitter上海法领馆:视频中要自杀的人确为法国人  上海法领馆:视频中说“我要死”的外国人确是法国人
上海法领馆:视频中说“我要死”的外国人确是法国人  Inty on Twitter这名法国人高声呼喊要自杀的视频瞬间在网络热传,法国极右党派代表Florian Philipot 在推特上表示:一名法国人因为害怕恐怖的 #新冠集中营 而陷入崩溃!这太令人伤心了!法国政府为何袖手旁观!#上海封控
Inty on Twitter这名法国人高声呼喊要自杀的视频瞬间在网络热传,法国极右党派代表Florian Philipot 在推特上表示:一名法国人因为害怕恐怖的 #新冠集中营 而陷入崩溃!这太令人伤心了!法国政府为何袖手旁观!#上海封控  上海法领馆:视频中说"我要死"的外国人确是法国公民
上海法领馆:视频中说"我要死"的外国人确是法国公民  Inty on Twitter俾路支解放军(BLA)表示,实施 #自杀式袭击 的女性是有两个孩子的母亲,还拥有动物学研究生学位并正在攻读另一个学位,是自愿参加针对中国的袭击,反对中国在俾路支省的投资项目。 #巴基斯坦 #孔子学院
Inty on Twitter俾路支解放军(BLA)表示,实施 #自杀式袭击 的女性是有两个孩子的母亲,还拥有动物学研究生学位并正在攻读另一个学位,是自愿参加针对中国的袭击,反对中国在俾路支省的投资项目。 #巴基斯坦 #孔子学院  巴基斯坦孔子学院自杀式袭击者是一名教师、研究生和母亲
巴基斯坦孔子学院自杀式袭击者是一名教师、研究生和母亲  Inty on Twitter阿里巴巴的海外淘宝-AliExpress不再接受受到西方制裁的俄罗斯银行卡。 俄罗斯人不仅很难买到西方产品,现在连买中国小商品也困难了。
Inty on Twitter阿里巴巴的海外淘宝-AliExpress不再接受受到西方制裁的俄罗斯银行卡。 俄罗斯人不仅很难买到西方产品,现在连买中国小商品也困难了。 Inty on Twitter习近平清零政策下的中国妇女
Inty on Twitter习近平清零政策下的中国妇女 Inty on Twitter中国安徽省利辛县 小学生们被拉去强制隔离。如果正常人有孩子的话,知道这种剥夺你孩子,限制人生自由是非常残暴和反人类。但我不知道大陆父母有没有感觉。
Inty on Twitter中国安徽省利辛县 小学生们被拉去强制隔离。如果正常人有孩子的话,知道这种剥夺你孩子,限制人生自由是非常残暴和反人类。但我不知道大陆父母有没有感觉。 SC W on Twitter发生在辽宁丹东第五中学!我的家乡
SC W on Twitter发生在辽宁丹东第五中学!我的家乡 Inty on Twitter家长:孩子在哪里?
Inty on Twitter家长:孩子在哪里?领导:先把孩子们绑架一晚上再说!
 Inty on Twitter习近平近期要求官员确保中国今年的经济增速超过美国。去年四季度,美国经济同比增长5.5%,超过了中国经济同期4%的增速,这引发了中共高层的不安。
Inty on Twitter习近平近期要求官员确保中国今年的经济增速超过美国。去年四季度,美国经济同比增长5.5%,超过了中国经济同期4%的增速,这引发了中共高层的不安。#加强基建
 习近平要求加强基建 新一波"大放水"在即?
习近平要求加强基建 新一波"大放水"在即? Inty on Twitter习近平下命令,今年中国经济发展要超过美国
Inty on Twitter习近平下命令,今年中国经济发展要超过美国
 Inty on Twitter王思聪很多年前在国外就已经知道并且明白中国是垃圾国家,但是依然脚踏两只船,现在已翻船,很可能他和他的家族彻底已经被边控,跟上千万维吾尔人一个待遇了
Inty on Twitter王思聪很多年前在国外就已经知道并且明白中国是垃圾国家,但是依然脚踏两只船,现在已翻船,很可能他和他的家族彻底已经被边控,跟上千万维吾尔人一个待遇了 Inty on Twitter墙内传言
Inty on Twitter墙内传言 Inty on Twitter中国最牛逼的富二代,被全网封杀;
Inty on Twitter中国最牛逼的富二代,被全网封杀;中国最发达的上海市,人们捡垃圾吃。
公元2022年4月
 Inty on Twitter桑海宁不仅吃垃圾,而且小区还被带刀片的铁丝网封起来。
Inty on Twitter桑海宁不仅吃垃圾,而且小区还被带刀片的铁丝网封起来。 Inty on Twitter上海正常人在翻垃圾箱找吃的;
Inty on Twitter上海正常人在翻垃圾箱找吃的;上海残疾人3天没物资,开始反抗
 Inty on Twitter中国今天报告了11285个武汉病毒病例。
Inty on Twitter中国今天报告了11285个武汉病毒病例。其中上海今天报告了10621例(94%),包括1291例有症状的病例和47例死亡病例,使死亡病例总数达到285例。
很神奇,除了上海,其它14亿人的地区几乎没有什么病例。
 Inty on Twitter孙悟空来给马路消毒
Inty on Twitter孙悟空来给马路消毒 Inty on Twitter西天取经路上的,中国巫婆灭毒仪式
Inty on Twitter西天取经路上的,中国巫婆灭毒仪式
 Inty on Twitter可以!可以! 今天我的推特关注量涨势喜人!
Inty on Twitter可以!可以! 今天我的推特关注量涨势喜人! 感谢墙内党媒免费宣传
 Inty on Twitter公子沈,请再接再厉,下期反华排行榜必定有你!
Inty on Twitter公子沈,请再接再厉,下期反华排行榜必定有你! Inty on Twitter
给大家分享一下我人身中的两个最高荣誉:
Inty on Twitter
给大家分享一下我人身中的两个最高荣誉:1,左图是中国墙内警方数据库里关于我的通缉令。
案件类型:“煽动颠覆国家政权罪” 案情信息:“逃亡美国,在推特等平台使用账号发布大量反华言论”
2,右图,上榜中国著名党媒【澎湃网】的“知名反华榜”
在推特分享观点,新闻就可以颠覆中国了。
以后我一定要教大家怎么专业地使用 推特!教大家各个成为反华能手和颠覆中国的通缉犯😅😂
好文青www
 Inty on Twitter【上海人发动集体 “音乐活动”】
Inty on Twitter【上海人发动集体 “音乐活动”】
被封城了超过一个月的上海,很多居民基本物资问题仍未解决,在周四(28日),大陆网上出现多幅制图,呼吁上海居民在当晚七点一起在阳台敲锅,目的是表达不满。
#上海封城
#砸锅
#民怨
 Inty on Twitter上海大规模要饭活动
Inty on Twitter上海大规模要饭活动
 Inty on Twitter【上海人发动集体 “音乐活动”】
Inty on Twitter【上海人发动集体 “音乐活动”】被封城了超过一个月的上海,很多居民基本物资问题仍未解决,在周四(28日),大陆网上出现多幅制图,呼吁上海居民在当晚七点一起在阳台敲锅,目的是表达不满。
#上海封城
#砸锅
#民怨
 Inty on Twitter上海大规模要饭活动
Inty on Twitter上海大规模要饭活动
 Inty on Twitter不要笑
Inty on Twitter不要笑 Inty on Twitter中共狗腿子,中国黄俄卢宇光不仅在顿巴斯陪伴俄军,而且还直接参与俄军宣传机器的工作。
Inty on Twitter中共狗腿子,中国黄俄卢宇光不仅在顿巴斯陪伴俄军,而且还直接参与俄军宣传机器的工作。他是中国国防部所属的凤凰卫视频道的雇员。
这个频道的代理人在乌克兰各地毫无障碍地工作,据说他已经进入了乌克兰人的暗杀名单
 Inty on Twitter中国人诅咒中国的疫情传到美国🇺🇸
Inty on Twitter中国人诅咒中国的疫情传到美国🇺🇸 Inty on Twitter斐济高等法院对马洛洛岛的中国开发商处以罚款,这是该国首例环境犯罪判决 ,判决对象中国人
Inty on Twitter斐济高等法院对马洛洛岛的中国开发商处以罚款,这是该国首例环境犯罪判决 ,判决对象中国人 Inty on Twitter继让上海人吃垃圾桶里的菜后,又出现了让上海人乘坐垃圾车去集中营的画面
Inty on Twitter继让上海人吃垃圾桶里的菜后,又出现了让上海人乘坐垃圾车去集中营的画面#又來運小陽人了
 Inty on Twitter陈博士说,“很多外国人就往回跑,现在领事馆跟大家发消息,都是教你怎么离开你的社区,怎么样拿到文件,怎么样去到机场,机上要注意什么;如果你的配偶没有外国护照,或是你的孩子没有旅行证件,怎么办。”
Inty on Twitter陈博士说,“很多外国人就往回跑,现在领事馆跟大家发消息,都是教你怎么离开你的社区,怎么样拿到文件,怎么样去到机场,机上要注意什么;如果你的配偶没有外国护照,或是你的孩子没有旅行证件,怎么办。”#上海封城
 上海封城经济停滞 外国使领馆教侨民如何离开中国
上海封城经济停滞 外国使领馆教侨民如何离开中国  Inty on Twitter50年后? 现在就是反人类啊。😂
Inty on Twitter50年后? 现在就是反人类啊。😂 Inty on Twitter上海居民Kumi Wu4月16日开始的喉痛导致她经历了一段混乱的 #方舱医院 之旅。她拍摄了被转运两次的隔离体验,她说:“方舱给我的体会就是,像在坐牢。” (来自RFA_Chinese)
Inty on Twitter上海居民Kumi Wu4月16日开始的喉痛导致她经历了一段混乱的 #方舱医院 之旅。她拍摄了被转运两次的隔离体验,她说:“方舱给我的体会就是,像在坐牢。” (来自RFA_Chinese) Inty on Twitter上海人要饭新技巧
Inty on Twitter上海人要饭新技巧 Inty on Twitter上海外地人住大街,自己掏钱找吃的,一个月没洗澡,解封以后,再不来上海。
Inty on Twitter上海外地人住大街,自己掏钱找吃的,一个月没洗澡,解封以后,再不来上海。
 Inty on Twitter中国记录了首例人类感染H3N8型禽流感病毒的案例,但该国卫生当局表示人与人之间的传播风险很低。
Inty on Twitter中国记录了首例人类感染H3N8型禽流感病毒的案例,但该国卫生当局表示人与人之间的传播风险很低。 Inty on Twitter最新消息: 美国疾控中心CDC报告在美国科罗拉多州发现首例人类感染H5型禽流感的病例
Inty on Twitter最新消息: 美国疾控中心CDC报告在美国科罗拉多州发现首例人类感染H5型禽流感的病例
 Inty on Twitter墙国就是强!
Inty on Twitter墙国就是强! 高速边上建立人肉监控墙,防止司机下高速
#中国反人类防疫
100米站一個
 Inty on Twitter据说逮捕这个受到“境外势力”煽动的敲锅要饭的上海人,来树立典型,吓唬其他敲锅者。
Inty on Twitter据说逮捕这个受到“境外势力”煽动的敲锅要饭的上海人,来树立典型,吓唬其他敲锅者。
 Inty on Twitter【湖南长沙一幢六层楼高的建筑倒塌】
Inty on Twitter【湖南长沙一幢六层楼高的建筑倒塌】周五(29日)中午,湖南长沙市望城区一幢楼高六层的建筑突然倒塌,楼宇内有餐厅、私人影院和家庭旅馆。救援人员初步判断有人被困。
(网民提供视频)
 jiamian on Twitter哼哼😄,误会了。我们是心甘情愿的被控被捅被饿,为了保证伟大的中国共产党能长期执政,为了领袖的终身连任,饿死一批人不要紧,大中国最不缺的就是人。只要领袖和领导们过得红红火火,我们虽死犹荣
jiamian on Twitter哼哼😄,误会了。我们是心甘情愿的被控被捅被饿,为了保证伟大的中国共产党能长期执政,为了领袖的终身连任,饿死一批人不要紧,大中国最不缺的就是人。只要领袖和领导们过得红红火火,我们虽死犹荣
 Inty on Twitter中国把南非人饿死了。
Inty on Twitter中国把南非人饿死了。 方舟子 on Twitter
方舟子 on Twitter Inty on Twitter他写过的书包括:
Inty on Twitter他写过的书包括:『東突厥獨立運動:1930年代――1940年代』
『亦師亦友亦敵――民族主義與近代中日關係』
『中國、従「天下」到民族國家』
『消失的「國民」――近代中國的「民族」話語與少数民族的國家認同』
等等
 Inty on Twitter南非媒体The South Africa 4 月20日报道称,南非外交部发言人ClaysonMonyela证实,定居上海的29岁的南非女教师Noma Blackie于4月18日在上海封控期间死亡,细节和原因尚不清楚。发言人称,上海封控期间,南非领事馆的工作人员的孩子需要紧急手术也无法施行。(来自RFA_Chinese)
Inty on Twitter南非媒体The South Africa 4 月20日报道称,南非外交部发言人ClaysonMonyela证实,定居上海的29岁的南非女教师Noma Blackie于4月18日在上海封控期间死亡,细节和原因尚不清楚。发言人称,上海封控期间,南非领事馆的工作人员的孩子需要紧急手术也无法施行。(来自RFA_Chinese) 中国疫情报北京本土例升追上海
中国疫情报北京本土例升追上海  封城恶果激起强烈反弹,中国高层决心将“清零”坚持到底
封城恶果激起强烈反弹,中国高层决心将“清零”坚持到底 Inty on Twitter【#变态辣椒:#习近平 #清零 政策导致经济灾难 殃及美日】
Inty on Twitter【#变态辣椒:#习近平 #清零 政策导致经济灾难 殃及美日】 Inty on Twitter习近平的清零政策,让这个中国人的20万斤芒果全部腐烂了
Inty on Twitter习近平的清零政策,让这个中国人的20万斤芒果全部腐烂了 Inty on Twitter上海异见人士 #季孝龙 向本台说,侵吞、倒卖物资的消息在上海非常普遍:“很多居委会在暗箱操作,他们私底下有内供的,甚至有些居委会有一些外省送过来的救济物品,他们就在那里卖,卖很高的价格。”
Inty on Twitter上海异见人士 #季孝龙 向本台说,侵吞、倒卖物资的消息在上海非常普遍:“很多居委会在暗箱操作,他们私底下有内供的,甚至有些居委会有一些外省送过来的救济物品,他们就在那里卖,卖很高的价格。”#上海封城
 上海封城中的官方腐败:居委会囤物倒卖 救护车私用赚钱
上海封城中的官方腐败:居委会囤物倒卖 救护车私用赚钱  Inty on Twitter下面这个骂习近平的句子是我看过最猛的。😂
Inty on Twitter下面这个骂习近平的句子是我看过最猛的。😂 Prophesy秘谶 on Twitter亚非拉慰安妇、华北炕日根据地头牌皇军慰安妇、陕北农妓运动讲习所首席所妓、延安108窑姐,"黑桃皇后BBC”01号皇后齐心,和皇军大佐 龟头正雄-梅川内酷,生下孽子皇军的野种习近平。养父习仲勋!
Prophesy秘谶 on Twitter亚非拉慰安妇、华北炕日根据地头牌皇军慰安妇、陕北农妓运动讲习所首席所妓、延安108窑姐,"黑桃皇后BBC”01号皇后齐心,和皇军大佐 龟头正雄-梅川内酷,生下孽子皇军的野种习近平。养父习仲勋! 习仲勋 on Twitter谢谢,我看那么多人把锅推给我是真的忍不了,习近平就不是我的种!
习仲勋 on Twitter谢谢,我看那么多人把锅推给我是真的忍不了,习近平就不是我的种!
中共於五月一號起正式禁止中國人民辦理移民
澳洲人舉牌罵習近平,受到中國人的攻擊影片
 Inty on Twitter我好久没有外出做这样有趣的视频了,过两天去中国人集中的地方,我也举个骂习包子的牌子,做一下社會實驗
Inty on Twitter我好久没有外出做这样有趣的视频了,过两天去中国人集中的地方,我也举个骂习包子的牌子,做一下社會實驗
 Inty on Twitter澳大利亚人在当地一个中国超市门口举牌子社会实验,牌子上写着 "去他妈的习近平",于是立刻引出习包子的中国徒子徒孙,这些中国人歇斯底里的攻击澳大利亚人
Inty on Twitter澳大利亚人在当地一个中国超市门口举牌子社会实验,牌子上写着 "去他妈的习近平",于是立刻引出习包子的中国徒子徒孙,这些中国人歇斯底里的攻击澳大利亚人
澳洲人舉牌罵習近平,受到中國人的攻擊影片
 Inty on Twitter我好久没有外出做这样有趣的视频了,过两天去中国人集中的地方,我也举个骂习包子的牌子,做一下社會實驗
Inty on Twitter我好久没有外出做这样有趣的视频了,过两天去中国人集中的地方,我也举个骂习包子的牌子,做一下社會實驗 Inty on Twitter澳大利亚人在当地一个中国超市门口举牌子社会实验,牌子上写着 "去他妈的习近平",于是立刻引出习包子的中国徒子徒孙,这些中国人歇斯底里的攻击澳大利亚人
Inty on Twitter澳大利亚人在当地一个中国超市门口举牌子社会实验,牌子上写着 "去他妈的习近平",于是立刻引出习包子的中国徒子徒孙,这些中国人歇斯底里的攻击澳大利亚人
 Inty on Twitter三年前我外出采访的在美,中国小粉红,非常歇斯底里
Inty on Twitter三年前我外出采访的在美,中国小粉红,非常歇斯底里 洛杉矶湖人队主场外面,有人代表中国人,叫香港人去死。。。 (2019年NBA开幕式场外,支持香港的活动,...
洛杉矶湖人队主场外面,有人代表中国人,叫香港人去死。。。 (2019年NBA开幕式场外,支持香港的活动,... Inty on Twitter我采访的在美中国老粉红,这些人也很恐怖 😆
Inty on Twitter我采访的在美中国老粉红,这些人也很恐怖 😆 街头采访在美国的中国老粉红,老五毛,他们参加共产党在美国举行的升血旗仪式。。。
街头采访在美国的中国老粉红,老五毛,他们参加共产党在美国举行的升血旗仪式。。。 Inty on Twitter俄国境内粉红
Inty on Twitter俄国境内粉红
 Inty on Twitter印度指控中国小米在国外非法汇款,扣押了小米7.25亿美元资金
Inty on Twitter印度指控中国小米在国外非法汇款,扣押了小米7.25亿美元资金战狼在哪里?印度乳华了,快上!
 China News on Twitter
China News on Twitter 小米集團涉嫌非法匯款 印度當局扣押逾7億美元 | 國際 | 中央社 CNA
小米集團涉嫌非法匯款 印度當局扣押逾7億美元 | 國際 | 中央社 CNA  美高校师生呼吁校方从中国撤资
美高校师生呼吁校方从中国撤资 Inty on Twitter澳大利亚人在当地一个中国超市门口举牌子社会实验,牌子上写着 "去他妈的习近平",于是立刻引出习包子的中国徒子徒孙,这些中国人歇斯底里的攻击澳大利亚人
Inty on Twitter澳大利亚人在当地一个中国超市门口举牌子社会实验,牌子上写着 "去他妈的习近平",于是立刻引出习包子的中国徒子徒孙,这些中国人歇斯底里的攻击澳大利亚人 Inty on Twitter澳大利亚的中国人看到习近平被骂,感觉自己亲爹被骂一样难受。 这些习包子的徒子徒孙,感觉就是来自中国的潜在恐怖分子,随时要动手杀人的感觉。中共洗脑太厉害了,把这些中国人洗成SB了😆
Inty on Twitter澳大利亚的中国人看到习近平被骂,感觉自己亲爹被骂一样难受。 这些习包子的徒子徒孙,感觉就是来自中国的潜在恐怖分子,随时要动手杀人的感觉。中共洗脑太厉害了,把这些中国人洗成SB了😆 Inty on Twitter这样的中国人大部分都是被洗脑的底层,非常恐怖
Inty on Twitter这样的中国人大部分都是被洗脑的底层,非常恐怖 街头采访在美国的中国老粉红,老五毛,他们参加共产党在美国举行的升血旗仪式。。。
街头采访在美国的中国老粉红,老五毛,他们参加共产党在美国举行的升血旗仪式。。。  Inty on Twitter美国国务卿布林肯将在未来几周公开阐述美国应对中国崛起的对华战略。普林斯顿大学教授范亚伦认为,新战略应对中国采取更强硬立场,如果美国做的不够,反而可能让中国领导人误判情势,以为可以用武力改变现状。
Inty on Twitter美国国务卿布林肯将在未来几周公开阐述美国应对中国崛起的对华战略。普林斯顿大学教授范亚伦认为,新战略应对中国采取更强硬立场,如果美国做的不够,反而可能让中国领导人误判情势,以为可以用武力改变现状。 专访普林斯顿教授范亚伦:西方低估了中共的无情和统治决心
专访普林斯顿教授范亚伦:西方低估了中共的无情和统治决心  Inty on Twitter中国人自杀式袭击中共警察局?
Inty on Twitter中国人自杀式袭击中共警察局?已经造成7人死亡
 Inty on Twitter重庆发生枪战。
Inty on Twitter重庆发生枪战。#中国太安全系列
 Inty on Twitter中国网络语“润”火了起来,“润”即英文run,跑路的意思。疫情期间,越来越多的人想要逃离中国。英文网站“改变中国”主编曹雅学说,其实中国人无路可逃,要思考如何参与体制,改变中国。 #时事大家谈 完整版:
Inty on Twitter中国网络语“润”火了起来,“润”即英文run,跑路的意思。疫情期间,越来越多的人想要逃离中国。英文网站“改变中国”主编曹雅学说,其实中国人无路可逃,要思考如何参与体制,改变中国。 #时事大家谈 完整版: 4/30【时事大家谈】上海防疫放“软” 民众反抗让政府畏惧?进京路口重兵把守 北京“被上海”了?
4/30【时事大家谈】上海防疫放“软” 民众反抗让政府畏惧?进京路口重兵把守 北京“被上海”了?
全裸
 Inty on Twitter中国方舱集中营,激情群架?
Inty on Twitter中国方舱集中营,激情群架?
 Inty on Twitter俄国党媒很开心的宣传👇
Inty on Twitter俄国党媒很开心的宣传👇

很快就可以看到不只死南非人還有俄國人了囉
 法媒采访在上海的法国人:都期盼尽快离开中国结束噩梦
法媒采访在上海的法国人:都期盼尽快离开中国结束噩梦
 Inty on Twitter中国方舱集中营,激情群架?
Inty on Twitter中国方舱集中营,激情群架? Inty on Twitter俄国党媒很开心的宣传👇
Inty on Twitter俄国党媒很开心的宣传👇很快就可以看到不只死南非人還有俄國人了囉
 法媒采访在上海的法国人:都期盼尽快离开中国结束噩梦
法媒采访在上海的法国人:都期盼尽快离开中国结束噩梦  Inty on Twitter中共党媒战狼编辑 chenweihua 陈卫华 要求马斯克取消掉他的党媒标签,说这个是歧视。
Inty on Twitter中共党媒战狼编辑 chenweihua 陈卫华 要求马斯克取消掉他的党媒标签,说这个是歧视。哈哈!居然对党不忠诚!不想自豪的显示自己的党媒身份! 还是不能再偷偷地做小偷,渗透?😆
我们看看马斯克会不会听中共党媒的话
所以这些两面人,知道党媒的身份是多么丢人的事情。😆 还恬不知耻地要言论自由。
 Inty on Twitter推特两年前开始执行给中共等党媒贴标签,让他们光明正大的做宣传。不要再像小偷一样行事
Inty on Twitter推特两年前开始执行给中共等党媒贴标签,让他们光明正大的做宣传。不要再像小偷一样行事
 Inty on Twitter习近平清零政策,终于让上海人过上了共产主义的美化生活
Inty on Twitter习近平清零政策,终于让上海人过上了共产主义的美化生活(兩個人七兩大米)
 Inty on Twitter中国人喜迎共产主义。 生活在中国,你就偷着乐吧
Inty on Twitter中国人喜迎共产主义。 生活在中国,你就偷着乐吧(26個人分55顆雞蛋、兩包(目測兩公斤)米、兩瓶調味料、兩個罐頭)
 Inty on Twitter上海有1000万常住外来人口,尤其是安徽人居多,开黑车,黑帮等等大部分是安徽人。 还有大陆其它地方的人。 现在的上海人不能只靠口语来判断。 市中心以讲沪语的上海土著较多。
Inty on Twitter上海有1000万常住外来人口,尤其是安徽人居多,开黑车,黑帮等等大部分是安徽人。 还有大陆其它地方的人。 现在的上海人不能只靠口语来判断。 市中心以讲沪语的上海土著较多。
 全球反專制暴政聯盟(官推) on Twitter安徽省定远县七里塘乡韩圩村干部从4月21日开始,每天带领几十口社会闲杂人员手持铁锹,强行阻拦农民春耕毁坏种苗!
全球反專制暴政聯盟(官推) on Twitter安徽省定远县七里塘乡韩圩村干部从4月21日开始,每天带领几十口社会闲杂人员手持铁锹,强行阻拦农民春耕毁坏种苗! Inty on Twitter4月28日,上海嘉定,人们饿的偷土豆
Inty on Twitter4月28日,上海嘉定,人们饿的偷土豆 Inty on Twitter嘉定也是上海郊区,有很多农田。也很多常住的外地上海人, 不是一般人想象中的上海的样子。
Inty on Twitter嘉定也是上海郊区,有很多农田。也很多常住的外地上海人, 不是一般人想象中的上海的样子。
 Inty on Twitter喀什人送给上海人的物资被上海宝山当官的给私藏了,被快饿死的小区业主们撬开找到😅
Inty on Twitter喀什人送给上海人的物资被上海宝山当官的给私藏了,被快饿死的小区业主们撬开找到😅 Inty on Twitter北京人受到迫害,被要求强制做核酸,但这种场面本末倒置,是要加油群聚传播吗? 😂
Inty on Twitter北京人受到迫害,被要求强制做核酸,但这种场面本末倒置,是要加油群聚传播吗? 😂 搞测试的官员和厂家发大财了
 Inty on Twitter中国【黄命贵】运动在哪里?
Inty on Twitter中国【黄命贵】运动在哪里?
 Inty on Twitter中国防疫群架清零政策
Inty on Twitter中国防疫群架清零政策 Inty on Twitter
Inty on Twitter 美国皮尤新民调:82%美国人负面看中国
美国皮尤新民调:82%美国人负面看中国 Inty on Twitter马上美国🇺🇸中期选举,民主党和共和党看到这一选民数据,更要抢着反华了。 我们这些反华分子都排不上名单了
Inty on Twitter马上美国🇺🇸中期选举,民主党和共和党看到这一选民数据,更要抢着反华了。 我们这些反华分子都排不上名单了 Inty on Twitter中共开始害怕美国的民意了,恳求记者们传播正能量😅
Inty on Twitter中共开始害怕美国的民意了,恳求记者们传播正能量😅
 Inty on Twitter上海用钢板或铁栏把有阳性病例的居民楼和小区封死,造成大楼失火无法逃生的惨剧。为了平息民愤,杨浦区尝试“软分隔”。独立时评人鲁难说,虽然上海没有“方方”,但民众集体发声让政府感到畏惧。#时事大家谈 完整版:
Inty on Twitter上海用钢板或铁栏把有阳性病例的居民楼和小区封死,造成大楼失火无法逃生的惨剧。为了平息民愤,杨浦区尝试“软分隔”。独立时评人鲁难说,虽然上海没有“方方”,但民众集体发声让政府感到畏惧。#时事大家谈 完整版: 4/30【时事大家谈】上海防疫放“软” 民众反抗让政府畏惧?进京路口重兵把守 北京“被上海”了?
4/30【时事大家谈】上海防疫放“软” 民众反抗让政府畏惧?进京路口重兵把守 北京“被上海”了?  Inty on Twitter上海用钢板或铁栏把有阳性病例的居民楼和小区封死,造成大楼失火无法逃生的惨剧。为了平息民愤,杨浦区尝试“软分隔”。独立时评人鲁难说,虽然上海没有“方方”,但民众集体发声让政府感到畏惧。#时事大家谈 完整版:
Inty on Twitter上海用钢板或铁栏把有阳性病例的居民楼和小区封死,造成大楼失火无法逃生的惨剧。为了平息民愤,杨浦区尝试“软分隔”。独立时评人鲁难说,虽然上海没有“方方”,但民众集体发声让政府感到畏惧。#时事大家谈 完整版: 4/30【时事大家谈】上海防疫放“软” 民众反抗让政府畏惧?进京路口重兵把守 北京“被上海”了?
4/30【时事大家谈】上海防疫放“软” 民众反抗让政府畏惧?进京路口重兵把守 北京“被上海”了?  Inty on Twitter中国清零折腾老百姓,有猜测可能会出现大面积反抗。但英文网站“改变中国”主编曹雅学说,虽然二十大前习近平的戏难演,但中共对基层的防范和打压,使得民间没有自我组织能力。#时事大家谈 完整版:
Inty on Twitter中国清零折腾老百姓,有猜测可能会出现大面积反抗。但英文网站“改变中国”主编曹雅学说,虽然二十大前习近平的戏难演,但中共对基层的防范和打压,使得民间没有自我组织能力。#时事大家谈 完整版: 4/30【时事大家谈】上海防疫放“软” 民众反抗让政府畏惧?进京路口重兵把守 北京“被上海”了?
4/30【时事大家谈】上海防疫放“软” 民众反抗让政府畏惧?进京路口重兵把守 北京“被上海”了?
送焚化爐都有了
 Inty on Twitter中国活人差点被送进太平间
Inty on Twitter中国活人差点被送进太平间
 Inty on Twitter上海良民证
Inty on Twitter上海良民证
 Inty on Twitter
Inty on Twitter
“ #中国人最没有恐惧的7个星期” -- #吴仁华口述六四史(5月1日) 1989年5月1日,北大筹委会举办记者招待会。中间念稿者是 #王丹,左下角着红衬衫者是 #孔庆东。
 “中国人最没有恐惧的7个星期” --吴仁华口述“六四”史(5月1日)
“中国人最没有恐惧的7个星期” --吴仁华口述“六四”史(5月1日)
 Inty on Twitter中国活人差点被送进太平间
Inty on Twitter中国活人差点被送进太平间 Inty on Twitter上海良民证
Inty on Twitter上海良民证 Inty on Twitter
Inty on Twitter“ #中国人最没有恐惧的7个星期” -- #吴仁华口述六四史(5月1日) 1989年5月1日,北大筹委会举办记者招待会。中间念稿者是 #王丹,左下角着红衬衫者是 #孔庆东。
 “中国人最没有恐惧的7个星期” --吴仁华口述“六四”史(5月1日)
“中国人最没有恐惧的7个星期” --吴仁华口述“六四”史(5月1日)
05/02
 Inty on Twitter【上海高压隔离措施】
Inty on Twitter【上海高压隔离措施】
【防疫人员破门冲入民居抓人到方舱】
上海防疫政策混乱,不少居民投诉,正式的检测结果还未收到,防疫人员已强行把居民押到方舱隔离,而且手法也越来越粗暴。
#上海封城
#公安执法
#中国方案
 中国的新冠清零强硬路线吞噬了从特斯拉到速食店的一切
中国的新冠清零强硬路线吞噬了从特斯拉到速食店的一切
 Inty on Twitter【上海高压隔离措施】
Inty on Twitter【上海高压隔离措施】 【防疫人员破门冲入民居抓人到方舱】
上海防疫政策混乱,不少居民投诉,正式的检测结果还未收到,防疫人员已强行把居民押到方舱隔离,而且手法也越来越粗暴。
#上海封城
#公安执法
#中国方案
 中国的新冠清零强硬路线吞噬了从特斯拉到速食店的一切
中国的新冠清零强硬路线吞噬了从特斯拉到速食店的一切  Inty on Twitter【唱空中国股市银行高管被禁言】
Inty on Twitter【唱空中国股市银行高管被禁言】【直言股灾不是因为美国,而是中国监管部门引起】
 唱空中国股市国營银行高管洪灏被禁言中国政府由前年开始,已针对经济评论,不少大陆独立经济分析文章被删,部分作者被当局警告,到最近,近国营银行高管也难逃一劫。 (来自RFA_Chinese)
唱空中国股市国營银行高管洪灏被禁言中国政府由前年开始,已针对经济评论,不少大陆独立经济分析文章被删,部分作者被当局警告,到最近,近国营银行高管也难逃一劫。 (来自RFA_Chinese) Inty on Twitter“现场没有人能想出解决问题的好办法,”
Inty on Twitter“现场没有人能想出解决问题的好办法,”“中国的银行系统没有准备好冻结其美元资产或将其排除在 #SWIFT 国际结算系统之外,就像美国对俄罗斯所做的那样。”
 《金融时报》:北京召集外银高管商议 若遭金融制裁如何应对
《金融时报》:北京召集外银高管商议 若遭金融制裁如何应对  Inty on Twitter上海人发现超市买的肉是外省免费捐助的,给路人看的时候被逮捕了
Inty on Twitter上海人发现超市买的肉是外省免费捐助的,给路人看的时候被逮捕了 Inty on Twitter中国最新罪名:泄露“出售外省赠品"这一国家最高机密罪
Inty on Twitter中国最新罪名:泄露“出售外省赠品"这一国家最高机密罪 Inty on Twitter中国疾控中心的工作人员称,上级已经告诉员工不要公开批评中国的抗疫策略或提出替代方案,以免打击干部群众抗击疫情的士气。
Inty on Twitter中国疾控中心的工作人员称,上级已经告诉员工不要公开批评中国的抗疫策略或提出替代方案,以免打击干部群众抗击疫情的士气。不过,这些人说,中国的一些顶级公共卫生专家私下里称,目前的“动态清零”抗疫政策是不可持续的。
 京沪疫情再度引发有关中国“动态清零”策略的讨论
京沪疫情再度引发有关中国“动态清零”策略的讨论  44%被中国监禁的记者是维吾尔人 - 头条趋势
44%被中国监禁的记者是维吾尔人 - 头条趋势 中国小米在印度出事 被扣7.25亿美元
中国小米在印度出事 被扣7.25亿美元 推特上的中国:活人当死尸运走 电话亭里生活 上海防疫引发热议
推特上的中国:活人当死尸运走 电话亭里生活 上海防疫引发热议 44%被中国监禁的记者是维吾尔人
44%被中国监禁的记者是维吾尔人 Inty on Twitter墙内传言马云被逮捕,阿里巴巴香港股价开盘瞬间暴跌9% 😂
Inty on Twitter墙内传言马云被逮捕,阿里巴巴香港股价开盘瞬间暴跌9% 😂 Inty on Twitter但是央视喉舌报道是马某某,应该不是马云。 阿里巴巴股票又涨回来了。
Inty on Twitter但是央视喉舌报道是马某某,应该不是马云。 阿里巴巴股票又涨回来了。 Mike Huang on Twitter最早的央視新聞是說馬某,這是阿里巴巴股票暴跌的原因,後來很快改成馬某某了,第一次的錯誤不曉得是否是故意的。
Mike Huang on Twitter最早的央視新聞是說馬某,這是阿里巴巴股票暴跌的原因,後來很快改成馬某某了,第一次的錯誤不曉得是否是故意的。 Inty on Twitter
Inty on Twitter 经济越糟糕审查越严厉,知名市场分析师社媒账户被封杀
经济越糟糕审查越严厉,知名市场分析师社媒账户被封杀 Inty on Twitter中共去年已经要求自媒体不要唱衰经济,要不然封你号。
Inty on Twitter中共去年已经要求自媒体不要唱衰经济,要不然封你号。你只能夸! 😂
 欧盟拒绝以卢布支付俄罗斯天然气 并准备应对供应中断
欧盟拒绝以卢布支付俄罗斯天然气 并准备应对供应中断 Inty on Twitter此外有知情人透漏,中国还考虑推动大型科技公司提供1/100股权给政府,以此让政府在企业决策中发挥直接作用。目前中国政府已持股百分之一的公司有 #微博、#字节跳动 等。
Inty on Twitter此外有知情人透漏,中国还考虑推动大型科技公司提供1/100股权给政府,以此让政府在企业决策中发挥直接作用。目前中国政府已持股百分之一的公司有 #微博、#字节跳动 等。 封控与复工 习近平能否在矛盾中挽救经济?
封控与复工 习近平能否在矛盾中挽救经济? Inty on Twitter
Inty on Twitter 美国指责中国官员官媒为支持俄罗斯对乌战争做虚假宣传
美国指责中国官员官媒为支持俄罗斯对乌战争做虚假宣传 #河南封城
 Inty on Twitter墙内传出河南郑州准备"喜迎"封城,河南人跑的跑的,抢的抢,郑州快瘫痪了😅
Inty on Twitter墙内传出河南郑州准备"喜迎"封城,河南人跑的跑的,抢的抢,郑州快瘫痪了😅
 Inty on Twitter河南政府美名曰:“足不出区” ,出去就把你的足给砍断?😂
Inty on Twitter河南政府美名曰:“足不出区” ,出去就把你的足给砍断?😂

 Inty on Twitter活人被当死尸运走,警察破门抓人,过去这个周末,多起上海防疫事故被曝光,也在推特上引起热议。观察人士对此纷纷给出了“恐怖“和“混乱”的评价,并认为这样的乱象只会进一步加剧上海民众对政府的不信任。详细内容:
Inty on Twitter活人被当死尸运走,警察破门抓人,过去这个周末,多起上海防疫事故被曝光,也在推特上引起热议。观察人士对此纷纷给出了“恐怖“和“混乱”的评价,并认为这样的乱象只会进一步加剧上海民众对政府的不信任。详细内容: 推特上的中国:活人当死尸运走 电话亭里生活 上海防疫引发热议
推特上的中国:活人当死尸运走 电话亭里生活 上海防疫引发热议
 Inty on Twitter墙内传出河南郑州准备"喜迎"封城,河南人跑的跑的,抢的抢,郑州快瘫痪了😅
Inty on Twitter墙内传出河南郑州准备"喜迎"封城,河南人跑的跑的,抢的抢,郑州快瘫痪了😅 Inty on Twitter河南政府美名曰:“足不出区” ,出去就把你的足给砍断?😂
Inty on Twitter河南政府美名曰:“足不出区” ,出去就把你的足给砍断?😂 Inty on Twitter活人被当死尸运走,警察破门抓人,过去这个周末,多起上海防疫事故被曝光,也在推特上引起热议。观察人士对此纷纷给出了“恐怖“和“混乱”的评价,并认为这样的乱象只会进一步加剧上海民众对政府的不信任。详细内容:
Inty on Twitter活人被当死尸运走,警察破门抓人,过去这个周末,多起上海防疫事故被曝光,也在推特上引起热议。观察人士对此纷纷给出了“恐怖“和“混乱”的评价,并认为这样的乱象只会进一步加剧上海民众对政府的不信任。详细内容: 推特上的中国:活人当死尸运走 电话亭里生活 上海防疫引发热议
推特上的中国:活人当死尸运走 电话亭里生活 上海防疫引发热议  Inty on Twitter上海持续实施极端防疫措施至今已一个多月,多个小区出现了居民敲打锅碗瓢盆以示抗议的景象。一位荷兰人Jaap Grolleman告诉路透社,4月1日起,他和小区居民们就被隔离在各自公寓里至今。 (来自RFA_Chinese)
Inty on Twitter上海持续实施极端防疫措施至今已一个多月,多个小区出现了居民敲打锅碗瓢盆以示抗议的景象。一位荷兰人Jaap Grolleman告诉路透社,4月1日起,他和小区居民们就被隔离在各自公寓里至今。 (来自RFA_Chinese) Inty on Twitter#王思聪 #王健林
Inty on Twitter#王思聪 #王健林  评论 | 陈光诚: “核酸检测的不是阳性或阴性,而是你的奴性和血性”
评论 | 陈光诚: “核酸检测的不是阳性或阴性,而是你的奴性和血性” “新闻自由不是人民的敌人” 拜登政府担忧中国现况
“新闻自由不是人民的敌人” 拜登政府担忧中国现况 Inty on Twitter
Inty on Twitter 央视短讯闹了大乌龙,“马某”二字引起市场恐慌抛售阿里股票
央视短讯闹了大乌龙,“马某”二字引起市场恐慌抛售阿里股票  Inty on Twitter今天中共北京政府说有51个新的武汉病毒病例
Inty on Twitter今天中共北京政府说有51个新的武汉病毒病例于是北京关闭40个地铁站和158条公交线路,不能两人以上同时上厕所,还有部分小区已经封禁10天😂
北京,上海中国最顶级的城市,奴性也很高。
其它地方就更没戏了。
中国靠民间改变,几乎是不可能的事情
 Inty on Twitter北京,中国的首都,不让盲人的导盲犬进公园。🤣
Inty on Twitter北京,中国的首都,不让盲人的导盲犬进公园。🤣生活在中国,你就偷着乐吧
 Inty on Twitter郑州正式封城,一个人出入城需要同时出示 4个良民证,缺一不可
Inty on Twitter郑州正式封城,一个人出入城需要同时出示 4个良民证,缺一不可
 粉蛆生态研究专家 on Twitter
不能两人以上同时上厕所,但可以100人挤一起测核酸。
粉蛆生态研究专家 on Twitter
不能两人以上同时上厕所,但可以100人挤一起测核酸。
 Inty on Twitter中国人啊,请你们不要再给我们这样的“境外反华势力”递刀子好吗?
Inty on Twitter中国人啊,请你们不要再给我们这样的“境外反华势力”递刀子好吗? Inty on TwitterWelcome to China!
Inty on TwitterWelcome to China! The Best Country in the world! 🤣
 Inty on Twitter疫情期间,生活在中国,你就偷着乐吧😅
Inty on Twitter疫情期间,生活在中国,你就偷着乐吧😅(搶糧)
 Inty on Twitter
Inty on Twitter 直言不讳的中国策略师洪灏从交银国际离职,此前社交媒体账号被封最近几个月,这位分析师的报告和帖子涉及了可能被认为敏感的议题,比如中国公司从美国退市、中国资本外逃风险,以及抗疫封控的经济影响。
直言不讳的中国策略师洪灏从交银国际离职,此前社交媒体账号被封最近几个月,这位分析师的报告和帖子涉及了可能被认为敏感的议题,比如中国公司从美国退市、中国资本外逃风险,以及抗疫封控的经济影响。
 Inty on Twitter#无国界记者 组织公布最新 #2022新闻自由度排名 ,挪威、丹麦、瑞典北欧三国排行前三。中国第175名,全球倒数第6。香港第148名,退步了68名为最多。台湾则排在第38名,领先美澳日韩。
Inty on Twitter#无国界记者 组织公布最新 #2022新闻自由度排名 ,挪威、丹麦、瑞典北欧三国排行前三。中国第175名,全球倒数第6。香港第148名,退步了68名为最多。台湾则排在第38名,领先美澳日韩。 2022全球新闻自由度 中国倒数第六 香港巨幅滑落至第148名
2022全球新闻自由度 中国倒数第六 香港巨幅滑落至第148名 Inty on Twitter【农村封区将成常态化?】
Inty on Twitter【农村封区将成常态化?】【村民进出均需申请”出入证”】
为了限制人口流动造成的病毒传播,河北部分农村开始严格限制村民进出,像河北衡水市,地方干部私自制定规矩,以后要村民申请 “出入证”才能进出村镇范围。
#中国防疫
#封城
#大饥荒 (来自RFA_Chinese)
 Inty on Twitter中国的爱国英雄---郎平,在美国安享晚年,她也觉得中国是垃圾🤣
Inty on Twitter中国的爱国英雄---郎平,在美国安享晚年,她也觉得中国是垃圾🤣看看评论区
 Inty on Twitter中国人的同胞鲁迅骂中国人
Inty on Twitter中国人的同胞鲁迅骂中国人 Inty on Twitter鲁迅说:中国就是“肮脏、丑陋、腐朽、败坏”,不服来辩🤣
Inty on Twitter鲁迅说:中国就是“肮脏、丑陋、腐朽、败坏”,不服来辩🤣 上海封锁:一名韩国人死亡获韩领馆确认
上海封锁:一名韩国人死亡获韩领馆确认
05/05
 Inty on Twitter美国研究人员发现,武汉病毒从狗传到人的可能性。
Inty on Twitter美国研究人员发现,武汉病毒从狗传到人的可能性。
完了,习近平听到以后,要开始灭狗运动了! 要不然不能清零啊!
 Study finds how coronavirus can jump from dogs to hu...
Study finds how coronavirus can jump from dogs to hu...
 Inty on Twitter上海人在(监)家(狱)吃不饱饭?
Inty on Twitter上海人在(监)家(狱)吃不饱饭?
没关系,党为你跳个舞,看一会就饱了。
 Inty on Twitter中国反人类防疫新手段,给人们家里的冰箱贴封条。😲🤣
Inty on Twitter中国反人类防疫新手段,给人们家里的冰箱贴封条。😲🤣
China banning people from opening their own fridges
 Inty on Twitter美国研究人员发现,武汉病毒从狗传到人的可能性。
Inty on Twitter美国研究人员发现,武汉病毒从狗传到人的可能性。完了,习近平听到以后,要开始灭狗运动了! 要不然不能清零啊!
 Study finds how coronavirus can jump from dogs to hu...
Study finds how coronavirus can jump from dogs to hu... Inty on Twitter上海人在(监)家(狱)吃不饱饭?
Inty on Twitter上海人在(监)家(狱)吃不饱饭?没关系,党为你跳个舞,看一会就饱了。
 Inty on Twitter中国反人类防疫新手段,给人们家里的冰箱贴封条。😲🤣
Inty on Twitter中国反人类防疫新手段,给人们家里的冰箱贴封条。😲🤣China banning people from opening their own fridges
 Inty on Twitter上海养老院日常。
Inty on Twitter上海养老院日常。 BobbieTucker on Twitter老人5.2已经去世,家属今天在网上看到这视频的时候报警,医院也跟他们承认了
BobbieTucker on Twitter老人5.2已经去世,家属今天在网上看到这视频的时候报警,医院也跟他们承认了 Inty on Twitter#变态辣椒 :中国大规模进行 #核酸测试 (来自RFA_Chinese)
Inty on Twitter#变态辣椒 :中国大规模进行 #核酸测试 (来自RFA_Chinese) Inty on Twitter”当局杀掉公鸡,天就不会亮吗?”
Inty on Twitter”当局杀掉公鸡,天就不会亮吗?”#洪灏被禁言
 经济学家洪灏被禁言后辞职 专家: 韭菜们要小心了
经济学家洪灏被禁言后辞职 专家: 韭菜们要小心了 清零太疯狂 囚禁不可逆 西媒质疑习近平有无逻辑
清零太疯狂 囚禁不可逆 西媒质疑习近平有无逻辑  Inty on Twitter北京石景山医院封院,还不准拍。
Inty on Twitter北京石景山医院封院,还不准拍。 这里面的白卫兵怎么把北京人搞死都可以。
 Inty on Twitter央视说:你骂谁呢
Inty on Twitter央视说:你骂谁呢 Inty on Twitter这个NB,白卫兵们想让中国人给他们烧香拜佛吗?😂
Inty on Twitter这个NB,白卫兵们想让中国人给他们烧香拜佛吗?😂
 Inty on Twitter此刻在美国享受生活的 “中国女英雄”谷爱凌和郎平看着你们这样”爱国”粉红们的留言,正在偷着乐呢。🤣
Inty on Twitter此刻在美国享受生活的 “中国女英雄”谷爱凌和郎平看着你们这样”爱国”粉红们的留言,正在偷着乐呢。🤣  Remy🇨🇳🇷🇺 on Twitter
Remy🇨🇳🇷🇺 on Twitter Inty on Twitter谷爱凌在旧金山大桥前面,假装拿本书,望着太平洋对面中国的方向,意味深长地感叹到:“这些中国人咋就这么好骗呢?”,于是看着美国银行卡里大把中国粉红们的血汗钱,偷着乐呢。😂
Inty on Twitter谷爱凌在旧金山大桥前面,假装拿本书,望着太平洋对面中国的方向,意味深长地感叹到:“这些中国人咋就这么好骗呢?”,于是看着美国银行卡里大把中国粉红们的血汗钱,偷着乐呢。😂 Inty on Twitter郎平此刻也跟全家在“水深火热”的美国旧金山,她的狗看着中国爱国粉红们的留言,正在偷着乐呢。
Inty on Twitter郎平此刻也跟全家在“水深火热”的美国旧金山,她的狗看着中国爱国粉红们的留言,正在偷着乐呢。
 miyukiwei on Twitter谷的目的是去中国捞金名扬四海。中国人民的目的是由她来发泄爱国情绪,自我陶醉的膨胀感得到了一时的快感。但是结局太不相同了,愚民们被割了韭菜还未来得及清醒就彻底躺平在祖国的怀抱,而谷却大刀阔斧、凯旋而归回到美帝的怀抱。
miyukiwei on Twitter谷的目的是去中国捞金名扬四海。中国人民的目的是由她来发泄爱国情绪,自我陶醉的膨胀感得到了一时的快感。但是结局太不相同了,愚民们被割了韭菜还未来得及清醒就彻底躺平在祖国的怀抱,而谷却大刀阔斧、凯旋而归回到美帝的怀抱。 Inty on Twitter中国现代红卫兵
Inty on Twitter中国现代红卫兵 Inty on Twitter上海人无期徒刑,没有减刑的迹象
Inty on Twitter上海人无期徒刑,没有减刑的迹象又上了一层铁皮墙
当之无愧的宇宙墙国
 中国多地饱受新冠疫情之苦,北京关闭几十个地铁站和一百多条公交路线
中国多地饱受新冠疫情之苦,北京关闭几十个地铁站和一百多条公交路线 Inty on Twitter
Inty on Twitter 中国互联网业再现裁员潮 大学生遇“史上最难就业季”
中国互联网业再现裁员潮 大学生遇“史上最难就业季”  朝鲜部署企业白领到全国农村抗旱
朝鲜部署企业白领到全国农村抗旱
05/06
 Inty on Twitter
Inty on Twitter 福奇:中国疫情现在是一场“灾难”
福奇:中国疫情现在是一场“灾难” Inty on Twitter上海被非法封城50多天,2022年05月05日午夜,数以千计的饥饿工人试图从封锁区逃命
Inty on Twitter上海被非法封城50多天,2022年05月05日午夜,数以千计的饥饿工人试图从封锁区逃命
 @davelin - ref 網路上流傳的影片顯示,100多名廣達員工以人數優勢突破穿著防護衣的保全人員...
@davelin - ref 網路上流傳的影片顯示,100多名廣達員工以人數優勢突破穿著防護衣的保全人員... Inty on Twitter
Inty on Twitter 习近平坚持“清零”还不准批评 观察人士:将迎来灾难性结局?
习近平坚持“清零”还不准批评 观察人士:将迎来灾难性结局? Inty on Twitter
中国最发达的城市,上海,几十人一勺一勺的分享一袋子面粉。
Inty on Twitter
中国最发达的城市,上海,几十人一勺一勺的分享一袋子面粉。
不知道的人,还以为俄罗斯侵略了中国呢。
 Inty on Twitter
Inty on Twitter  胡锡进谏言招打脸 习近平清零不回头
胡锡进谏言招打脸 习近平清零不回头
 Inty on Twitter
Inty on Twitter 福奇:中国疫情现在是一场“灾难”
福奇:中国疫情现在是一场“灾难” Inty on Twitter上海被非法封城50多天,2022年05月05日午夜,数以千计的饥饿工人试图从封锁区逃命
Inty on Twitter上海被非法封城50多天,2022年05月05日午夜,数以千计的饥饿工人试图从封锁区逃命 Inty on Twitter
Inty on Twitter 习近平坚持“清零”还不准批评 观察人士:将迎来灾难性结局?
习近平坚持“清零”还不准批评 观察人士:将迎来灾难性结局? Inty on Twitter
中国最发达的城市,上海,几十人一勺一勺的分享一袋子面粉。
Inty on Twitter
中国最发达的城市,上海,几十人一勺一勺的分享一袋子面粉。不知道的人,还以为俄罗斯侵略了中国呢。
 Inty on Twitter
Inty on Twitter  胡锡进谏言招打脸 习近平清零不回头
胡锡进谏言招打脸 习近平清零不回头  Inty on Twitter【#习近平 主持政治局常委会 重申坚持“#动态清零”】并提出要坚决同一切“歪曲、怀疑、否定”中国防疫方针政策的言行“作斗争”。
Inty on Twitter【#习近平 主持政治局常委会 重申坚持“#动态清零”】并提出要坚决同一切“歪曲、怀疑、否定”中国防疫方针政策的言行“作斗争”。 习近平主持政治局常委会 重申坚持“动态清零”
习近平主持政治局常委会 重申坚持“动态清零” Inty on Twitter04/30 长沙医学院,楼房突然坍塌,伤亡情况不明
Inty on Twitter04/30 长沙医学院,楼房突然坍塌,伤亡情况不明 Inty on Twitter05/01 48小时还不救人
Inty on Twitter05/01 48小时还不救人#中国很安全系列
 Inty on Twitter05/06 长沙医学院边上的楼倒塌,已经造成53个中国人死亡
Inty on Twitter05/06 长沙医学院边上的楼倒塌,已经造成53个中国人死亡
 Inty on Twitter五毛粉红曾盗用我在美国凌晨大街上的视频,说是长沙很安全。。。
Inty on Twitter五毛粉红曾盗用我在美国凌晨大街上的视频,说是长沙很安全。。。但是现在,长沙随便一个楼塌下去就死了53个人, 太安全了。
 Inty on Twitter上海的“良民证”又被取消了,继续回家服刑
Inty on Twitter上海的“良民证”又被取消了,继续回家服刑 Inty on Twitter习近平,偷着乐;温州鞋厂要倒闭
Inty on Twitter习近平,偷着乐;温州鞋厂要倒闭 某志🇨🇦🇪🇨🇯🇵🇸🇬Nomad indie game developer on Twitter浙江温州,浙江温州最大皮鞋厂,江南皮鞋厂倒闭了!老板欠下了3.5个亿,带着他的小姨子跑路了!
某志🇨🇦🇪🇨🇯🇵🇸🇬Nomad indie game developer on Twitter浙江温州,浙江温州最大皮鞋厂,江南皮鞋厂倒闭了!老板欠下了3.5个亿,带着他的小姨子跑路了! Inty on Twitter
上海街头的老人,三天三夜没吃没喝;
Inty on Twitter
上海街头的老人,三天三夜没吃没喝;习近平看着偷着乐呢
 Inty on Twitter又抓大量中国假货。
Inty on Twitter又抓大量中国假货。美国海关在旧金山港,缴获了2280件来自中国的假货物品,包括假USB线、适配器等
 Inty on Twitter被封在上海高速的中国难民们,隔着铁丝网要饭吃
Inty on Twitter被封在上海高速的中国难民们,隔着铁丝网要饭吃 中国傻事💙💛 on Twitter长沙塌个楼等于18个南斯拉夫大使馆,没见中国人说血债血偿啊🤔
中国傻事💙💛 on Twitter长沙塌个楼等于18个南斯拉夫大使馆,没见中国人说血债血偿啊🤔 Inty on Twitter上海拍摄视频的人指望老外女帮他们出头
Inty on Twitter上海拍摄视频的人指望老外女帮他们出头 Inty on Twitter
上海人之前敲盆子要饭,成功了。
Inty on Twitter
上海人之前敲盆子要饭,成功了。一个人一碗糊糊和一个馒头
 Inty on Twitter【上海63%的日资制造业处于停工状态】工厂难以复工的主要原因是物流网中断。中国已指定与德国大众等合资的大型国有汽车企业上海汽车集团及美国特斯拉等666家重点企业,推动复工,对日资企业的扶持有限……
Inty on Twitter【上海63%的日资制造业处于停工状态】工厂难以复工的主要原因是物流网中断。中国已指定与德国大众等合资的大型国有汽车企业上海汽车集团及美国特斯拉等666家重点企业,推动复工,对日资企业的扶持有限……https://cn.nikkei.com/.....
 Inty on Twitter【我們找到170位在上海封城去世的人的信息,人們因什麼而逝去?】170位逝者當中,年紀最大的98歲,最小的只有3歲10個月,而 #在已核實身份和有親屬陳述的逝者 中,當中有48人因延誤治療或缺失醫療資源而過世。
Inty on Twitter【我們找到170位在上海封城去世的人的信息,人們因什麼而逝去?】170位逝者當中,年紀最大的98歲,最小的只有3歲10個月,而 #在已核實身份和有親屬陳述的逝者 中,當中有48人因延誤治療或缺失醫療資源而過世。 上海疫情線上紀念館:人們因什麼而逝去?|端傳媒 Initium Media
上海疫情線上紀念館:人們因什麼而逝去?|端傳媒 Initium Media  Inty on Twitter【历史上的今天】
Inty on Twitter【历史上的今天】1882年的5月6日,美国切斯特·阿瑟总统签署了《排中国人的法案》, 禁止来自中国的移民
 Inty on Twitter2022年的今天,很多国家已经开始排俄国人了。
Inty on Twitter2022年的今天,很多国家已经开始排俄国人了。 Inty on Twitter中国排华法案 😂
Inty on Twitter中国排华法案 😂 Inty on Twitter视频里的这个中国人,被强制隔离完成刑期后,回上海住处,不让进。 于是,他给白卫兵磕头。
Inty on Twitter视频里的这个中国人,被强制隔离完成刑期后,回上海住处,不让进。 于是,他给白卫兵磕头。
05/07
 Inty on Twitter北京人被强制隔离,不愿意了,不鸟习近平的清零政策。
Inty on Twitter北京人被强制隔离,不愿意了,不鸟习近平的清零政策。
看来后台很硬啊。🤣
习近平20大之前,应该会斗死所有对他不忠诚的人
 Inty on Twitter网传疑似 #护工殴打老人 的视频,经确认是外滩街道社区卫生服务中心总院住院部患者及护工。被殴老人叫仇某某,今年87岁,已于5月2号去世。
Inty on Twitter网传疑似 #护工殴打老人 的视频,经确认是外滩街道社区卫生服务中心总院住院部患者及护工。被殴老人叫仇某某,今年87岁,已于5月2号去世。 纪念中国疫情非正常死亡民众
纪念中国疫情非正常死亡民众 Inty on Twitter中国最新防疫手段
Inty on Twitter中国最新防疫手段
(警察穿一身防疫裝,用膠帶把民眾捆起來)
 上海解封仍不明朗,北京继续全民核酸测试,全中国防疫如履薄冰
上海解封仍不明朗,北京继续全民核酸测试,全中国防疫如履薄冰
 Inty on Twitter北京人被强制隔离,不愿意了,不鸟习近平的清零政策。
Inty on Twitter北京人被强制隔离,不愿意了,不鸟习近平的清零政策。看来后台很硬啊。🤣
习近平20大之前,应该会斗死所有对他不忠诚的人
 Inty on Twitter网传疑似 #护工殴打老人 的视频,经确认是外滩街道社区卫生服务中心总院住院部患者及护工。被殴老人叫仇某某,今年87岁,已于5月2号去世。
Inty on Twitter网传疑似 #护工殴打老人 的视频,经确认是外滩街道社区卫生服务中心总院住院部患者及护工。被殴老人叫仇某某,今年87岁,已于5月2号去世。 纪念中国疫情非正常死亡民众
纪念中国疫情非正常死亡民众 Inty on Twitter中国最新防疫手段
Inty on Twitter中国最新防疫手段(警察穿一身防疫裝,用膠帶把民眾捆起來)
 上海解封仍不明朗,北京继续全民核酸测试,全中国防疫如履薄冰
上海解封仍不明朗,北京继续全民核酸测试,全中国防疫如履薄冰  Inty on Twitter利用 #健康码、#健康宝 等把人们分成所谓“#红码、#黄码、#绿码”,对持不同码的人群施以不同待遇,#唐靖远 认为,这就是中国历次政治运动中一个必不可少的组成部分,即“#身份政治”:“其实这种模式,就是非常标准的中国监狱的管理模式。”
Inty on Twitter利用 #健康码、#健康宝 等把人们分成所谓“#红码、#黄码、#绿码”,对持不同码的人群施以不同待遇,#唐靖远 认为,这就是中国历次政治运动中一个必不可少的组成部分,即“#身份政治”:“其实这种模式,就是非常标准的中国监狱的管理模式。” 习近平坚持"斗争" 学者:中国防疫走向长期政治化
习近平坚持"斗争" 学者:中国防疫走向长期政治化 Inty on Twitter
Inty on Twitter 中国清零代价有多大?4月贸易数字见分晓
中国清零代价有多大?4月贸易数字见分晓  Inty on Twitter北京欽點前高級警務人員 #李家超 為香港特首「選舉」唯一「候選人」,不僅公然無視香港人抗議警暴的訴求,更突顯中國政府持續剝奪香港人選舉特首的權利。
Inty on Twitter北京欽點前高級警務人員 #李家超 為香港特首「選舉」唯一「候選人」,不僅公然無視香港人抗議警暴的訴求,更突顯中國政府持續剝奪香港人選舉特首的權利。人權觀察 #香港 專頁:香港 | Human Rights Watch
 Inty on Twitter#胡锡进 HuXijin_GT 英文推文:“韩国若与邻国为敌,便是 #乌克兰 的下场”,在 #韩国 引起轩然大波。韩国各大媒体竞相报道。分析人士认为胡的推文在一定程度上代表了中国当局的意思,是中国政府对韩国的一种威胁。
Inty on Twitter#胡锡进 HuXijin_GT 英文推文:“韩国若与邻国为敌,便是 #乌克兰 的下场”,在 #韩国 引起轩然大波。韩国各大媒体竞相报道。分析人士认为胡的推文在一定程度上代表了中国当局的意思,是中国政府对韩国的一种威胁。 胡锡进推文在韩国掀起舆论风暴
胡锡进推文在韩国掀起舆论风暴
中國大外宣
 Inty on Twitter夫拉夫来了,上海人看到以后应该想把他干死吧。😂
Inty on Twitter夫拉夫来了,上海人看到以后应该想把他干死吧。😂
 Inty on Twitter中国防疫新手段:给栅栏喷粪,防止人员外逃
Inty on Twitter中国防疫新手段:给栅栏喷粪,防止人员外逃
 Inty on Twitter中国最新防疫手段,准备用武术吓死病毒
Inty on Twitter中国最新防疫手段,准备用武术吓死病毒
 Inty on Twitter
Inty on Twitter 中国社媒相继公开用户IP属地 “明目张胆” 吓唬国内老百姓
中国社媒相继公开用户IP属地 “明目张胆” 吓唬国内老百姓
 Inty on Twitter夫拉夫来了,上海人看到以后应该想把他干死吧。😂
Inty on Twitter夫拉夫来了,上海人看到以后应该想把他干死吧。😂 Inty on Twitter中国防疫新手段:给栅栏喷粪,防止人员外逃
Inty on Twitter中国防疫新手段:给栅栏喷粪,防止人员外逃 Inty on Twitter中国最新防疫手段,准备用武术吓死病毒
Inty on Twitter中国最新防疫手段,准备用武术吓死病毒 Inty on Twitter
Inty on Twitter 中国社媒相继公开用户IP属地 “明目张胆” 吓唬国内老百姓
中国社媒相继公开用户IP属地 “明目张胆” 吓唬国内老百姓  Inty on Twitter上海高考,中考统统延期。
Inty on Twitter上海高考,中考统统延期。 这应该是大陆文化大革命后的第一次吧。
 Inty on Twitter说实话,在中国上大学就是浪费生命,时间,金钱。
Inty on Twitter说实话,在中国上大学就是浪费生命,时间,金钱。还不如现在自己找个培训班学学IT、学习外语,早点润
 Inty on Twitter但是,现在应该很难了,中国人现在连自己的小区都很难出去,更不要说出国了。 如果你没有出小区的勇气,出国应该会更困难
Inty on Twitter但是,现在应该很难了,中国人现在连自己的小区都很难出去,更不要说出国了。 如果你没有出小区的勇气,出国应该会更困难 Inty on Twitter中国领导孩子都去美国,加拿大,欧洲。但韭菜们的孩子争先恐后地愿为国牺牲。😂
Inty on Twitter中国领导孩子都去美国,加拿大,欧洲。但韭菜们的孩子争先恐后地愿为国牺牲。😂
 Inty on Twitter上海防疫,军民鱼水情
Inty on Twitter上海防疫,军民鱼水情 Inty on Twitter这是中国,不是美国。我们想绑架你就绑架你。
Inty on Twitter这是中国,不是美国。我们想绑架你就绑架你。 Inty on Twitter有人讽刺道,“今天还是 #马克思诞辰,放《#国际歌》怎么不对了?社会主义国家还不能放国际歌了?”
Inty on Twitter有人讽刺道,“今天还是 #马克思诞辰,放《#国际歌》怎么不对了?社会主义国家还不能放国际歌了?”#上海封控
 上海封控 民众播放《国际歌》遭警方登门传唤
上海封控 民众播放《国际歌》遭警方登门传唤
0508
 Inty on Twitter很有特色
Inty on Twitter很有特色

 Inty on Twitter中国防疫新手段,给房顶灭毒
Inty on Twitter中国防疫新手段,给房顶灭毒
 Inty on Twitter中国在上海複製新疆监控模式
Inty on Twitter中国在上海複製新疆监控模式
 China News on Twitter
China News on Twitter Inty on Twitter据美国民间宗教权益组织“对华援助协会”5月6日发布的消息,广东基督徒颜志鸿因翻译有关上海封城的抗议言论遭当局抓捕后,深圳一家教会就此发起为期一周的接力禁食祷告活动。
Inty on Twitter据美国民间宗教权益组织“对华援助协会”5月6日发布的消息,广东基督徒颜志鸿因翻译有关上海封城的抗议言论遭当局抓捕后,深圳一家教会就此发起为期一周的接力禁食祷告活动。  深圳基督徒翻译抗议封城言论被抓 教会发起接力祷告活动
深圳基督徒翻译抗议封城言论被抓 教会发起接力祷告活动
 Inty on Twitter很有特色
Inty on Twitter很有特色 Inty on Twitter中国防疫新手段,给房顶灭毒
Inty on Twitter中国防疫新手段,给房顶灭毒 Inty on Twitter中国在上海複製新疆监控模式
Inty on Twitter中国在上海複製新疆监控模式 China News on Twitter
China News on Twitter Inty on Twitter据美国民间宗教权益组织“对华援助协会”5月6日发布的消息,广东基督徒颜志鸿因翻译有关上海封城的抗议言论遭当局抓捕后,深圳一家教会就此发起为期一周的接力禁食祷告活动。
Inty on Twitter据美国民间宗教权益组织“对华援助协会”5月6日发布的消息,广东基督徒颜志鸿因翻译有关上海封城的抗议言论遭当局抓捕后,深圳一家教会就此发起为期一周的接力禁食祷告活动。  深圳基督徒翻译抗议封城言论被抓 教会发起接力祷告活动
深圳基督徒翻译抗议封城言论被抓 教会发起接力祷告活动  Inty on Twitter中国又发明什么新的防疫手段? 红旗巫术?
Inty on Twitter中国又发明什么新的防疫手段? 红旗巫术? Inty on Twitter中国制作视频,为美国的饥饿儿童筹集资金。
Inty on Twitter中国制作视频,为美国的饥饿儿童筹集资金。 Inty on Twitter
Inty on Twitter 中国民间发起寻找“坍塌的53个名字” 抗议官媒冷漠
中国民间发起寻找“坍塌的53个名字” 抗议官媒冷漠
05/09
在路邊直接生產,中共不愧為口國,超狂的螂性
 Inty on Twitter中国習近平清零政策,让中國人的孩子生在马路上
Inty on Twitter中国習近平清零政策,让中國人的孩子生在马路上
 Inty on Twitter北京革命群众勇斗中共白卫兵
Inty on Twitter北京革命群众勇斗中共白卫兵
 对奥密克戎效力差 中国疫苗出口断崖式暴跌
对奥密克戎效力差 中国疫苗出口断崖式暴跌 科興被爆扣壓360億元年終不發 先大規模裁掉7成員工 | 蘋果新聞網 | 蘋果日報
科興被爆扣壓360億元年終不發 先大規模裁掉7成員工 | 蘋果新聞網 | 蘋果日報 @liuchienyi - 不愧是中國...狼性... 外銷量跌掉97%
@liuchienyi - 不愧是中國...狼性... 外銷量跌掉97% @wbsearch404 - 【我当然要维护习近平的加速倒车了,要不然谁来踩油门把共产党开下悬崖?都什么...
@wbsearch404 - 【我当然要维护习近平的加速倒车了,要不然谁来踩油门把共产党开下悬崖?都什么...
在路邊直接生產,中共不愧為口國,超狂的螂性
 Inty on Twitter中国習近平清零政策,让中國人的孩子生在马路上
Inty on Twitter中国習近平清零政策,让中國人的孩子生在马路上 Inty on Twitter北京革命群众勇斗中共白卫兵
Inty on Twitter北京革命群众勇斗中共白卫兵 对奥密克戎效力差 中国疫苗出口断崖式暴跌
对奥密克戎效力差 中国疫苗出口断崖式暴跌 科興被爆扣壓360億元年終不發 先大規模裁掉7成員工 | 蘋果新聞網 | 蘋果日報
科興被爆扣壓360億元年終不發 先大規模裁掉7成員工 | 蘋果新聞網 | 蘋果日報 Inty on Twitter这个也惨。德国纳粹一样。 上海人也跟维吾尔人一样的待遇了
Inty on Twitter这个也惨。德国纳粹一样。 上海人也跟维吾尔人一样的待遇了 Inty on Twitter【母亲节上海一对母子被强制分离】
Inty on Twitter【母亲节上海一对母子被强制分离】上周习近平下军令状要贯彻清零防疫政策后 ,各地方政府随即采取强硬措施。在上海一个小区,就看到这叫人心酸的一幕,防疫人员强行把一对母子分开,抓母亲去隔离。
网民提供视频
 Inty on Twitter北京第二外国语学院,师生聚集抗议中共的反人类封锁校园!于是大批警察出动,把师生们吓退了
Inty on Twitter北京第二外国语学院,师生聚集抗议中共的反人类封锁校园!于是大批警察出动,把师生们吓退了 Inty on Twitter上海的美丽风景线。
Inty on Twitter上海的美丽风景线。
 Inty on Twitter【社民連早上遊行抗議小圈子選舉 主席陳寶瑩:「安排在公廁門外,是對抗爭者的最大侮辱」】
Inty on Twitter【社民連早上遊行抗議小圈子選舉 主席陳寶瑩:「安排在公廁門外,是對抗爭者的最大侮辱」】香港行政長官選舉今日(8日)舉行,前政務司司長李家超是唯一的參選人。社會民主連線(社民連)今早發起遊行,抗議今次是1500位特權人士的小圈選舉。 (转自initiumnews)
 Inty on Twitter中国白卫兵打中国人打得很狠哈。
Inty on Twitter中国白卫兵打中国人打得很狠哈。 Inty on Twitter此图无需配文。 (转自SpeechFreedomCN)
Inty on Twitter此图无需配文。 (转自SpeechFreedomCN) Inty on Twitter中国4月出口降至两年来的最低点
Inty on Twitter中国4月出口降至两年来的最低点 Inty on Twitter中国4月末外汇储备为3.1197万亿美元,环比减少682.74亿美元。这是外汇储备连续第四个月下降,且降幅较前值进一步扩大,也弱于预期。
Inty on Twitter中国4月末外汇储备为3.1197万亿美元,环比减少682.74亿美元。这是外汇储备连续第四个月下降,且降幅较前值进一步扩大,也弱于预期。 中国外汇储备连降四个月,且降幅扩大
中国外汇储备连降四个月,且降幅扩大 Inty on Twitter莫斯科的传统阅兵式,空中飞机表演(今天承诺在天空中画上Z字)被臨時取消。 理由:天气不行。
Inty on Twitter莫斯科的传统阅兵式,空中飞机表演(今天承诺在天空中画上Z字)被臨時取消。 理由:天气不行。但是现场蓝天白云
 Inty on Twitter普京结束演讲,没有任何重大宣布。战争仍在继续。
Inty on Twitter普京结束演讲,没有任何重大宣布。战争仍在继续。还是老生常谈,倒打一耙乌克兰和“美国为首的西方反俄势力”
 若醫療不堪負荷 黃珊珊:木柵機廠將轉型為「野戰醫院」 | 聯合新聞網
若醫療不堪負荷 黃珊珊:木柵機廠將轉型為「野戰醫院」 | 聯合新聞網 河北保定教区地下教会至少十名神父遭强迫失踪
河北保定教区地下教会至少十名神父遭强迫失踪 Inty on Twitter今日中国,白卫兵和人民
Inty on Twitter今日中国,白卫兵和人民 Inty on Twitter“紧急状态”是一种法律状态,必须经有权机关依宪法宣布才出现或存在,“绝对不是任何机构或官员可以随意认定和信口开河宣告的”。
Inty on Twitter“紧急状态”是一种法律状态,必须经有权机关依宪法宣布才出现或存在,“绝对不是任何机构或官员可以随意认定和信口开河宣告的”。#刘大力 #童之伟 #上海封城 #转运 #清零
 上海法律界人士发文质疑防疫手法 账号被封 文章禁转
上海法律界人士发文质疑防疫手法 账号被封 文章禁转
05/10 黨的鐵拳終於打下來了,韭菜們一定很開心
 @davelin - ref 自4月以來,上海的2500萬居民在全市範圍內的嚴格封鎖中淺嘗了新疆的待遇。...
@davelin - ref 自4月以來,上海的2500萬居民在全市範圍內的嚴格封鎖中淺嘗了新疆的待遇。... @lunajill - 「上海封城與新疆鎮壓最顯著的相似之處之一是當局使用的政治口號。在新疆,用於拘禁大...
@lunajill - 「上海封城與新疆鎮壓最顯著的相似之處之一是當局使用的政治口號。在新疆,用於拘禁大... @davelin - ref 在中國,當局加大了管控力度,對確診病例和密接者進行嚴格封鎖、大規模檢測和集...
@davelin - ref 在中國,當局加大了管控力度,對確診病例和密接者進行嚴格封鎖、大規模檢測和集... 台湾学者解读:习近平的话证实中国疫苗没用
台湾学者解读:习近平的话证实中国疫苗没用 Inty on Twitter#上海 居民陈先生:“天天做 #核酸 ,做一次发现几例,天天筛查,天天有(阳性),我说是不是非要把阴性做成阳性,你们才甘心。现在又搞连坐,很多人反抗。我说以后抓了一个贪官,那就把办公市所有领导都抓起来”
Inty on Twitter#上海 居民陈先生:“天天做 #核酸 ,做一次发现几例,天天筛查,天天有(阳性),我说是不是非要把阴性做成阳性,你们才甘心。现在又搞连坐,很多人反抗。我说以后抓了一个贪官,那就把办公市所有领导都抓起来” 上海实施"一人阳性、全楼拉走" 有地方政府强征民居做隔离点被拒
上海实施"一人阳性、全楼拉走" 有地方政府强征民居做隔离点被拒 中国动态清零政策面临骑虎难下局面
中国动态清零政策面临骑虎难下局面
 台湾学者解读:习近平的话证实中国疫苗没用
台湾学者解读:习近平的话证实中国疫苗没用 Inty on Twitter#上海 居民陈先生:“天天做 #核酸 ,做一次发现几例,天天筛查,天天有(阳性),我说是不是非要把阴性做成阳性,你们才甘心。现在又搞连坐,很多人反抗。我说以后抓了一个贪官,那就把办公市所有领导都抓起来”
Inty on Twitter#上海 居民陈先生:“天天做 #核酸 ,做一次发现几例,天天筛查,天天有(阳性),我说是不是非要把阴性做成阳性,你们才甘心。现在又搞连坐,很多人反抗。我说以后抓了一个贪官,那就把办公市所有领导都抓起来” 上海实施"一人阳性、全楼拉走" 有地方政府强征民居做隔离点被拒
上海实施"一人阳性、全楼拉走" 有地方政府强征民居做隔离点被拒 中国动态清零政策面临骑虎难下局面
中国动态清零政策面临骑虎难下局面  Inty on Twitter5月8日,上海市闵行区颛桥镇居民因讨要物资与“大白”发生肢体冲突。有关视频显示,现场乱作一团,有居民高喊“打人啦”。官方随后发布通报称,带头滋事人员已被传唤,警方拟对其采取刑事强制措施,案件正在进一步审理。
Inty on Twitter5月8日,上海市闵行区颛桥镇居民因讨要物资与“大白”发生肢体冲突。有关视频显示,现场乱作一团,有居民高喊“打人啦”。官方随后发布通报称,带头滋事人员已被传唤,警方拟对其采取刑事强制措施,案件正在进一步审理。 Inty on Twitter【自杀式清零为哪般?| " #动物庄园 "动画剧场】
Inty on Twitter【自杀式清零为哪般?| " #动物庄园 "动画剧场】为 #清零 在全国那么多地区停工停产,造成经济下滑、民生受创,这一番自杀式折腾,究竟是为哪般呢?
#上海封控 #硬性隔离 #方舱 #核酸 #动态清零 #静态管理 #封城 #社会面清零 #抢菜 #转运 #复工
 Inty on Twitter王峭岭:“2020年开始 #封城 ,先封的不是武汉吗?封到现在还在封城、现在不仅封城了,把人家楼门都焊上了。我们现在眼见比2020年武汉的时候还严重。我觉得肯定哪出问题了。脑子进水了吧?” #北京疫情
Inty on Twitter王峭岭:“2020年开始 #封城 ,先封的不是武汉吗?封到现在还在封城、现在不仅封城了,把人家楼门都焊上了。我们现在眼见比2020年武汉的时候还严重。我觉得肯定哪出问题了。脑子进水了吧?” #北京疫情  疫情升温下北京朝阳住宅遭封门 居民谴责当局可耻
疫情升温下北京朝阳住宅遭封门 居民谴责当局可耻 Inty on Twitter中国白卫兵也没饭吃了……
Inty on Twitter中国白卫兵也没饭吃了…… 中聯辦見李家超 分析:北京對香港將有更多指導 | 兩岸 | 中央社 CNA
中聯辦見李家超 分析:北京對香港將有更多指導 | 兩岸 | 中央社 CNA 孫春蘭:堅持動態清零 為中共20大營造良好環境 | 兩岸 | 中央社 CNA
孫春蘭:堅持動態清零 為中共20大營造良好環境 | 兩岸 | 中央社 CNA 陸克文:中國清零損經濟 可能走基建投資回頭路 | 兩岸 | 中央社 CNA
陸克文:中國清零損經濟 可能走基建投資回頭路 | 兩岸 | 中央社 CNA 香港反送中餘波 激進組織6人被捕 | 兩岸 | 中央社 CNA
香港反送中餘波 激進組織6人被捕 | 兩岸 | 中央社 CNA 中国权威学者批强送方舱擅闯民宅违宪 个人微博遭清零
中国权威学者批强送方舱擅闯民宅违宪 个人微博遭清零  上海疫情清零壓力大 28日起分區封控 | 兩岸 | 中央社 CNA
上海疫情清零壓力大 28日起分區封控 | 兩岸 | 中央社 CNA 塔利班禁播美国之音和英国广播公司的新闻节目
塔利班禁播美国之音和英国广播公司的新闻节目 上海封城!今晨5點突襲式封控 台積電、合晶回應上海廠現況 | 蘋果新聞網 | 蘋果日報
上海封城!今晨5點突襲式封控 台積電、合晶回應上海廠現況 | 蘋果新聞網 | 蘋果日報 上海明日凌晨五點封城 台積電:目前不影響上海廠生產 | 產業熱點 | 產業 | 經濟日報
上海明日凌晨五點封城 台積電:目前不影響上海廠生產 | 產業熱點 | 產業 | 經濟日報 上海封了
上海封了 「台灣表妹」揭回台原因 反轟:台灣人愛編故事、玻璃心 - 民視新聞網
「台灣表妹」揭回台原因 反轟:台灣人愛編故事、玻璃心 - 民視新聞網 中國疫情加劇!黃智賢不舔中了 悄回台灣被酸爆 - 自由娛樂
中國疫情加劇!黃智賢不舔中了 悄回台灣被酸爆 - 自由娛樂 【認知作戰攻台1】捧中撤僑「台灣小伙」原是中國網紅 人根本在東莞
【認知作戰攻台1】捧中撤僑「台灣小伙」原是中國網紅 人根本在東莞 Inty on Twitter
Inty on Twitter Inty on Twitter
Inty on Twitter Inty on Twitter
Inty on Twitter 上海封城进入第二天 当局收紧封控措施导致民怨沸腾
上海封城进入第二天 当局收紧封控措施导致民怨沸腾 中国网络观察:上海封城再破世界记录
中国网络观察:上海封城再破世界记录 吉林方舱医院民工讨薪不果遭警方弹压 被要求自费隔离
吉林方舱医院民工讨薪不果遭警方弹压 被要求自费隔离 「上海是中國的一部分」 防疫轉硬帶來痛徹領悟 | 兩岸 | 中央社 CNA
「上海是中國的一部分」 防疫轉硬帶來痛徹領悟 | 兩岸 | 中央社 CNA 中國本土與無症狀單日破8000例 分區封控止不住疫情 | 兩岸 | 中央社 CNA
中國本土與無症狀單日破8000例 分區封控止不住疫情 | 兩岸 | 中央社 CNA Inty on Twitter
Inty on Twitter Inty on Twitter
Inty on Twitter 瑞士飞上海航班起飞前临时取消 逾两百回国乘客滞留机场叫苦连天
瑞士飞上海航班起飞前临时取消 逾两百回国乘客滞留机场叫苦连天 慘劇正在發生!上海封城醫院護士上網求救:我們走投無路了 - 國際 - 自由時報電子報
慘劇正在發生!上海封城醫院護士上網求救:我們走投無路了 - 國際 - 自由時報電子報 上海封城进入第三天 感染人数继续飙升 浦西部分地区提前封控
上海封城进入第三天 感染人数继续飙升 浦西部分地区提前封控 Inty on Twitter
Inty on Twitter James Hsieh on Twitter
James Hsieh on Twitter 3月29日,上海閔行區,有小區居民聚集在小區公眾範圍叫口號, 「我們要吃飯、我們要上班、我們要自由。」(...
3月29日,上海閔行區,有小區居民聚集在小區公眾範圍叫口號, 「我們要吃飯、我們要上班、我們要自由。」(... 離開上海須持這2證明 浦西今起封控
離開上海須持這2證明 浦西今起封控 Chris 𓃠 on Twitter
Chris 𓃠 on Twitter 谢万军 Wanjun Xie on Twitter
谢万军 Wanjun Xie on Twitter 【公子時評】上海乱象频生,市民求助无门!你被“全局静态管理“了吗?上海宣布进口疫苗特效药,国产神话终破灭...
【公子時評】上海乱象频生,市民求助无门!你被“全局静态管理“了吗?上海宣布进口疫苗特效药,国产神话终破灭... Inty on Twitter
Inty on Twitter 中國新增近萬本土病例 上海占三分之二 | 兩岸 | 中央社 CNA
中國新增近萬本土病例 上海占三分之二 | 兩岸 | 中央社 CNA 上海無症狀感者眾多 是否放寬居家隔離成焦點 | 兩岸 | 中央社 CNA
上海無症狀感者眾多 是否放寬居家隔離成焦點 | 兩岸 | 中央社 CNA 上海新增8226例確診 3月疫情爆發以來最高 | 兩岸 | 中央社 CNA
上海新增8226例確診 3月疫情爆發以來最高 | 兩岸 | 中央社 CNA 中國單日確診數首度破萬 疫情爆發清零陷考驗 | 兩岸 | 中央社 CNA
中國單日確診數首度破萬 疫情爆發清零陷考驗 | 兩岸 | 中央社 CNA 将核酸检测阳性幼儿与父母分开隔离,上海极端防疫措施惹民怨
将核酸检测阳性幼儿与父母分开隔离,上海极端防疫措施惹民怨 Inty on Twitter
Inty on Twitter 法驻沪总领事馆:不要因防疫将父母和孩子分开
法驻沪总领事馆:不要因防疫将父母和孩子分开 Inty on Twitter
Inty on Twitter Inty on Twitter
Inty on Twitter 歐盟駐上海領事館抓狂!致函上海政府6大要求全曝光 - 自由財經
歐盟駐上海領事館抓狂!致函上海政府6大要求全曝光 - 自由財經 中國上海疫情亂象 傳嬰幼兒遭帶走隔離無人換尿布「屁股爛掉」 - 國際 - 自由時報電子報
中國上海疫情亂象 傳嬰幼兒遭帶走隔離無人換尿布「屁股爛掉」 - 國際 - 自由時報電子報 Inty on Twitter
Inty on Twitter Inty on Twitter
Inty on Twitter shinto_student on Twitter
shinto_student on Twitter Inty on Twitter
Inty on Twitter 中国疫情今报单日破万
中国疫情今报单日破万 苏州惊现Omicron全新变种病毒 与全球不同源
苏州惊现Omicron全新变种病毒 与全球不同源 上海疫情冲击中国经济引擎 分析称习辗“上海帮”
上海疫情冲击中国经济引擎 分析称习辗“上海帮” Inty on Twitter
Inty on Twitter 上海继续封城政府要求全民在家自检 疫情尚未控制苏州又现奥密克戎新变种
上海继续封城政府要求全民在家自检 疫情尚未控制苏州又现奥密克戎新变种 Inty on Twitter
Inty on Twitter 一只发布COVID-19安全指令的机器狗正在封锁的上海街头游荡 - 头条趋势
一只发布COVID-19安全指令的机器狗正在封锁的上海街头游荡 - 头条趋势 一顆橘子85塊!上海「封城」闢謠平台惹怒中國網友|小粉紅:抖音可以防疫|中國一刀切政策
一顆橘子85塊!上海「封城」闢謠平台惹怒中國網友|小粉紅:抖音可以防疫|中國一刀切政策 Inty on Twitter
Inty on Twitter Inty on Twitter
Inty on Twitter 苏州惊现全新奥密克戎变种 全球数据库中首见
苏州惊现全新奥密克戎变种 全球数据库中首见 解放军医疗队进入上海 继续封城民怨沸腾 专家:疫情变成政治病
解放军医疗队进入上海 继续封城民怨沸腾 专家:疫情变成政治病 墨亚 on Twitter
墨亚 on Twitter 中国研究生反对学校过度防疫 遭开除
中国研究生反对学校过度防疫 遭开除 英法等三十国敦促中国勿将染疫侨民婴幼儿与父母分开
英法等三十国敦促中国勿将染疫侨民婴幼儿与父母分开 上海进行大规模核酸检测 北京派遣军队支持
上海进行大规模核酸检测 北京派遣军队支持 中国网络观察:“一尊”与防疫不惜一切代价
中国网络观察:“一尊”与防疫不惜一切代价 上海感染病例破万,疫情“极其严峻”,全市封城延长
上海感染病例破万,疫情“极其严峻”,全市封城延长 习近平何以不惜巨大代价清零
习近平何以不惜巨大代价清零 【一線採訪】上海方艙混亂 搶物資畫面曝光 - 大紀元
【一線採訪】上海方艙混亂 搶物資畫面曝光 - 大紀元 4/6 上海封城太荒謬,這不是天災,這是人禍
4/6 上海封城太荒謬,這不是天災,這是人禍 重灾区上海疫情再创新高 清零渺茫但却不肯掉头
重灾区上海疫情再创新高 清零渺茫但却不肯掉头 Inty on Twitter
Inty on Twitter 人权观察呼吁中国在疫情封控期间尊重民众获取治疗及必需品的基本人权
人权观察呼吁中国在疫情封控期间尊重民众获取治疗及必需品的基本人权 上海飼主被隔離柯基急追車 才5分鐘遭打死居民目睹心碎 | ETtoday寵物動物新聞 | ETtoday...
上海飼主被隔離柯基急追車 才5分鐘遭打死居民目睹心碎 | ETtoday寵物動物新聞 | ETtoday... Inty on Twitter
Inty on Twitter Inty on Twitter
Inty on Twitter 中国单日新增阳性超2万 上海设4万床位巨型方舱
中国单日新增阳性超2万 上海设4万床位巨型方舱 Inty on Twitter
Inty on Twitter 上海大封控下的地方官员处境 是消极躺平还是唯命是从?
上海大封控下的地方官员处境 是消极躺平还是唯命是从? Inty on Twitter
Inty on Twitter Steve Hanke on Twitter
Steve Hanke on Twitter Inty on Twitter
Inty on Twitter 上海坚持严格清零 封城拖延恐重创全球供应链
上海坚持严格清零 封城拖延恐重创全球供应链 上海刚辟谣“武警接管” 多个小区传出军管消息
上海刚辟谣“武警接管” 多个小区传出军管消息 中國疫情多點爆發 多城突封高速公路出入口引怒火 - 國際 - 自由時報電子報
中國疫情多點爆發 多城突封高速公路出入口引怒火 - 國際 - 自由時報電子報 Inty on Twitter
Inty on Twitter Inty on Twitter
Inty on Twitter 美国授权驻上海领事馆外交官可自愿离开
美国授权驻上海领事馆外交官可自愿离开 民怨沸腾 上海拟分区松绑封控
民怨沸腾 上海拟分区松绑封控 中國單日增逾2.7萬例續測峰值 廣州民眾11日起非必要不得離城 | 兩岸 | 中央社 CNA
中國單日增逾2.7萬例續測峰值 廣州民眾11日起非必要不得離城 | 兩岸 | 中央社 CNA 当千亿美元换不来一片口罩,台独不爱人命爱狗命?|多维新闻|台湾
当千亿美元换不来一片口罩,台独不爱人命爱狗命?|多维新闻|台湾 上海封城!網紅「饑荒瘦身」1黃瓜吃2天 10天對比驚人 | 娛樂星聞 | 三立新聞網 SETN.COM
上海封城!網紅「饑荒瘦身」1黃瓜吃2天 10天對比驚人 | 娛樂星聞 | 三立新聞網 SETN.COM 劉樂妍出事了! 遭銀行終止交易「付不了房租」最嚴重怕驅逐出境 | ETtoday星光雲 | ETtoda...
劉樂妍出事了! 遭銀行終止交易「付不了房租」最嚴重怕驅逐出境 | ETtoday星光雲 | ETtoda... 陳浩民妻吐槽上海封控生活:兩斤菜花逾千元 - 大紀元
陳浩民妻吐槽上海封控生活:兩斤菜花逾千元 - 大紀元 中国数字时代 on Twitter
中国数字时代 on Twitter Inty on Twitter
Inty on Twitter Inty on Twitter
Inty on Twitter 李立群封城驚爆「孩子已在餓肚子」 3天改口:少吃一頓對人還是好的 | 蘋果新聞網 | 蘋果日報
李立群封城驚爆「孩子已在餓肚子」 3天改口:少吃一頓對人還是好的 | 蘋果新聞網 | 蘋果日報 上海高官視察「演砸了」!遭阿嬤亂入嗆爆畫面瘋傳 - 國際 - 自由時報電子報
上海高官視察「演砸了」!遭阿嬤亂入嗆爆畫面瘋傳 - 國際 - 自由時報電子報 上海單日增2.7萬本土病例 防疫壓力大官員自盡 | 兩岸 | 中央社 CNA
上海單日增2.7萬本土病例 防疫壓力大官員自盡 | 兩岸 | 中央社 CNA Wenhao on Twitter
Wenhao on Twitter 央視帶風向翻車!微博批美人權赤字變熱搜 中網友反串文洗版 - 國際 - 自由時報電子報
央視帶風向翻車!微博批美人權赤字變熱搜 中網友反串文洗版 - 國際 - 自由時報電子報 開錯玩笑了!PlayStation中國疑揶揄上海封城 微博被灌爆 - 國際 - 自由時報電子報
開錯玩笑了!PlayStation中國疑揶揄上海封城 微博被灌爆 - 國際 - 自由時報電子報 烙屎也得等!上海名校遭曝「防疫新標準」:拉屎要預約也不准洗手 | ETtoday大陸新聞 | ETtod...
烙屎也得等!上海名校遭曝「防疫新標準」:拉屎要預約也不准洗手 | ETtoday大陸新聞 | ETtod... 头条趋势 on Twitter
头条趋势 on Twitter 在艰难的COVID-19封锁和限制中,中国的移民咨询激增 - 头条趋势
在艰难的COVID-19封锁和限制中,中国的移民咨询激增 - 头条趋势 上海封城斷糧!市民餓到路邊挖草吃 全場忍笑:好險沒統一 | 生活 | 三立新聞網 SETN.COM
上海封城斷糧!市民餓到路邊挖草吃 全場忍笑:好險沒統一 | 生活 | 三立新聞網 SETN.COM 緊鄰上海防疫壓力大 蘇州宣布多區採封閉式管理 | 兩岸 | 中央社 CNA
緊鄰上海防疫壓力大 蘇州宣布多區採封閉式管理 | 兩岸 | 中央社 CNA Inty on Twitter
Inty on Twitter 小M on Twitter
小M on Twitter Inty on Twitter
Inty on Twitter 批「清零」消音:专家钟南山、人大学者刘小兵文章被屏蔽
批「清零」消音:专家钟南山、人大学者刘小兵文章被屏蔽 强硬清零误春耕 缺种缺肥陷困境 中国恐现粮荒?
强硬清零误春耕 缺种缺肥陷困境 中国恐现粮荒? 连花清瘟遭捧可抗疫 专家警告伤肾胃
连花清瘟遭捧可抗疫 专家警告伤肾胃 中国经济景气不佳就业难 千万高校毕业生恐成“新贫一族”
中国经济景气不佳就业难 千万高校毕业生恐成“新贫一族” 上海有人唱国歌宣泄对封城不满 官方径直封禁“起来”词
上海有人唱国歌宣泄对封城不满 官方径直封禁“起来”词 上海副市长视察居民疫况被疑假模假样
上海副市长视察居民疫况被疑假模假样 上海副市长视察民居 冰箱塞满食物遭质疑
上海副市长视察民居 冰箱塞满食物遭质疑 Inty on Twitter
Inty on Twitter “掩耳到0“如期光临上海两外企区 可优先复工企业却宁愿躺平
“掩耳到0“如期光临上海两外企区 可优先复工企业却宁愿躺平 封控下上海:民间拜起“跑路天后”张爱玲
封控下上海:民间拜起“跑路天后”张爱玲 長平:「跑路天后」張愛玲的飢餓故事
長平:「跑路天后」張愛玲的飢餓故事 中国经济问题重重 为何官方统计数字一片繁荣?
中国经济问题重重 为何官方统计数字一片繁荣? 章立凡 Zhang Lifan on Twitter
章立凡 Zhang Lifan on Twitter Inty on Twitter
Inty on Twitter Inty on Twitter
Inty on Twitter 北京疫情再起 当局称形势严峻
北京疫情再起 当局称形势严峻 Inty on Twitter
Inty on Twitter Inty on Twitter
Inty on Twitter Inty on Twitter
Inty on Twitter Inty on Twitter
Inty on Twitter Inty on Twitter
Inty on Twitter 美国要求中国当局让藏人选择的第11世班禅喇嘛获得自由
美国要求中国当局让藏人选择的第11世班禅喇嘛获得自由 推特上的中国:《四月之声》唤醒中国人?
推特上的中国:《四月之声》唤醒中国人? Inty on Twitter
Inty on Twitter Inty on Twitter
Inty on Twitter “小骂大帮忙” 亲北京的多维新闻为何突然停运
“小骂大帮忙” 亲北京的多维新闻为何突然停运 【貓咪大戰爭】6週年電視廣告
【貓咪大戰爭】6週年電視廣告 20大前夕中国网络清零异见 着手批“历史虚无主义”
20大前夕中国网络清零异见 着手批“历史虚无主义” Inty on Twitter
Inty on Twitter Inty on Twitter
Inty on Twitter Inty on Twitter
Inty on Twitter Inty on Twitter
Inty on Twitter 中国紧急救经济:4天4场高层会
中国紧急救经济:4天4场高层会 Inty on Twitter
Inty on Twitter